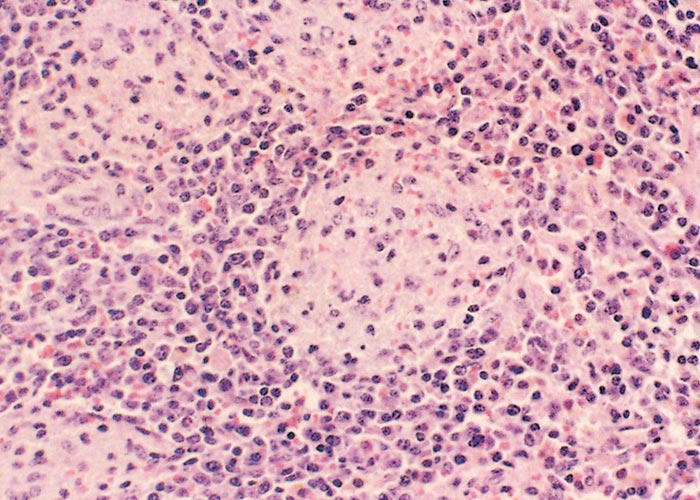
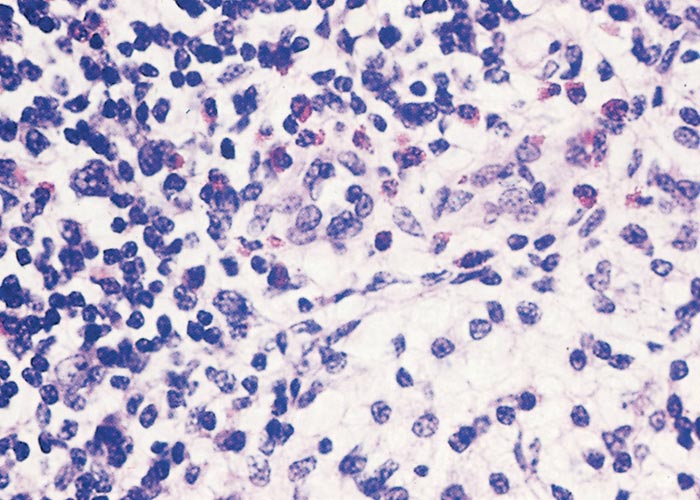

- Infectious Diseases of Livestock
- Part 2
- African swine fever
- GENERAL INTRODUCTION: PARAMYXOVIRIDAE AND PNEUMOVIRIDAE
- Rinderpest
- Peste des petits ruminants
- Parainfluenza type 3 infection
- Bovine respiratory syncytial virus infection
- Hendra virus infection
- Paramyxovirus-induced reproductive failure and congenital defects in pigs
- Nipah virus disease
- GENERAL INTRODUCTION: CALICIVIRIDAE AND ASTROVIRIDAE
- Vesicular exanthema
- Enteric caliciviruses of pigs and cattle
- GENERAL INTRODUCTION: RETROVIRIDAE
- Enzootic bovine leukosis
- Jaagsiekte
- Visna-maedi
- Caprine arthritis-encephalitis
- Equine infectious anaemia
- GENERAL INTRODUCTION: PAPILLOMAVIRIDAE
- Papillomavirus infection of ruminants
- Papillomavirus infection of equids
- GENERAL INTRODUCTION: ORTHOMYXOVIRIDAE
- Equine influenza
- Swine influenza
- GENERAL INTRODUCTION: CORONAVIRIDAE
- Porcine transmissible gastroenteritis
- Porcine respiratory coronavirus infection
- Porcine epidemic diarrhoea
- Porcine haemagglutinating encephalomyelitis virus infection
- Porcine deltacoronavirus infection
- Bovine coronavirus infection
- Ovine coronavirus infection
- Equine coronavirus infection
- GENERAL INTRODUCTION: PARVOVIRIDAE
- Porcine parvovirus infection
- Bovine parvovirus infection
- GENERAL INTRODUCTION: ADENOVIRIDAE
- Adenovirus infections
- GENERAL INTRODUCTION: HERPESVIRIDAE
- Equid herpesvirus 1 and equid herpesvirus 4 infections
- Equid gammaherpesvirus 2 and equid gammaherpesvirus 5 infections
- Equine coital exanthema
- Infectious bovine rhinotracheitis/infectious pustular vulvovaginitis and infectious pustular balanoposthitis
- Bovine alphaherpesvirus 2 infections
- Malignant catarrhal fever
- Pseudorabies
- Suid herpesvirus 2 infection
- GENERAL INTRODUCTION: ARTERIVIRIDAE
- Equine viral arteritis
- Porcine reproductive and respiratory syndrome
- GENERAL INTRODUCTION: FLAVIVIRIDAE
- Bovine viral diarrhoea and mucosal disease
- Border disease
- Hog cholera
- Wesselsbron disease
- Louping ill
- West nile virus infection
- GENERAL INTRODUCTION: TOGAVIRIDAE
- Equine encephalitides caused by alphaviruses in the Western Hemisphere
- Old World alphavirus infections in animals
- Getah virus infection
- GENERAL INTRODUCTION: BUNYAVIRIDAE
- Diseases caused by Akabane and related Simbu-group viruses
- Rift Valley fever
- Nairobi sheep disease
- Crimean-Congo haemorrhagic fever
- GENERAL INTRODUCTION: ASFARVIRIDAE
- African swine fever
- GENERAL INTRODUCTION: RHABDOVIRIDAE
- Rabies
- Bovine ephemeral fever
- Vesicular stomatitis and other vesiculovirus infections
- GENERAL INTRODUCTION: REOVIRIDAE
- Bluetongue
- Ibaraki disease in cattle
- Epizootic haemorrhagic disease
- African horse sickness
- Equine encephalosis
- Palyam serogroup orbivirus infections
- Rotavirus infections
- GENERAL INTRODUCTION: POXVIRIDAE
- Lumpy skin disease
- Sheeppox and goatpox
- Orf
- Ulcerative dermatosis
- Bovine papular stomatitis
- Pseudocowpox
- Swinepox
- Cowpox
- Horsepox
- Camelpox
- Buffalopox
- GENERAL INTRODUCTION: PICORNAVIRIDAE
- Teschen, Talfan and reproductive diseases caused by porcine enteroviruses
- Encephalomyocarditis virus infection
- Swine vesicular disease
- Equine picornavirus infection
- Bovine rhinovirus infection
- Foot-and-mouth disease
- GENERAL INTRODUCTION: BORNAVIRIDAE
- Borna disease
- GENERAL INTRODUCTION: CIRCOVIRIDAE AND ANELLOVIRIDAE
- Post-weaning multi-systemic wasting syndrome in swine
- GENERAL INTRODUCTION: PRION DISEASES
- Scrapie
- Bovine spongiform encephalopathy
- Transmissible spongiform encephalopathies related to bovine spongiform encephalopathy in other domestic and captive wild species
African swine fever
This content is distributed under the following licence: Attribution-NonCommercial CC BY-NC  View Creative Commons Licence details here
View Creative Commons Licence details here
NJ Maclachlan and M-L Penrith (Editors). M-L Penrith, GR Thomson, ADS Bastos and EMC Etter, African swine fever, 2019.

African swine fever
Previous authors: M-L PENRITH, G R THOMSON AND A D S BASTOS
Current authors:
M-L PENRITH- Extraordinary Professor, BSc (Hons), BVSc (Hons), PhD, DSc, 40 Jan Shoba Street, Colbyn, Pretoria, Gauteng, 0083, South Africa
G R THOMSON- Director: TAD Scientific, BVSc, MSc, PhD, 150 Duvernoy Street, Constantia Park, Pretoria, Gauteng, 0181, South Africa
A D S BASTOS- Professor and Head, Department of Zoology and Entomology, Room 3-11, Zoology Building, University of Pretoria, Cnr Roper Street &Lynnwood Road, Pretoria, South Africa
E M C ETTER- Extraordinary Professor, UP &CIRAD, DMV, PhD, Faculty of Veterinary Science, University of Pretoria, Private Bag X04, Onderstepoort, Gauteng, 0110, South Africa
Introduction
African swine fever (ASF) is a devastating disease of domestic pigs caused by a unique virus that originally evolved in East and Southern Africa in an obscure cycle that was confined to its natural hosts, argasid ticks and wild suids. The introduction of domestic pigs into the same region resulted in a population of animals susceptible to the clinical effects of the infection, and in which the virus causes acute haemorrhagic disease, with morbidity and mortality rates that can reach 100 per cent. The character of the disease may change when it becomes endemic in domestic pigs, with considerably reduced mortality regardless of the virulence of the causative virus.
African swine fever was first recognized in East Africa as a disease with many clinicopathological resemblances to classical swine fever (hog cholera) (CSF).362 Studies conducted between 1910 and 1917 in Kenya demonstrated that it was caused by a virus that produced high mortality in domestic pigs, but that the resultant disease differed epidemiologically and immunologically from classical swine fever.362 In particular, outbreaks were related to association of free-ranging pigs with wild suids. Furthermore, inoculated bushpigs (Potamochoerus spp.) and warthogs (Phacochoerus africanus ) developed viraemia, but virtually no clinical signs. Unlike classical swine fever, neutralizing antibody was not detectable in recovered animals,260 and antisera to classical swine fever did not protect pigs against ASF.
In South Africa, a similar disease was first described533, 534 in the bushveld of the former northern Transvaal (now Limpopo Province), where there was regular contact between warthogs and domestic pigs. During an initial phase, from about 1900 to 1918, both CSF and ASF apparently occurred in South Africa, but the former had not been recorded since 1918 until an incursion into the Eastern Cape Province in 2004 that was eradicated by 2008.7, 427 An outbreak of ASF in the Witwatersrand area of the present Gauteng Province in 1933 spread to the Western Cape, apparently by movement of infected pigs. Control was eventually achieved by slaughter of sick and surviving animals, creation of quarantine zones and restrictions on re-stocking. However, one farm in the Piketberg district suffered repeated outbreaks from 1935 until 1939, ascribed to infection of young pigs by survivors,132, 256, 329, 387, 449 although persistent environmental contamination was evidently not ruled out. Periods of apparent freedom from outbreaks occurred in South Africa from 1918 to 1926, 1939 to 1951, and 1962 to 1973, but these may have been at least in part due to small numbers of domestic pigs in the control area and failure by farmers to report disease.459
African swine fever was described from Angola in 1932 although it was only confirmed to have been ASF later113, 188, 349, 352 and was first diagnosed in northern Mozambique in 1954.351 In Angola, an association with warthogs was neither observed nor investigated, and it was suggested that the free-ranging domestic pigs that roamed around the villages acted as a reservoir of the virus.113, 352 The disease was subsequently described from most countries in Central and Southern Africa.587 In West Africa, Senegal first reported ASF to the World Organisation for Animal Health (OIE) in 1978, but unpublished reports indicated that it was present in southern Senegal and probably Guinea Bissau at least as early as 1959.514 An unconfirmed outbreak occurred in Nigeria in 1973.38, 414
African swine fever attracted international attention when it reached Portugal in 1957 and again in 1960587 and became established in the Iberian Peninsula. Outbreaks subsequently occurred in several European countries as well as Cuba, the Dominican Republic, Haiti, and Brazil. For the first time the devastating effects of the disease in countries with well-developed commercial pig industries were appreciated. Eradication proved difficult and expensive. The arrival of the disease in Europe sparked considerable research, and concerted efforts were made to obtain a vaccine. Earlier attempts undertaken in Angola to develop a vaccine by passaging ASFV in rabbits were unsuccessful.350, 353 Passage in cell culture resulted in a vaccine that was widely used in Portugal in 1962 and later in Spain with some success but as a result strains of lower virulence emerged, and subacute and chronic forms of the disease, with a relatively high proportion of survivors, occurred.328, 509 Perhaps the most important result of the research carried out in Europe was the discovery that argasid ticks (soft ticks, eyeless tampans) of the genus Ornithodoros could maintain the virus for long periods and transmit it to pigs.502 Investigation of this possibility in Africa revealed that infected Ornithodoros tampans occurred in the burrows of warthogs,453 and that they transmit the infection to each other by various mechanisms and are essential to the presence of the virus in warthog populations.453, 454, 456 There is good evidence for the occurrence of a cycle of virus transmission between neonatal warthogs and eyeless tampans that live in burrows occupied by breeding female warthogs.544, 545
By 1995 ASF had been eradicated from all countries outside Africa with the exception of the Italian island of Sardinia, where it remains endemic.371 However, in 2007 an incursion of ASF occurred in the Republic of Georgia, and by the end of that year had spread to Armenia and Caucasian Russia; in January 2008 an outbreak occurred in Azerbaijan that owing to the small pig population was rapidly eradicated.117, 215, 502 Infected wild boars were detected in northwestern Iran in December 2008 and early 2009 but the disease did not spread as there are no domestic pigs in Iran.477 Georgia has reported that ASF has been eradicated,569 and Armenia last reported an outbreak to OIE in 2011, but over the subsequent decade there was marked, mainly westward expansion of ASF in Russia, and from 2012 new European countries became infected ( Table 1 ). In August 2018 China, the world ’s largest pig producer, reported its first outbreaks,581 with considerable spread in China and its neighbours as reflected in the OIE WAHIS database. Between January 2019 and April 2020 Mongolia, Vietnam, Cambodia, North Korea, Laos, Philippines, Myanmar, Indonesia, South Korea, Timor Leste and most recently Papua New Guinea have all reported ASF. Additionally, ASF was diagnosed in imported pigs at an abattoir in Hong Kong on three occasions between May and September 2019, raising concern about the disease to even higher levels globally.
In recent years, ASF has assumed greater importance in Africa, probably in relation to an exponential increase in pig production to satisfy the needs of rapidly expanding urban populations with more disposable income and no livestock.434 In 1982, ASF decimated the pig industry in Cameroon, where it now occurs endemically.459 There were reports of sporadic to regular outbreaks from countries in Southern and Central Africa and Senegal ( Table 2 ) until 1994, when a notable change in pattern occurred, with ASF outbreaks reported from an increasing number of both historically and newly infected countries or areas.434 The majority of these outbreaks were not associated with warthogs and affected smallholder pig producers.428
Pig farming by small-scale farmers globally is important in terms of social structure of the local population and gender balance, as pig farming often and in some areas mostly involves women and girls, providing a personal source of income for them.8, 339, 360, 382, 384, 416, 594 Although pig production in Africa contributes only approximately 5 per cent of the world ’s pork according to the FAO corporate database FAOSTAT ( http://www.fao.org/faostat/en/#data/QA ), it is of inestimable importance at local level in many African countries. At village level, especially in forested regions where cattle production is not an option, pigs are the major source of animal protein, the traditional animal for religious and cultural practices, and a mobile bank that provides funds for school fees, medical expenses and extras such as new clothing for special occasions that render a life of poverty more bearable.38, 104, 166-168, 379, 539 In most of these countries, pork is the cheapest meat available apart from fish and chicken, because pigs are unequalled in their ability to produce large quantities of high-quality protein from low-grade nutritional sources including human detritus. African swine fever is the one of the most important constraints for pig production in sub-Saharan Africa. The recent outbreaks that have mostly resulted in endemic establishment of the disease in domestic pigs have highlighted the need for innovative control methods to permit cost-effective pig production in extremely poor countries.104
Table 1 Outbreaks of African swine fever in Europe and Asia in 2007-2018 (excluding Sardinia)
| COUNTRY | 2007 | 2008 | 2009 | 2010 | 2011 | 2012 | 2013 | 2014 | 2015 | 2016 | 2017 | 2018 |
| Georgia | + | + | - | - | - | - | - | - | - | - | - | - |
| Armenia | + | + | - | + | + | - | - | - | - | - | - | - |
| Azerbaijan | - | + | - | - | - | - | - | - | - | - | - | - |
| Russian Federation | + | + | + | + | + | + | + | + | + | + | + | + |
| Iran1 | - | + | + | - | - | - | - | - | - | - | - | - |
| Belarus | - | - | - | - | - | - | + | - | - | - | - | - |
| Ukraine | - | - | - | - | - | + | - | + | + | + | + | + |
| Poland | - | - | - | - | - | - | - | + | + | + | + | + |
| Lithuania | - | - | - | - | - | - | - | + | + | + | + | + |
| Latvia | - | - | - | - | - | - | - | + | + | + | + | + |
| Estonia | - | - | - | - | - | - | - | + | + | + | + | + |
| Moldova | - | - | - | - | - | - | - | - | - | + | + | + |
| Romania | - | - | - | - | - | - | - | - | - | - | + | + |
| Czech Republic1 | - | - | - | - | - | - | - | - | - | - | + | + |
| Hungary1 | - | - | - | - | - | - | - | - | - | - | - | + |
| Bulgaria | - | - | - | - | - | - | - | - | - | - | - | + |
| Belgium1 | - | - | - | - | - | - | - | - | - | - | - | + |
| China | - | - | - | - | - | - | - | - | - | - | - | + |
1 Wild boars only
Table 2 Outbreaks of African swine fever in sub-Saharan Africa from 1978 to 2018
| COUNTRY | 1978 –2001 | 2002-2009 | 2010 | 2011 | 2012 | 2013 | 2014 | 2015 | 2016 | 2017 | 2018 |
| Angola | + | + | + | + | + | + | + | + | - | - | NR |
| Benin | + | + | + | + | + | + | + | + | + | + | NR |
| Botswana | + | − | − | − | − | − | − | - | − | - | - |
| Burkina Faso | - | + | + | + | + | + | + | + | + | + | + |
| Burundi | + | + | − | − | − | − | − | + | + | + | NR |
| Cameroon | + | + | + | + | + | + | + | + | + | + | NR |
| Cape Verde | (+) | + | − | − | − | − | (+) | + | - | + | + |
| Chad | + | − | + | + | − | − | + | + | + | - | + |
| Central African Rep | - | - | + | - | + | - | - | + | + | + | + |
| Congo (Rep. of) | + | + | - | + | + | - | - | + | + | - | - |
| Congo (DR) | + | + | + | + | + | + | + | + | + | + | NR |
| C ôte d ’Ivoire | + | - | - | - | - | - | + | - | - | + | + |
| Ethiopia | - | - | - | (+) | - | - | (+) | - | - | - | NR |
| Gambia | (+) | - | - | + | - | - | - | - | + | + | + |
| Ghana | +(1999-2000) | +(2002) | + | + | + | + | + | + | + | + | NR |
| Guinea Bissau | (+) | + | + | - | - | - | - | + | + | + | + |
| Kenya | + | + | + | + | - | - | - | + | + | + | - |
| Liberia | - | - | (+) | (+) | - | - | - | - | - | - | - |
| Madagascar | + (1998) | + | - | + | + | + | + | + | + | + | + |
| Malawi | + | + | + | + | + | + | - | + | + | + | NR |
| Mali | - | - | - | - | - | - | - | - | + | - | - |
| Mauritius | - | + (2007-8) | - | - | - | - | - | - | - | - | - |
| Mozambique | + | + | + | + | + | + | + | - | + | + | NR |
| Namibia | + | + | − | - | + | + | + | - | + | + | + |
| Nigeria | + (1998) | + | + | - | + | + | + | + | + | + | + |
| Rwanda | - | + | + | + | - | + | + | NR | ? | + | NR |
| S ão Tom é | +(1979) | +(2002) | - | - | - | - | - | - | - | - | NR |
| Senegal | + | + | - | - | - | - | - | - | + | + | + |
| South Africa | + | + | - | + | + | [+] | + | [+] | + | + | + |
| Tanzania | + | + | - | + | - | + | + | + | + | + | + |
| Togo | + (1997) | + | - | + | + | + | + | + | + | + | NR |
| Uganda | + | + | + | + | + | + | + | + | + | + | + |
| Zambia | + | + | + | + | + | + | + | + | + | + | + |
| Zimbabwe | + (1992) | - | - | - | - | - | - | + | - | - | - |
Key: + = one or more outbreaks reported to OIE; −= no outbreaks reported to OIE; (+) = outbreaks occurred, not reported to OIE (reported to AU-IBAR and may not have been confirmed; the outbreaks in Ethiopia were reliably confirmed); NR = No report
Countries that have not reported ASF, with the exception of Guinea Bissau and Cape Verde, are omitted from the table. They are: Comoros, Djibouti, Equatorial Guinea, Eritrea, Eswatini (formerly Swaziland), Gabon, Guinea, Lesotho, Niger, Seychelles, Somalia and Sudan. Sierra Leone had not reported outbreaks in the period covered by the table but reported its first outbreaks to OIE in 2019.
Aetiology
African swine fever virus (ASFV) is a large enveloped double-stranded DNA (dsDNA) virus that is currently the sole member of the family Asfarviridae . Based on the size of its genome and replication strategies it is considered to be a member of the nucleocytoplasmic large DNA virus (NCLDV) superfamily that includes the Poxviridae, Iridoviridae, Phycodnaviridae and Mimiviridae ( https://talk.ictvonline.org/ictv-reports/ictv_online_report/dsdna-viruses/w/asfarviridae ).16 This virus was initially classified as a member of the family Iridoviridae due to structural similarities and the cytoplasmic location of its genome.229, 336 However, subsequently greater similarity of the genome structure and replication strategy of ASFV to those of members of the Poxviridae were observed.82, 115, 571 Therefore, it was removed from the Iridoviridae and until 2001 ASFV remained within an unassigned or floating genus.144, 175 It is currently the sole member of the family Asfarviridae , which takes its name from ‘A frican s wine f ever a nd r elated ’viruses, and the type species of the genus Asfivirus .175 Other features distinctive to ASFV are that it is the only known arbovirus (ar thropod-bo rne virus) with a DNA genome290, 461 and that it is only one of a limited number of DNA viruses in which polyprotein processing has been shown to occur.523, 524
Extracellular, enveloped ASF virions have an average diameter of 200 nm and icosahedral symmetry. Virions are composed of concentric layers of different electron densities.24, 102 They comprise a central electron-dense nucleoprotein core consisting of a DNA-containing nucleoid, surrounded by an inner core shell made of a thick protein coat.24, 102 This inner nucleoprotein core, 70 to 100 nm in diameter, is encircled by a lipid envelope, which in turn is enwrapped by an outer protein capsid layer with icosahedral symmetry.102 Between 1892 and 2172 capsomers, 13 nm in diameter, which have the appearance of a hexagonal prism with a central hole, make up the icosahedral capsid.102, 518 The fifth layer, a lipid envelope, observed in extracellular virions, is acquired by virions budding from the plasma membrane.24
Based on analyses of available complete genome data, between 150 and 167 open reading frames (ORFs) were identified, for which information on function and/or structure is available for 113 proteins.143, 597 These include proteins belonging to ASFV multigene families, structural proteins, enzymes involved in DNA replication, nucleic acid repair and protein processing and those modulating the immune response and apoptosis.597 Subsequent studies have reported between 150 and 170 ORFs for different isolates.15, 189 The ds DNA genome ranges in size from 170 to 190 kbp, depending on the virus strain62 and has terminal inverted repeats and hairpin loops.227, 529 It can be divided into three distinct parts, a central conserved region approximately 125 kbp in length that is flanked by two regions of variable length.62, 142 These flanking regions are termed the left variable region (LVR) and right variable region (RVR) and range from 38 to 47 kbp and 13 to 16 kbp, respectively, across different ASF viruses.62 The largest degree of length variation is observed in the LVR, but minor length variations have also been noted in the central region, approximately 90 to 93 kbp from the left DNA terminus.276, 482, 538 The first complete genome sequence of a Spanish isolate BA71 was shown to have a G+C content of 38,95 per cent.597 Subsequent studies reporting full genome sequences of unrelated ASF isolates confirm that ASF viral genomes are predominantly A+T rich.134, 146, 482
Mechanisms for entry of ASF virus into cells and replication have recently been reviewed.189 In addition to support for receptor-mediated endocytosis,25, 557 evidence exists for additional mechanisms that include phagocytosis and micropinocytosis and it has been shown that cholesterol is necessary for entry, as well as for release of naked cores into the cytosol for replication.189 Two proteins, p12 and p54, have been implicated in virus attachment and one, p30, in internalization.217, 218 However, the receptor/s of the virus are yet to be identified.189
On uncoating, replication of viral DNA occurs primarily in the cytoplasm. However, an early nuclear replication phase precedes this that is characterized by the synthesis of small DNA fragments of approximately 2000 nt in length.206, 492 Investigation into this phenomenon suggests that the small nuclear DNA fragments are converted in the cytoplasm to fragments corresponding to one-fourth to one-third of the genome. These intermediate cytoplasmic fragments are probably ligated to produce mature cross-linked DNA.492 DNA replication peaks approximately eight hours post-infection, at which time dimeric head-to-head concatameric forms of DNA are observed.87, 492 DNA replication regulates viral gene expression and divides transcription and translation into an early and late phase. Early mRNA synthesis and processing take place in the cytoplasm by means of virally encoded enzymes and transcripts are 5 ’-capped and 3 ’-polyadenylated. Host-cell RNA polymerase II is not involved in either early or late RNA synthesis. After viral DNA replication, new RNAs appear which specify late proteins.160 Approximately 35 early proteins and 71 late proteins occur, some of which are characterized by post-translational modifications such as proteolytic cleavage, phosphorylation, glycosylation and myristylation. Ten hours post-infection, virions are released from the cell by budding through the plasmalemma, acquiring the outer envelope in the process ( Figure 1 ).189 Microtubules are essential for transporting the virus to the perinuclear area where replication takes place and to the cell membrane for egress.189
Viral morphogenesis is co-localized with viral DNA replication and occurs in discrete cytoplasmic areas known as ‘viral factories ’situated close to the nucleus.80, 368, 492 This perinuclear area is rich in fibrillar and membranous organelles and is often surrounded by an enlarged Golgi apparatus, and by large numbers of ribosomes and mitochondria.491 The latter migrate to the viral assembly sites and are thought to provide the energy required for virus assembly.491 First, the membrane structures take on a polyhedral form through capsid formation on their surface. Beneath this lipid envelope, two successive viral domains are formed: first a thick protein layer of about 30 nm, constituting the inner core shell appears, followed by the viral nucleoid.24 The membrane that enwraps the nucleoprotein core was thought to consist of a two-membraned collapsed cisterna derived from the endoplasmic reticulum.23, 493 However, a later study using different techniques concluded that the membrane consists of a single lipid bilayer255 that fuses with or is derived from the limiting membrane of the endosomes.189, 257, 537
Gel electrophoresis of purified virions identified between 34 and 54 structural proteins, with molecular masses of between 10 and 150 kDa, by one-dimensional101 and two-dimensional gel electrophoresis161 respectively. Of the more than 150 virally-encoded proteins, 12 ASFV genes have been shown to encode 16 structural proteins, six of which are derived from proteolytic cleavage.191, 597 The capsid protein VP72 (also referred to as VP73) makes up about 32 per cent of the total protein mass of the virion,311 whilst approximately 25 per cent is provided by the ordered proteolysis of polyprotein 220 (pp220).24, 523 Although polyprotein (pp) processing is a common gene expression strategy in positive sense RNA viruses and in retroviruses, it is atypical in DNA viruses.148 African swine fever virus is, however, an exception, as it encodes at least two distinct polyproteins. The larger polyprotein, pp220, gives rise to four major structural proteins, p150, p37, p34 and p14,523 whilst the smaller polyprotein, pp62, is post-translationally processed to produce two structurally important proteins, p35 and p15.522 The larger pp220 is localized at the core shell, between the nucleoid and inner envelope, and is essential for core assembly and may also function as a membrane-anchoring signal that binds the developing core shell to the inner viral envelope. Repression of the pp220 gene leads to the assembly of icosahedral core-less particles.22 Both ASFV polyproteins are cleaved by a 31 kDa cysteine protease encoded by the virus gene S273R, which is expressed late after infection.21 Other proteins of structural importance with putative transmembrane regions include p12, p17, p22 and p54.9, 89, 485, 524 Three structural proteins believed to have DNA-binding capacity include p10, p14.5 and a highly conserved histone-like protein corresponding to ORF A1104R of the BA71 strain.597 The twelfth structural protein, p49, encoded by the B438L ORF is a late protein that contains a cell attachment ‘RGD ’.191 Of all the structural proteins characterized to date, VP72, the major structural protein, is particularly important as it contains a neutralization site, is antigenically stable and therefore useful for viral diagnosis, and has properties that make it suitable for molecular epidemiological studies.50, 183, 541, 602 Neutralizing antibodies have also been mapped to p54 and p30,217, 218, 602 whilst antigenic variation primarily involves structural proteins p150, p14 and p12.144 Identification of ASF viral proteins and elucidation of their functions is ongoing and several recent studies have identified further proteins essential for or associated with viral replication.43, 73, 184-186, 470
Haemadsorption, an important diagnostic phenomenon ( see Diagnosis ) has been linked to ORF EP402R of Spanish isolate BA71 and ORF 8-DR in Lil 20/1, a virus of Malawian origin.72, 487 This gene encodes a protein homologous to CD2, the cell adhesion receptor of T cells and an immune response modulator. Through construction of an 8-DR gene deletion mutant, it was shown that 8-DR had no effect on disease onset and course, or on mortality in vivo . However, immunosuppressive activities could be attributed to it as onset of viraemia was significantly delayed and virus titres were reduced 10 000-fold five days post-infection on inoculation with the deletion mutant.71 It has been suggested that non-haemadsorbing viruses are associated with reduction in or loss of virulence67, 203, 303 but other studies have demonstrated the existence of virulent non-haemadsorbing strains.226, 546
The stability of ASFV across a wide temperature and pH range has long been a notable feature. Virus survives in serum at room temperature for 18 months,362 and in blood at 4 °C for at least six years,132 at 37 °C for up to a month and at 55 °C for 30 minutes.387, 520 Virus also remains stable from pH 4 to 10, although infectious virus has been recovered from serum after one week at pH 13,4 and after three days at pH 3,9.452 Putrefaction does not readily destroy the virus —it can persist in faeces for 11 days at room temperature and in decomposed serum for up to 15 weeks. Stability in meat and in meat products has been a major factor in virus dissemination with virus survival in chilled meat and processed hams being 15 weeks and almost six months, respectively.459
In the laboratory, tissues should be stored at –70 °C to retain infectivity indefinitely. Storage at –20 °C is not recommended. The half-life of infectivity of cultured virus in a medium with 25 per cent serum is approximately 24 hours at 37 °C and up to four months at 4 °C. In serum-free medium half-life infectivity at 37 °C was eight hours. The virus is also heat resistant, with some infectivity remaining even after treating cultured virus at 56 °C for 30 minutes. Samples are, however, completely inactivated after incubation at 60 °C for 30 minutes, making this a suitable method for rendering serum samples safe.109, 452
Intact virus is highly sensitive to lipid solvents and detergents, which probably attack the internal lipid membrane and also to oxidizing agents such as hypochlorite, as well as substituted phenols. It is, however, resistant to proteases such as trypsin and pepsin and to nucleases, but is inactivated by pancreatic lipase.259, 536 Formalin at 0,5 per cent kills the virus, but inactivants such as Β-propiolactone, acetylethyleneimine or glycidaldehyde are much more reliable and rapid, removing infectivity within one hour at 37 °C.535 Various commercial disinfectants are effective against ASF virus.
Epidemiology
The ASFV is unrelated to any other known virus and is well adapted to long-term survival in a cycle involving arthropods289 and wild suids356, 459 indigenous to East and Southern Africa, where it is safe to assume that this virus evolved.14, 356 The history of domestication of pigs on the African continent is obscure due to lack of information in comparison with Europe and Asia, but the available evidence indicates that pigs were domesticated in Africa long before the European colonists arrived, although introduction of pigs from both Europe and the Far East has contributed materially to the local breeds farmed in Africa today.18 Regular losses among the pigs introduced to eastern and Central Africa are likely to have occurred before the disease was first identified and described in Kenya early in the twentieth century by Montgomery362 because the indigenous hosts of the virus were undoubtedly widely distributed in those regions. At the time of the discovery of the cause of ASF, the relatively small numbers and limited economic importance of pigs as well as the effectiveness in some countries of simple, though stringent, control measures132 greatly reduced the impact of ASF.459 However, the impact of the disease has become significant as the pig population of Africa has grown, with increased introduction of modern breeds. Basic control measures aimed at separating domestic and wild pig populations are no longer all that is necessary to prevent outbreaks, as anthropogenic factors related to pig production and trade have superseded the sylvatic cycle in providing sources of infection for domestic pigs.428, 434 Incursions of ASF into Western Europe in 1960 via Portugal and Eastern Europe via the Republic of Georgia in 2007 have had substantial economic consequences and the disease is considered a major threat to the most important pig-producing countries globally.118, 407, 510 Fears that ASF would reach China, which has half of the world ’s pig population,571 were realised in August 2018, followed by rapid spread through eastern China, spreading to neighbouring Mongolia, Vietnam and Cambodia in rapid succession.398, 581 As indicated in the Introduction, several more countries in South-east Asia and the Pacific region have become infected as well. This spread is of great concern for the USA, which for many years has been preparing a strategic response to the emergence of ASF and has recently intensified risk assessment and preparedness.217, 260, 561, 600 Pork products contaminated with ASFV have been detected in the luggage of airline passengers arriving from China in Japan ( http://promedmail.org/post/2081023.6107744 ; http://promedmail.org/post/20181110.6138072 ), South Korea ( http://promedmail.org/post/20180826.5988921 ), Taiwan and Thailand (http://promedmail.org/post/20181208.6197525; http://promedmail.org/post/20181222.6221397) and Philippines (https://www.globalmeatnews.com/Article/2019/10/28/Philippines-authorities-seize-smuggled-pork-from-China?utm_source=newsletter_daily&utm_medium=email&utm_campaign=29-Oct-2019&c=diuPkcJM4SBnI%2FI4xzrOJN1gyQvxppI3&p2=). The spread of ASF in Europe since 2007 and its establishment in many previously unaffected African countries since the last decades of the 20th century unfortunately negate a statement published in 1982 that ASF was declining everywhere.503
Distribution of ASF in Africa
Historically confined to East and Southern Africa, by 2016 almost all the sub-Saharan African countries where pigs are kept had reported ASF at least once, including four island nations ( Table 2 ). Currently the northern limit of ASF in Africa is determined largely by the predominance of both desert conditions and religious prohibitions that severely limit pig production in North Africa. In the south, the limit has been determined by the distribution of the warthog-tick cycle, the southernmost known part of which is a delimited control zone in the north-eastern part of South Africa.321
The identification in 1921 of ASF as a disease distinct from CSF after outbreaks were reported from farms in what were then British and German East Africa from 1909362 was followed by reports of outbreaks that occurred between 1912 and 1954 in South Africa,533, 534 Angola,188, 352 Democratic Republic of Congo,500 Malawi,335, 550-552 Mozambique,2, 351 and Zambia.590 By 2016 all of the remaining mainland countries in Southern and East Africa, with the exception of Lesotho and Eswatini (formerly Swaziland), had experienced ASF ( Table 2 ). A recent investigation of ticks from warthog burrows in Eswatini failed to detect ASFV.76 The 1990s saw increased ASF activity in the sub-region; in 1993 ASF was reported for the first time south of the Save River in Mozambique and in 1994 ASF was reported in commercial pigs around Nairobi in Kenya for the first time in more than 30 years.434 The two Indian Ocean Islands of Madagascar and Mauritius experienced ASF for the first time in 1997 and 2007 respectively, and although it was eradicated rapidly in Mauritius, ASF remains endemic in Madagascar.281, 314, 490 In 2011 Ethiopia was the last country in eastern Africa to report ASF.3, 36 The sylvatic cycle involving warthogs has been demonstrated in most of these countries, with the exception of the two islands281 and Ethiopia, but the isolation of two variants of a novel ASFV genotype from the Ethiopian outbreaks raised suspicion of a possible sylvatic cycle origin.3 Ethiopia has a small pig population estimated at 29,000 between 2005 and 2011 according to FAOSTAT and pig production in Ethiopia is relatively recent.346, 542
The first unofficial reports of ASF in West Africa emanated from Senegal, Cape Verde and Guinea Bissau in about 1959,162, 514 confirmed in Senegal by a virus ‘Dakar/59 ’that has been used in several molecular genetic studies.50, 390, 445 Although only Senegal regularly reported outbreaks, mainly from the southern Casamance province, sporadic reports from Cape Verde, The Gambia and Guinea Bissau suggested an endemic focus among the four countries.81 S ão Tom ée Principe suffered an outbreak in 1979503, 583 and two later unconfirmed outbreaks, all rapidly eradicated by depopulation.370 Cameroon reported its first outbreaks in 1982, and in spite of stamping out efforts the disease remains endemic.381, 434 Until 1996, apart from the aforementioned limited and unconfirmed outbreak in Nigeria in 1973,38 there were no reports of ASF from West African countries apart from the Senegal endemic focus.
The 1990s and the subsequent decades saw considerable expansion in the extent and number of countries affected by ASF in sub-Saharan Africa that is only partly due to improved reporting since about 2008. The most important event was an epidemic that started in C ôte d ’Ivoire in 1996154 and by 2003 had involved 5 more countries: Benin, Togo and Nigeria suffered serious outbreaks in 1997 and Ghana in 1999, where ASF was eradicated by early 2000 but was re-introduced near the border with Togo in 2002. Burkina Faso reported its first outbreak in 2003.38, 81 Increased incidence with heavy losses occurred in Cape Verde in 1998 and in The Gambia in 1998 and 2000. ASF has become endemic in all of the West African countries where it has occurred with the exception of C ôte d ’Ivoire, where it was eradicated by 1997. However, it resurfaced when an outbreak occurred in 2014 in the port city of San Pedro, a city not affected by the outbreaks in 1996, where pigs had access to a landfill used for disposal of waste from ships,120, 294 and an incursion occurred close to the border with Burkina Faso in October 2017 that was only declared resolved in August 2018. No outbreaks were reported between October 2017 and March 2018, but a number of outbreaks occurred further south west in the vicinity of Korhogo, the largest city in northern C ôte d ’Ivoire between April and July 2018. ( http://www.oie.int/wahis_2/public/wahid.php/Reviewreport/Review?reportid=27167 ) In 2016 Mali, with a very small pig population, reported an outbreak close to the Burkina Faso border.572 According to FAOSTAT Nigeria has by far the largest pig population in Africa, and Burkina Faso is also one of the countries with high numbers of pigs. Outbreaks in Nigeria in 1997-1998 were responsible for 15,000 pigs ’deaths, and an outbreak in Ibadan in 2001 involved 31,916 pigs on 306 farms.38 The continuous presence and spread of ASF after the 1997 incursion has remained a problem in the Nigerian pig sector,171 and, since the introduction of the OIE WAHIS database in 2005, Nigeria has reported outbreaks every year except 2011.572 Thousands of deaths in pig farms in Nekede, Imo state, Nigeria in November 2017 were reported. ( http://www.promedmail.org/post/5427723 ) The biannual reports to OIE by Benin, Burkina Faso, Ghana and Togo also reflect ongoing outbreaks ( Table 2 ).
Elsewhere in the African region, in 2010 an outbreak of ASF occurred for the first time in northern Cameroon, followed by outbreaks in neighbouring Chad and in Central African Republic that were believed to have been connected, with both countries having reported sporadic outbreaks after that ( Table 2 ).42, 59, 572 In 2011 Liberia, like Ethiopia, reported outbreaks of ASF to the AU-IBAR36 but the Liberian outbreaks were not confirmed. During the same period, a number of long-time infected countries experienced increased or unusual ASF activity, while reports to the OIE indicated that some countries, e.g. Democratic Republic of Congo (DRC) and Rwanda, experienced numerous outbreaks annually.572
A recent change in the pattern of ASF outbreaks has been observed in Namibia, South Africa and Zimbabwe, which historically experienced only sporadic warthog-related outbreaks. In the last decade Namibia experienced outbreaks in northern districts near the border with Angola and South Africa has reported outbreaks in previously ASF-free parts of the country that are unlikely to be related to the sylvatic cycle.572 In 2015 and again in 2019 Zimbabwe experienced ASF outbreaks in the north-eastern part of the country bordering an endemic area in Mozambique that were considered to be the result of cross-border trade.559, 572
Distribution of ASF outside Africa
After the accidental introduction of ASF Africa to Portugal in 1957 and again in 1960, probably from Angola, and its establishment throughout the Iberian Peninsula, the disease repeatedly spread mainly by illicit movement of pigs or pig products to invade other western European countries as well as several Caribbean countries (Cuba in 1971 and again in 1980, Dominican Republic in 1978, Haiti in 1979) and Brazil (1978).60, 259, 260, 459, 503, 583, 585, 587 An outbreak that occurred in 1977 around the port of Odessa in the USSR (now in Ukraine) has only recently been described.293 All these epidemics were eliminated, frequently at considerable cost, by draconian measures involving the destruction of large numbers of pigs, sometimes accomplished by the deployment of foreign aid, with the exception of Sardinia, which after 1995 was the only location outside Africa where the infection persisted.371, 587 Nevertheless, a focus occurred in Portugal in 1999, six years after ASF had been officially declared eradicated,67 presumed to be due to the presence of infected Ornithodoros erraticus ticks in the pig sties,67 which had played a role in maintaining the infection in parts of the Iberian Peninsula prior to eradication.66, 88, 396, 397, 439, 502 All the extra-African extensions of the disease involved genotype I viruses and were presumed derived from one of the two introductions of the virus into Portugal because the viruses had broadly similar genomes and antigenic characteristics and were usually cross-protective.344 Subsequent molecular genetic investigations confirmed genetic identity with the 1960 virus.50, 445, 583 and demonstrated that it differed from the 1957 virus, confirming that there were two introductions.390
Between the unexpected tick-related outbreak in Portugal in 199967 and 2007 the only outbreaks outside the African region were reported from Sardinia, but the confirmation in 2007 of outbreaks of ASF caused by a genotype II in the Republic of Georgia495 unleashed an outbreak that at present continues to spread in Europe and Asia (Table 1). The outbreaks that occurred in Georgia and its neighbours in 2007 and 2008213, 471, 495, 513 were followed by endemic establishment in the Russian Caucasus.213, 393 By 2012 ASF had spread in central Russia, and outbreaks had increasingly occurred in distant locations,213, 393 with subsequent spread to Ukraine (2012), Belarus (2013), and Lithuania, Poland, Latvia and Estonia (2014).195, 392, 402 Since then, outbreaks have also occurred in Moldova, Romania and Bulgaria in domestic pigs and cases have been reported in wild boars in Bulgaria, Czech Republic, Hungary and most recently in Belgium ( Table 2 ).207, 572 It was rapidly established that the introduction into Georgia was due to a highly virulent virus unrelated to the virus circulating in Sardinia but closely related to viruses circulating in Mozambique, Madagascar and Zambia.495 The virus has remained largely unchanged in terms of virulence but minor genetic changes have proven helpful in tracing the possible origin of viruses isolated from outbreaks.195, 213, 214
Where contact with domestic pigs occurred, the outbreaks in the Iberian Peninsula and Sardinia affected wild boars. Eurasian wild boars (Sus scrofa scrofa andS. scrofa meridionalis )401 are ancestors to domestic pigs and, like them, fully susceptible to the pathogenic effects of the virus, although, as in domestic pigs, some individuals can resist the pathogenic effects of the virus and be subclinically infected.300, 372, 374, 391, 436 Wild boars have been involved in the outbreaks in the Caucasus and Eastern Europe since 2007 and in spite of experiencing high mortality have been involved in transfrontier transmission of ASF.195, 213, 392, 471
Transmission of ASF virus
Unlike the majority of infectious diseases, ASF is both vector-borne and contagious. The details of transmission will be discussed under the different cycles where appropriate, but in brief, vector-borne transmission may be either by the biological vector, a soft tick of the genus Ornithodoros , or mechanical by other blood-sucking insects. So far the only blood-feeding insect that has been demonstrated to be a competent mechanical vector for ASFV is the stable fly, Stomoxys calcitrans , which is capable of retaining high levels of virus (>104 HAD50 /fly) for two to three days and of transmission to pigs during feeding 24 hours after virus ingestion.347, 398 It was also shown that pigs could be infected by ingesting flies spiked with infective blood.400 These flies can therefore potentially spread the virus mechanically during ASF outbreaks. Various other potential vectors for ASFV have been investigated to determine their ability to transmit the infection. These include ixodid ticks, Auchmeromyia and Lucilia larvae, lice, mosquitoes and mites, so far with negative results.181, 295, 450, 459 The maximum period of virus persistence in hard ticks was about five to six weeks in nymphs of Rhipicephalus simus .450 More recently, it was reported that ASFV could be detected in Ixodes ricinus and Dermacentor reticulatus , common ixodid tick species in Europe, for up to 8 weeks after a blood meal but there was no evidence of replication in either species and the authors concluded that it was unlikely that they could play a role in transmission of ASF.131 There are conflicting reports on the ability of the pig louse (Haematopinus suis ) to transmit ASFV between pigs. It has been claimed that lice from an infected pig transmitted virus after a 40-day incubation period to a recipient animal that died 42 days later.504 Other investigations have not confirmed transmission, although virus persisted in small quantities for about 24 hours.265, 295 It is unlikely that the pig louse would be an effective transmitter of ASF virus, since individual lice spend their lives on the host, survive only for a short time (2-3 days) off the host, and are transmitted only between pigs in close contact,94 during which direct pig-to-pig transmission would be highly probable. However, further investigation of the competence of blood-feeding flies other than the stable fly to mechanically transmit the virus should be undertaken.
Infected domestic pigs and Eurasian wild boars serve as potent sources of the virus, as large amounts of virus are present in the blood and are shed in secretions and excretions, particularly during the peak of infection when clinical signs are present.126-128 Both direct and indirect transmission are common. Shedding starts from 1-7 days post-inoculation depending on isolate and route of infection.128, 153, 237, 342 In acute infection of domestic pigs with African isolates, ASFV is excreted by the naso-pharyngeal route as early as 24 to 48 hours before the onset of pyrexia or other clinical signs and may be infectious to other pigs,32, 459 although the quantity of virus shed may not attain the infection threshold for contact pigs until the second day of fever.237, 362 The virus has been reported to be present in all physiological secretions and excretions, including nasal, oral, pharyngeal, conjunctival, genital, urinary and faecal.237, 362 A recent study using three viruses of variable but reportedly moderate virulence found that titres were lowest in nasal, ocular and vaginal excretions and that virus was only consistently present in oropharyngeal swabs and blood, and occasionally present at high titres in faeces.128 The study reported that infective virus could be retrieved from oropharyngeal swabs for up to 70 days, but as in other studies a marked reduction in shedding of virus was observed after 30 days.128, 585, 592, 593 Another recent study using the virulent Georgia 2007/1 isolate found that infectious virus could be present in a low number of faeces and urine samples and these excretions could therefore result in either direct or indirect transmission to pigs.126 Using the Georgia 2007/1 virus, the latent period between exposure and development of clinical signs was 4.4 (+/-1.0) days in pigs inoculated intramuscularly and 9.9 (+/-1.6) and 12.7 (+/-2.0) days in within-pen and between-pen in-contact pigs, respectively.242 A study using the closely related Armenia08 virus provided a latent period of 3 days in wild boars and 3-8 days in domestic pigs.446 However, a field study based on mortality data in Russia caused by the same strain suggested a longer mean latent period by 1 or 2 days and a shorter infectious period by 1 –4 days, and the basic reproduction ratio R0 varied widely between different herds, despite involvement of the same virus strain.241 Direct transmission occurs when pigs inhale or ingest excreted infected material or blood through contact with infected cohorts. Two experimental studies have shown that pigs can generate infected aerosols and that these can produce infection in pigs within the same enclosed space up to a distance of 2.3 metres above the pigs.589 The second study found the same amount of virus in aerosol samples 1 metre above the pigs and at the exit to the room in which the pigs were kept; the distance from the pigs to the exit was not provided but it was presumably considerably more than 2.3 metres.130 However, both studies concluded that although aerosols containing ASF virus were generated by infected pigs, airborne transmission between herds was unlikely.130, 589
Indirect transmission commonly occurs by contact with contaminated objects (fomites) including feed, water and feed containers, clothing and footwear, and equipment, or by feeding swill containing uncooked infected pork.431 Vehicles used to transport pigs may enable contaminated material to be spread over long distances.377 The virus survives well in a protein environment such as fresh or frozen pork, including some processed uncooked products, and the introduction of ASF into distant destinations is usually attributed to the careless or illegal disposal of galley swill containing infected pork from ships or aeroplanes that results in access for pigs.13, 314, 366, 495, 586
Recent research to determine the R0 for ASF in domestic pigs in Europe and Africa and in wild boars has suggested that the traditional description of ASF as a ‘highly contagious ’disease exaggerates the speed with which the virus spreads in populations. Models developed from an experimental study using a moderately virulent virus and from existing data on outbreaks caused by the virulent virus circulating in the Caucasus since 2007 suggested rather a high R0 , between 9.8 within farms for the virulent virus circulating in Russia245 and 18 for the moderately virulent Malta/78 virus,127 although the between farm estimate for Russia was lower, at 2-3.245 However, most studies based on experimental and observed or historical field infections have suggested much lower R0 values of 1.58,274 5.0 within pens and 2.7 between pens240 and 1.58-3.24 for transmission between smallholder pig herds in Uganda.47 An experiment to evaluate the effects of low dose oral infection and contact infection in wild boars and domestic pigs found the within pen R0 for contact infected wild boars to be 6.1 and 5.0 for a mixed group, while the between pen R0 for a group of wild boars and a group of domestic pigs was 0.5,446 suggesting that close contact facilitated transmission. A within farm R0 of 7.46 and a between farms R0 of 1.65 was calculated for the 1977 outbreak in Ukraine, caused by a genotype I virus closely related to those circulating in Europe at the same time.293 Models developed from an experimental infection study using the virulent Georgia 2007/1 strain, in which the infectious period could not be determined owing to the need to euthanize pigs within a few days after the infection for welfare reasons, indicated that the length of the infectious period had a strong influence on the R0 . The models predicted higher R0 values as the duration of infectiousness increased.240 This might help to explain the much higher R0 obtained when pigs were infected with the moderately virulent Malta 78 virus.
In Africa, ASF viruses appear to persist in at least three different cycles:
- a sylvatic association between warthogs and the Ornithodoros moubata complex ticks that are associated with warthogs because they inhabit their burrows in the savannah zones of East and Southern Africa (warthog-tick cycle);
- a cycle involving domestic pigs and Ornithodoros ticks that live in pig houses that was first described in the Iberian peninsula between Ornithodoros erraticus and domestic pigs and has since been described in west-central Malawi and Mozambique ( Figure 6a ) and possibly exists elsewhere (domestic pig-tick cycle); and
- maintenance of the virus in domestic pig populations independent of the agency of wild suids or ticks (domestic cycle).
Outbreaks may involve more than one of the cycles, as after an initial infection of domestic pigs by the bite of an infected tick, either from the warthog-tick or the pig-tick cycle, propagation is likely to continue through the domestic cycle.
Three cycles of maintenance and transmission of ASF virus have been identified in non-African destinations:
- A domestic pig-tick cycle involving Ornithodoros erraticus complex ticks that was present in parts of the Iberian Peninsula;
- A domestic/domestic-sylvatic cycle involving circulation in domestic pig and/or wild boar populations;
A third cycle involving wild boars and the environment has recently been proposed to explain sustained circulation in large wild boar populations.105 In the Baltic countries that became infected with ASFV through cross-border movement of wild boars, a shift in previously observed patterns seems to have occurred, with wild boars becoming the main host of the virus, which suggested the need to define a cycle involving wild boars only.56, 74 Involvement of the environment in maintenance is favoured by the low prevailing temperatures at northern latitudes.
Sylvatic cycle in Africa
The sylvatic cycle in warthogs ( Figure 2 ) and Ornithodoros moubata complex ticks that inhabit their burrows ( Figures 3 and 4 ) is well documented.281, 459 A simplified diagram showing the role of ticks and warthogs in the natural history of ASF is given in Figure 5 . It has been shown that young warthogs still confined to the burrows in which they were born (i.e. less than approximately four weeks of age) develop viraemias high enough to infect O. moubata ticks that feed on them, providing good evidence for a cycle of infection between the vertebrate and invertebrate hosts of ASFV.459, 544, 545 The frequency and level of viraemia are important in relation to the infection of argasid ticks feeding on warthogs; field surveys have consistently shown low levels in all but very young animals.459 In four of six naturally infected neonates sampled from central Namibia, the blood virus levels exceeded 102,1 HAD50 /ml of blood. In two of these animals the levels of viraemia were above 103,0 HAD50 /ml.545 The possibility of vertical transmission from female warthogs to their offspring either in utero or via colostrum has been shown to be unlikely.459 It therefore appears that neonatal warthogs undergo tick-transmitted ASFV infections manifested by a viraemia that may exceed 102 HAD50 /ml for up to about three weeks, but is thereafter intermittent and at levels that are too low for titration. After the first generalized phase of infection the virus localizes in various superficial and visceral lymph nodes, in particular the parotid and mandibular nodes, with virus levels varying between trace amounts and 106,6 HAD50 /g.459 In free-ranging warthogs the virus has rarely been found other than in lymph nodes, with even the spleen being free in 80 per cent of warthogs examined.459 The lungs, liver and kidneys were always virtually virus free.266, 450 However, in experimentally infected warthogs high levels (>105 HAD50 /g) of virus were found in spleen and lungs up to 7 and 11 days respectively after infection, indicating that this may also occur in the field.547 It is unknown whether virus in the lymph nodes of older animals represents the original inoculum or superinfection by antigenic variants.
It was established early in the investigation into ASF that the infection is not generally transmitted from infected to non-infected warthogs or to domestic pigs.136, 362, 573 Subsequent experiments supported this observation.544 It had been suspected for many years that ASFV transmission in Africa involved arthropod vectors but initial attempts to demonstrate the virus in either argasid or ixodid ticks collected in warthog environments failed, although it was shown experimentally that argasid ticks of the genus Ornithodoros could transmit the virus.136, 265 The discovery in Europe of the role of Ornithodoros erraticus in maintaining the virus in rustic pig shelters in south-western Spain gave rise to further investigation in Africa.502 and it was demonstrated unequivocally that Ornithodoros ticks are vital for the persistence of ASFV in its natural environment in Africa and are intimately involved in the transmission of the disease.453, 454, 456, 458
The taxonomy of Ornithodoros moubata complex ticks in Africa is likely to be resolved by molecular genetic studies like those applied to the O. erraticus complex in West and North Africa.549 However, the nomenclature proposed in a study on O. moubata published recently in South Africa is complicated and difficult to relate to existing studies involving ASF,39 so for the purposes of this chapter the terms O. moubata s.l. (sensu lato ) or eyeless tampans, a term commonly applied, are used.
Ornithodoros moubata s.l . ticks have been demonstrated to be biological vectors in which ASFV replication occurs and infection can be maintained independently of the vertebrate host; it has been suggested that ASFV evolved from a tick-associated virus.84, 356 The virus is transmitted transovarially, transstadially and sexually in the ticks456, 457, 459 Infection of O. moubata ticks in warthog burrows with ASFV occurs naturally in adults and all nymphal stadia.459 Rates of infection in ticks collected from animal burrows in many localities in East and Southern Africa ranged from 0,02 per cent in western Uganda to 5,1 per cent in the Livingstone National Park, Zambia. In general, however, infection rates lie within the range 0,3 to 1,7 per cent.459 Rates of infection increase slowly with each developmental stage but with an abrupt increase, usually six-fold, between the last nymphal stage and adults.459 Females have markedly higher infection rates than males.459 These observations may be due to a combination of the increasing size of blood meals at successive feedings and, in the case of adults, the ability of infected male ticks to transmit the virus to females during copulation.453, 454, 456, 545 Infection rates did not vary seasonally in one limited study undertaken in the Limpopo Province of South Africa.544
The minimum dose of virus required to infect ticks ingesting viraemic blood varies with both the strain of virus and the origin of the tick, the range being 101 to 104 HAD50 .136, 458, 544 Experimental studies in which four virus/ tick combinations from southern Africa were used have shown that, following ingestion of infected blood, the first tick cells to become infected are phagocytic digestive cells of the midgut epithelium, in which replication occurs, followed by movement of the virus into the haemocoel and generalization to other tissues.289 This was followed by secondary replication in haemocytes, connective tissue, coxal glands, salivary glands and reproductive tissue. Replication in the midgut epithelium was found to be an essential first step in enabling generalized infection of the tick and transmission of virus to the vertebrate host.291 Replication in reproductive tissue supports previous findings that suggested transstadial and sexual transmission, namely infection in 0,15 per cent of unfed first-stage nymphae and venereal transmission from males to females at high frequency (c.88 per cent) in laboratory ticks, probably through transfer in the sac-like exospermatophore at copulation.456, 459 Viral titres were consistently highest in salivary glands and reproductive tissue, and coxal glands were also found to be a prime site of infection, with coxal fluid more often containing virus than salivary secretions.289 It is likely that fluid excreted by the coxal glands is a factor in viral transmission because it frequently contaminates the bite-wound left by engorging ticks.289
Interaction between soft ticks, ASFV and domestic pigs is not yet well understood. It has been shown that salivary gland extract has a synergistic action when co-inoculated with ASFV.57 Hyperthermia and macrophage recruitment were enhanced compared with pigs inoculated with only ASFV. The Langerhans cell density was decreased when tick saliva was co-inoculated and the local spread of the virus is delayed compared with animals receiving only ASFV inoculation.
No obvious effect on mortality rate has been found in infected ticks.289 Furthermore, the relatively constant and high levels of viral maintenance in infected ticks suggests co-evolution with the virus that has resulted in adaptation of virus replication such that it is compatible with host survival.84, 289 It is known that some species of Ornithodoros can live for 15-20 years.330 There is little information on the length of time that ASFV will remain infective after a blood meal. Limited laboratory investigations succeeded in transmission to pigs by O. erraticus for four months502 and by O. savignyi 50 - 106 days after the last blood meal,348 but it has recently been demonstrated that O. erraticus can maintain the infection for at least five years without replenishment.68
Common warthogs have a wide distribution over most regions of sub-Saharan Africa apart from deserts and tropical forests, although habitat fragmentation has resulted in their being largely restricted to protected areas.380 The IUCN lists it as native to the majority of countries in sub-Saharan Africa, but possibly extinct in the Republic of Congo.( http://www.iucnredlist.org/details/41768/0 ) Warthog-associated Ornithodoros moubata s.l. is widely distributed in the savannah regions of Southern and East Africa from 16 °N (Eritrea) to 34 °S (South Africa) but is apparently absent from West Africa, where an extensive survey found no species of Ornithodoros south of 13 °N.549 A report of O. porcinus from a warthog burrow in Sierra Leone in 1964 seems improbable.574 A survey in Senegal found ASFV positive O. sonrai in or near pig pens at localities north of 13 °N but not in warthog burrows, and no ticks were found at a locality south of 13 °N.162, 567 A survey carried out from 1985 to 1988 failed to reveal the presence of ticks of the O. moubata complex in Cameroon.152 There is a report of a single nymph collected from a common warthog in Central African Republic.553 In the absence of the tick vector the classic sylvatic cycle between warthogs cannot be completed.
Infestation of warthog burrows, even in areas where they occur, is not universal and a number of localities where they do not occur have been identified.459 Warthogs in such areas are, in general, free of infection with ASF viruses. In north-central Kenya, however, examination of 118 burrows at altitudes greater than 2 000m revealed no argasid ticks although a high proportion of warthogs in the area had antibodies to ASFV.425, 450 Similarly, although sero-positive warthogs were reported in the Lengwe National Park in Malawi, ticks were not found there in a brief search.252, 254 How the virus is transmitted in such tick-free areas remains to be explained, but as O. savignyi , with a wide distribution in Africa similar to that of O. moubata but occupying a different ecological niche, lives in loose soil under trees where its preferred hosts, large mammals, might rest, it has been suggested that this species might act as an alternative vector.348 The finding of two different genotypes of ASFV, one from warthogs and the other from Ornithodoros inhabiting warthog burrows at a single geographic location in Kenya was reported recently.199 It was, however, not known whether the free-ranging warthogs sampled had any association with the burrows that were investigated. The recent finding of a new genotype of ASFV from outbreaks in domestic pigs in Ethiopia, where two species of warthog occur,125 requires further investigation.3 Increased pig farming activity in interface areas where the warthog-tick cycle occurs is likely to increase the number of outbreaks in pigs, as has been reported in the Gorongosa National Park in Mozambique.468
The proportion of burrows infested and the numbers and stages of the tick found in individual burrows varies considerably, depending at least partly on the age and frequency of use of the burrow.459 This means that ticks may be difficult to detect even by the extensive examination of soil excavated or ‘vacuumed ’from burrows. In East Africa, second and third-stage nymphs constituted over 70 per cent of ticks recovered from burrows and more than 30 000 were found in one burrow,425 but usually burrows contain lesser numbers of ticks.
A practical consideration of how ASFV is transmitted from warthogs to domestic pigs has been the fact that eyeless tampans are rarely found on the host, as they feed rapidly and drop off, spending most of their time in the burrows. However, surveys of ectoparasites of warthogs in both Namibia and north-eastern South Africa revealed that O. moubata nymphs travel on warthogs, sometimes in large numbers.70, 268, 269, 459
Neither warthogs nor bushpigs suffer apparent ill effects following infection with virulent ASF virus apart from a possible fever in bushpigs.19, 362, 547 Microscopic lesions (apoptosis in lymphoid tissue) that resulted from experimental infection in bushpigs indicated that minimal pathologic damage occurs in these animals and ASFV replication in lymphoid tissue is kept in check.410 Lesions in lymphoid tissues apparently associated with ASFV infection were also detected in the warthogs infected experimentally.547
The extent of involvement of eastern bushpigs (Potamochoerus larvatus ) and Red River hogs (P. porcus ) in the epidemiology of ASF has not been determined. A possible role for the eastern bushpig has been investigated since the disease was first described,19, 296, 362, 387, 410, 459, 531 To date, although it has been established that transmission from bushpigs to domestic pigs is possible,19 none of the investigations have demonstrated the existence of a cycle in which bushpigs play a dominant role in infecting domestic pigs.
Compared with warthogs little information is available about ASFV infection rates in bushpigs, but where this has been investigated the infection rate was reported to be low in Kenya and Uganda136, 531 and 10 times lower than that found in warthogs in the same area in South Africa.329 No evidence of ASFV infection was found in lymph node, spleen and serum samples from a small number of bushpigs investigated in the endemic area of Malawi.250 Surveys in Kenya and Zimbabwe and in Madagascar after the outbreaks of ASF there in 1998 failed to find seropositive bushpigs.19, 136, 490 The presence of estern bushpigs in Madagascar is probably due to an introduction.490 In a limited survey in an area in Madagascar where O. moubata s.l. ticks have been found in pig sties and contact between bushpigs and pigs has been reported by farmers, 27 bushpigs sampled were negative for both ASFV and antibodies to ASFV as well as for antibodies to salivary antigens of ticks, and an association between bushpigs and eyeless tampans is in any case as unlikely in Madagascar as it is elsewhere.475, 490 However, viraemia in approximately six-month-old bushpigs was shown to be in the region of 5 and 7 log10 HAD50 /ml of blood when measured 5, 10 and 15 days after experimental infection.410 This is higher than in experimentally infected warthogs of approximately the same age where the levels of viraemia were only in the region of 3 to 4 log10 HAD50 /ml.547 Therefore, although virus titrations performed in different laboratories are not directly comparable, the levels of viraemia developed by bushpigs soon after infection appear significantly higher than in warthogs and are more than adequate to infect O. moubata ticks feeding on them. On the other hand, the circumstances under which bushpigs would regularly encounter these ticks are limited, since bushpigs do not occupy burrows but shelter in dense vegetation, where they may build nests from piles of grass and other foliage.280, 490
Another difference between the behaviour of ASFV in warthogs and bushpigs is that, unlike warthogs, experimentally infected bushpigs were able to transmit the virus to susceptible domestic pigs in contact with them.19 This may be a reflection of the greater levels of viral replication that seem to occur in bushpigs. However, inexplicably, bushpigs exposed to acutely infected pigs that are known to excrete large quantities of infective virus, failed to become infected.19 A recent study in Uganda suggested that direct contacts between domestic pigs and wild suids at the interface with the Murchison Falls National Park, where both bushpigs and warthogs are present, were likely to be unusual, but indirect contacts of various types occurred more regularly and could pose a risk of transmission of ASFV.296
There is a single record of isolation of ASFV from a giant forest hog (Hylochoerus meinertzhageni ) but the distribution of this species is much more restricted than warthogs and bushpigs.264 Furthermore, giant forest hogs live in montane forests and adjacent grasslands where pig-keeping is uncommon, and therefore they are unlikely to be a regular source of infection for domestic pigs and thus unimportant in the maintenance of the virus.280 Nevertheless, a recent model developed to identify regional risk factors for ASF in West and East Africa found a significant correlation between the distribution of giant forest hogs and ASF outbreaks in East Africa.273 However, the authors admitted that owing to the lack of a connection between giant forest hogs and domestic pigs it might be necessary to postulate other wild suids acting as an intermediary for transmission of the virus. The inference that giant forest hogs play an important role in the epidemiology of ASF in East Africa therefore remains improbable. To provide more convincing evidence of giant forest hog involvement, studies to establish the level of contact between giant forest hogs and domestic pigs as well as other wild suids, similar to the study undertaken in Uganda for warthogs and bushpigs,296 would need to be undertaken.
There have also been concerns about possible establishment of a sylvatic cycle involving wild suids becoming established in West Africa, where both warthogs and bushpigs occur. However, in spite of reports of detection of ASFV DNA involving a single warthog and a single bushpig in Nigeria,317, 318 probably due to spillover from domestic pigs,414 the absence of Ornithodoros from the region south of 13 °N is against this.152, 162 The distribution of the ticks may alter due to climate change, which is predicted to have effects on the distribution of vectors and the pathogens that they transmit.340
Expansion or contraction of established sylvatic cycles is also possible. An investigation of infection in Ornithodoros moubata s.l. ticks collected from warthog burrows in an area extending for 20km on either side of the border of the ASF control zone in four main provinces that contribute to the zone (Gauteng, Limpopo, Mpumalanga and North West) revealed that no significant changes in status had occurred since the control zone was established in 1935.321 However, in northern KwaZulu-Natal Province, which is included in the control zone on the basis of very low infection rates determined in warthogs and Ornithodoros ticks from warthog burrows,459 a recent investigation of warthog burrow ticks in the Mkuze Game Reserve where the previous survey was done failed to detect any ASFV.33
Probably owing to the existence of the warthog-tick sylvatic cycle in Africa and a degree of confusion about bushpigs being part of that cycle,204 concerns have been raised about possible maintenance of the virus in an association of wild boars with Ornithodoros , although such an association has never been reported.447 The results of a serological survey undertaken in wild boars in Germany confirmed that a wild boar-tick cycle was unlikely.447 Wild boars, like bushpigs, do not inhabit burrows so that frequent contacts with soft ticks are improbable.187, 280, 330
Domestic cycle involving Ornithodoros ticks
A cycle between domestic pigs and eyeless tampans has been documented in the Iberian Peninsula and Malawi.88, 252-254, 439
In the Iberian Peninsula, the presence of large numbers of Ornithodoros erraticus in pig shelters in the south-western areas where free-range husbandry systems were common was observed and laboratory confirmation of infection with ASFV and the ability to transmit it during feeding was soon obtained.502 Many factors were present that favoured persistence of ASFV in Spain and Portugal, but research in the Spanish province of Salamanca, one of the last to be free of ASF, suggested that the importance of the ticks in the maintenance of the virus may have been underestimated.439 Although rodent burrows are the main habitat of O. erraticus over most of its range, traditional pig shelters that offer suitable microhabitats in the form of cracks and crevices were the preferred habitat, with pigs as the preferred host, in the southern and central parts of the Iberian Peninsula.66
In spite of ASFV persistence in Sardinia since its incursion in 1978, investigations in Sicily have failed to provide evidence of any involvement of Ornithodoros ticks, which were considered to be absent.371, 585 Recently single specimens of an eyeless tampan, O. maritimus , were found at two localities on the main island,180 but although, like other species of Ornithodoros that have been investigated, O. maritimus is likely to be a potentially competent vector of ASFV, its association with seagull nests in rocky coastal settings without pigs and its apparent rarity would support the findings of a survey based on serology and a search of pig shelters that an association between Ornithodoros ticks and pigs in Sardinia is improbable.375
In Africa, investigations in Malawi demonstrated the existence of an ASF endemic area in western central Malawi, mainly in the Mchinji District.250, 251 No warthogs were present in the area, and bushpigs sampled were not infected with ASFV. However, a survey for O. moubata ticks in pig shelters revealed more infested shelters in the endemic area than elsewhere in the country, some of the ticks having high titres of ASFV.252, 254 An in-depth study of O. moubata from pig shelters in three villages in the Mchinji district of Malawi shortly after an outbreak of ASF found that 24 per cent of the ticks contained virus and 100 per cent of the pigs had antibodies to ASFV.253 The Mchinji district is adjacent to the Eastern province of Zambia and the Ang ónia district of Mozambique ( Figure 6b ), both of which are characterised by endemic ASF, but to date the presence of O. moubata associated with pigs has not been confirmed in either area.432, 590
Elsewhere in Africa, specimens of Ornithodoros collected in or near pig sties in Madagascar, Mozambique, Senegal and Zambia have also been found positive for ASFV.468, 476, 567, 590 In Madagascar the ticks were found only at a single pig farm, but ASFV was detected by PCR in 13 out of 182 ticks although there had been no pigs on the premises for at least four years.476 The sequencing results appear to have been erroneous, as they suggested that the virus belonged to genotype I, which has never been reported from Madagascar. Two out of 20 pig premises examined in Mozambique were infested with Ornithodoros moubata s.l . ticks that tested positive for ASFV; both premises were situated in the buffer zone with the Gorongosa National Park, where large numbers of warthogs occur.468 Pigs are not the primary host of Ornithodoros sonrai in Senegal, but a low percentage of the ticks found in rodent burrows in or near pig sties tested positive for ASFV. The authors concluded that any role of the ticks in the epidemiology of ASF in Senegal would be minor, since the ticks are absent from the endemic area, which lies south of 13 °N.162, 567
The introduction of ASF into new areas, changes in pig production patterns and intensity and increased interaction at the domestic/wildlife interface potentially results in the establishment of one or more of these cycles where they did not previously exist. One example of this is the domestic pig-tick cycle that was established in the Iberian Peninsula, where a suitable pig-associated species of Ornithodoros already existed. Apart from O. moubata s.l . and O. erraticus , other Ornithodoros spp. (e.g. O. savignyi from Africa, O. coriaceus and O. turicata from the USA and O. puertoricensis from the Caribbean) have also been infected experimentally with ASFV and demonstrated to be able to maintain and transmit the virus when feeding on pigs.85, 155, 156, 238, 261, 348 Although all these ticks were successfully infected and remained so for significant periods, they generally, in contrast to O.moubata , had higher mortality rates than uninfected cohorts.155, 238, 261, 348 The introduction of the virus into the Caribbean region sparked fears that local Ornithodoros species might become involved in a domestic pig-tick cycle. However, a prerequisite for establishment of the pig-tick cycle is that pigs should be the preferred host of the ticks, which was not the case in the Caribbean, similar to the situation observed for O. sonrai in Senegal, although in both areas exposure to pigs could or, in Senegal, demonstrably did occur and therefore a minor or incidental role in transmission of ASF was possible.85, 567
Species of Ornithodoros are known to exist in some of the recently infected areas, for example the Caucasus, but have never been reported from central and northern Europe.447 Although pig farms with modern housing are unlikely to offer suitable habitats for Ornithodoros ,66 smallholder farms with less adequate housing in parts of Eastern and Central Europe might provide suitable conditions for the establishment of a domestic pig-tick cycle. However, a recent assessment has suggested that as the presence of eyeless tampans, which are generally found in more temperate climates, has not been confirmed in the Baltic states establishment of a pig-tick cycle in those countries is unlikely.182
Maintenance of the virus in domestic or feral pig (Sus scrofa ) populations
With the spread of ASF to other regions from eastern and southern Africa, circulation of the virus in domestic pig populations without the help of the natural hosts or vectors has become by far the most common maintenance cycle for ASFV.239, 428 Furthermore, expansion of pig production in eastern and southern Africa has resulted in this cycle becoming more important than the sylvatic cycle in most countries in those areas as well.370, 434 The cycle depends on a sufficient level of contact amongst sufficiently large numbers of susceptible pigs with access to a continuously available source of infection. Anthropogenic activities and the way pigs are managed are the major driving force for the cycle, but a number of other factors contribute to the persistence of ASFV in pig populations, without which the cycle could not exist. These include the virulence of the virus, the ability of the virus to persist outside the host in suitable environments, and the way in which individual pigs or pig populations respond to infection with ASFV.239 Prolonged circulation of the virus is enhanced by the extension of the epidemic into a susceptible population of free-ranging wild boars whose activities cannot be managed in the same way as those of domestic pigs.208
Since the mid-1990s it has become increasingly apparent that ASF has major effects in Africa, particularly in humid tropical and subtropical areas where beef production is difficult and pork provides a major source of protein in the diet of people. Furthermore, in many countries in Central and West Africa where warthog-tick cycle is not present, as well as in some parts of East Africa, ASFV is endemic in pig populations. Either documented or circumstantial evidence exists for endemicity in domestic pigs in Angola, Benin, Burkina Faso, Cameroon, Cape Verde, Congo Republic, DRC, The Gambia, Ghana, Guinea Bissau, western Kenya, Madagascar, Malawi, Mozambique, Nigeria, Senegal, Tanzania, Togo, Uganda and Zambia, and appears likely to exist in Burundi and Rwanda as well.81, 162, 249, 250, 307, 352, 404, 429, 434, 468, 543 These endemic situations mostly persist independently of the presence of wild suids and, at least in West Africa, argasid ticks as well.
Domestic cycles depend on husbandry systems, trade patterns and networks, as well as the density and contact level of the domestic pig population, and these may change over time. Recent outbreaks of ASF on the northern border of Namibia with Angola, on the north-eastern border of Zimbabwe with Mozambique, and in the free area in South Africa presented a different pattern from the sporadic point outbreaks affecting single herds with proven or likely warthog contact that characterised Namibia, South Africa and Zimbabwe in the past, and they persisted for longer periods and affected larger numbers of pigs.210, 559, 572 Increased interest in pig production by smallholder farmers, with many new entrants to the sector producing more pigs, often in conditions of low biosecurity, has resulted in markedly increased numbers of pigs in several African countries, notably Burkina Faso, Mozambique, Tanzania and Uganda, all of which experience a high incidence of ASF.434
In the domestic cycle without ticks, the only primary source of ASFV is an infected domestic pig or wild boar and its derivatives, which include its secretions and excretions and its infected tissues. Live pigs may be infectious for up to 48 hours before developing overt clinical signs of disease, are highly infectious during clinical disease, and if they recover may be infectious for an as yet undetermined period of time that after infection with moderately to highly virulent viruses does not appear to exceed 30 to 40 days although virus or viral genome may be detected, mainly in lymphoid tissues, for longer periods.590, 592 Studies have confirmed that large quantities of virus are present in the blood of infected pigs during clinical disease, but lower quantities have been measured in secretions and excretions, and although those amounts may be sufficient for infection of in contact pigs, it has been suggested that blood contact is more efficient.63 Less information is available about transmission during other stages of infection. Some earlier studies doubted that sufficient virus is shed during the incubation period to infect in-contact pigs.237, 459 Recently, shedding of virus for 24-48 hours before the onset of fever has been demonstrated and quantified; the amount of virus shed in the experiments was variable, sometimes high, and it is probable that whether or not pigs in contact are infected depends on exposure.127
Pigs that survive infection with ASFV may either remain chronically sick or recover fully. Prolonged or intermittent shedding of virus in cases of chronic ASF has been described.135, 136 Such pigs cannot be considered true carriers although survival for up to 465 days has beenreported, because they are not clinically normal and eventually die of ASF.135, 136 Chronic disease has frequently been linked to viruses of lower virulence, but this is not always the case, because it has been observed after exposure to virulent viruses that have caused mortality due to acute severe ASF in the same group of pigs.135, 136 In Africa, the natural occurrence of chronic or mild disease has not usually been a feature of field outbreaks, although strains of ASFV that induce mild disease have been described from South Africa and DRC.530, 546 Chronic forms of the disease were described in Angola in which few or many survivors were observed, usually in poor condition, febrile, coughing and anorexic, with lesions more typical of classical swine fever such as ‘button ulcers ’at necropsy.188, 561 It is likely that mild or atypical forms of ASF would not be diagnosed as such under the conditions in which most pigs are farmed in Africa, but most of the African viruses studied in laboratories have proven highly virulent.
In the first extensions of the disease outside the African continent after the virus spread in Europe subsequent to its second introduction into Portugal in 1960, cases of ASF were often acute and fatal at first but thereafter the severity of the disease diminished rapidly as the outbreaks spread until finally the cases were predominantly subclinical.248, 260 In some places, such as Malta, mortality remained high, although Maltese isolates have produced variable mortality in pigs exposed experimentally.130, 593 The degree to which the variation in pathogenicity in those non-African outbreaks of ASF may be attributed to the large-scale release of vaccine strains attenuated by passage in cell cultures in the early 1960s is debatable.259, 260, 328, 509 As a DNA virus, ASFV tends to be highly stable in terms of its biological characteristics, and there is little evidence for natural loss of virulence over time, while there is clear evidence of stability in spite of minor genetic changes at the molecular level. The genotype II virus that has been circulating in Eastern Europe for the last 10 years has had a field presence of at least 20 years in Africa without any observed significant loss of virulence,64, 357, 391, 526, 559 although recently variants of lower virulence have been reported from Armenia and Estonia.198, 203, 513 Three closely related genotype I viruses that caused outbreaks in Senegal, Angola and C ôte d ’Ivoire in 1959, 1970 and 1996 respectively proved lethal in pigs in 1996 after a field presence of 37 years.445
Although infection with virulent or moderately virulent ASF viruses has often resulted in 100% mortality, this is by no means always the case, and in almost any pig herd or population there may be pigs that appear to have a natural resistance to the disease.432 In endemic areas in Africa, populations of pigs with no signs of ASF but a moderate to high rate of seropositivity, sometimes more than 50%, have been reported, as well as a high rate of PCR positivity without clinical signs or antibodies.35, 250, 251, 394, 432, 543, 555 As these have largely been field observations it is generally not known when the pigs had been exposed to the virus or how they initially responded to infection. Pigs from such a population in Mozambique either developed acute lethal ASF and died or showed at most transient fever and the only indication that infection had occurred was seroconversion.432 The duration of shedding post infection and persistence of virus in the tissues of such pigs is largely unknown but is probably similar to the period of up to 30 days described by Wilkinson et al.592
Determining for how long fully recovered, clinically healthy pigs remain ‘carriers ’that are able to transmit ASF virus is more difficult, as at least under experimental conditions few pigs recover from infection with virulent viruses. Experimental infection of pigs with a non-pathogenic virus (NH/P68) originally isolated from Ornithodoros erraticus when ASF was endemic in Portugal demonstrated the ability of infected pigs to transmit that virus to in-contact pigs for at least three months post-infection.202 The virus used was shown to be genetically most closely related to vaccine viruses that were disseminated in the same area during the epidemic in the 1960s,462 so it is unclear how often such a virus would occur under natural conditions. The experiment is nevertheless informative, suggesting that pigs that remain clinically normal or become clinically normal after recovery from infection with viruses of low virulence may be able to transmit the virus for longer than pigs infected with viruses of higher virulence. This may be due to more rapid clearance of virulent virus from the blood and oronasal fluids, as has been described for the highly pathogenic strain of porcine reproductive and respiratory syndrome (PRRS) virus ‘Lena ’that emerged in Belarus.287, 363 Pigs experimentally infected with a moderately virulent virus (Malta/78) were able to transmit virus to in-contact pigs for up to but not after 30 days although infectious virus could be isolated from tonsil and certain lymph nodes up to but not longer than 6 months post-infection.593 In recent studies using high and low doses of the same virus viraemia and shedding from the oropharynx was demonstrated for at least 70 days post infection, but after 30 days comparatively lower amounts of virus were shed with lower frequency and the design of the experiment did not enable demonstration of transmission to pigs by contact in the later stages.127, 128 The only recent experimental study designed to examine the potential for surviving pigs to transmit the virus to in-contact pigs and wild boars, using the moderately virulent Netherlands 86 isolate, provided no evidence for such transmission.444 Serological surveys carried out in Spain and Portugal to detect carriers during the eradication process found a low percentage of antibody-positive pigs but in two of the surveys no virus could be isolated from the blood samples,466, 467, 568 while another survey reported that virus was detected in only 4.4 per cent of seropositive pigs from 61 farms.54 The source of the virus detected (blood or internal tissues) was not specified, but the authors concluded on the basis of epidemiological evidence that seropositive survivors on farms that experienced ASF did not normally serve as the source of further outbreaks.54 In Africa, evidence from an experiment in which a seronegative pig was added to a group of seropositive pigs six weeks after they had survived an outbreak of ASF in which two highly virulent ASF viruses were involved suggested that they were no longer infectious, as the sentinel remained seronegative in spite of being in close contact with the seropositive pigs, including servicing all the sows, for a period of three years.51, 432 Nevertheless, elimination of seropositive pigs has been described as having been essential for the success of the eradication programme in Spain,32 so importance of long-term carriers in maintenance and spread of ASFV continues to be debated.
The ability of the virus to persist in tissues of pigs that have died of ASF for extended periods of time is beyond doubt, although exact periods of survival have only been established scientifically for certain meat products.343, 345, 443 The most widely quoted survival periods for ASFV where no published figures exist are derived from a risk assessment for the introduction of four viruses (including ASFV) via illegally imported meat into Great Britain.4 Those figures are simply estimates based on a number of assumptions that may or may not have been accurate, but they are not derived from the published results of scientific investigation. For example the infectious period for ASF in a pig was estimated to be 230 days, which is well beyond any published estimates for healthy pigs likely to be slaughtered for consumption. The survival period for ASFV in frozen pork was estimated to be 1000 days with the authors stating clearly that this was simply an assumption but it now appears to be accepted wisdom and should certainly be confirmed by scientific investigation.152, 377 However, the carcasses and tissues of pigs that have died of or recently recovered from ASF should be regarded as potentially infectious if ingested for up to six months post-infection, although at six months only the lymph nodes were found to contain infectious virus, which by seven weeks post infection was present only in lymphoid tissues.593
Wild boars are highly susceptible to both natural and experimental infection and frequently die as a result of such infection.63, 64, 187, 417, 474, 503 Evidence from Spain over more than a 10-year period (1970 –81) during which ASF was endemic in the domestic pig population as well as in the years 1991 –1993 indicated that the disease in wild boar closely paralleled that in domestic pigs.406, 436 A range of clinical manifestations occurred in this species from acute clinical disease to subclinical infection. Furthermore, there was no evidence that wild boars were maintaining the infection. This was confirmed by a survey between 2006 and 2010 in one of the worst affected areas in Spain that yielded only negative samples.372 A serological survey conducted in Sardinia yielded only a low number of positive samples, probably indicating high mortality in infected boars.300 Subsequent detailed studies in Sardinia have supported the probable secondary role played by wild boars in the persistence of ASF in Sardinia,275, 375 but a recent transmission model suggested that in areas with dense wild boar populations this species might be locally important in transmission of the virus,378 which seems to be borne out by the experience of the Baltic states since 2014.74, 75, 208, 302, 391, 392, 447, 465, 596
The first report of ASF in the Russian Federation was from dead wild boars found in Chechnya close to the border with Georgia.213 Early spread in the Russian Caucasus was driven by contacts between wild boars and free-ranging domestic pigs belonging to backyard pig farmers, but the subsequent spread to Central Russia and beyond resulted from movement of infected pig products, sometimes over long distances, swill feeding and ineffective control efforts.213 Studies in the Russian Federation have suggested that ASF has not become endemic in wild boars,301 but virus circulation may be maintained locally in dense boar populations, particularly if there is some contact with free-ranging pigs, similar to the situation in Sardinia.213, 274 An epidemiological analysis of outbreaks from 2007 to 2012 suggested that low biosecurity production systems and anthropogenic factors were major drivers of the epidemic in the Russian Federation and that infection in wild boars most likely resulted from spillover from the low biosecurity pig sector,393 but one study did demonstrate active transmission in wild boars in the apparent absence of outbreaks in pigs.274
While the introductions of ASF into Ukraine in 2012 and Belarus in 2013 were attributed to movements of domestic pigs or pig products, the first cases registered in Poland, Lithuania and Latvia in 2014 were in dead wild boars found close to the border with Belarus.195, 402, 426 The first outbreaks in Estonia occurred in wild boars in September 2014,391 possibly due to extension from Latvia.402 In all four countries outbreaks have continued to occur in wild boars, with only sporadic spillover to domestic pigs. This may be partly explained by expanding wild boar populations in the area and the fact that the majority of domestic pigs are kept in commercial holdings with adequate biosecurity,208 as more outbreaks in domestic pigs have been reported in Latvia, where large numbers of pigs are still kept in low biosecurity backyard systems.402 In Poland, the largest of the four EU countries infected in 2014, ASF remained confined to a single district, with only three outbreaks in domestic pigs, all in backyard holdings, up to mid-2016 in spite of an expanding wild boar population.426, 528, 572 Owing to the far greater number of cases in wild boars, it was concluded that wild boars were the primary host of the virus.528 However, in August and September 2016 outbreaks occurred in domestic pigs in two additional districts, followed by cases in wild boars in the same districts in October and November.572 Cases in backyard pigs in Moldova (2016-2018) and Romania (2017, 2018) were apparently not connected with wild boars, although outbreaks in wild boars have been reported in both countries.572 Bulgaria reported unrelated outbreaks in a backyard holding and in wild boars in 2018.572 In June 2017 cases of ASF in wild boars were reported by Czech Republic, with spread among wild boars; the outbreak was declared resolved in April 2018.572 The affected area was approximately 550 km from the nearest known infected wild boar population, which was in the east of Poland, and therefore anthropogenic involvement was suspected.572 Hungary reported three outbreaks in wild boars in 2018, also suspected to have been due to movement of infected products.572 The westernmost extension of the outbreak to date was reported in wild boars in Belgium in September 2018 close to the border with France.308, 572 This introduction was also only related to wild boars but the very long distance from the Eastern European outbreaks and some legal actions taken locally led to speculation about possible illegal movement of live animals for hunting purposes. ( https://www.pigprogress.net/Health/Articles/2019/2/ASF-Belgium-Now-457-dead-wild-boar-2-men-arrested-392452E/ ; http://www.promedmail.org/post/20190213.6314341 )
Studies have so far suggested that transmission amongst wild boars is slow and occurs over short distances not exceeding approximately 10 km.402, 460, 596 There are ongoing investigations into transmission amongst wild boars because the apparent persistence of the virus in wild boar populations with no reported contact with free-ranging domestic pigs is a cause for concern.181, 274, 279, 302, 446, 447, 465 As stated above, an association with Ornithodoros ticks is unlikely.281, 330, 447 An examination indicated that immature stages of two common blowfly species did not harbour infectious ASFV and would therefore not be relevant as a vector.181 It seemed probable that the carcasses of wild boars that died of ASF might be the most important source of infection for other boars.151 A recent field study demonstrated that at least when sufficient food was available wild boars tend to avoid the carcasses of conspecifics, particularly when fresh or infested by maggots, but that they did root under the carcasses or chew bare bones. The authors concluded that environmental contamination by wild boar carcasses and persistence of the virus in the contaminated area under favourable conditions such as winter temperatures below zero could pose a high risk of infection for other wild boars, which led to the proposal of a wild boar-environment cycle.105, 465
Since the first outbreak of ASF in China was reported in August 2018, the remarkable spread of the disease through the eastern provinces of China and and other countries in the region appears to have been entirely due to movement of pigs and pork as well as contaminated pig feed, although a few cases in wild boar have been reported308, 309, 585 and in 2019 a growing number of cases in wild boar in South Korea have been reported to OIE.
Source of ASF outbreaks
In endemic areas, outbreaks may be initiated by a wide variety of transmission routes that include dangerous contacts with infected domestic pigs and pork, wild suids and ticks, or fomites. These have been discussed in detail above. It should be reiterated that wild African suids are inefficient at transmitting the virus in comparison to domestic pigs or wild boars, and are therefore at best a source of pinpoint local outbreaks that may then be amplified by domestic pigs. The hypothesis that primary outbreaks are initiated by feeding uncooked warthog tissues to pigs14 is not supported by experimental data.362, 459 The most likely explanation is that live warthogs carry infected ticks onto land used for foraging of pigs or that warthog carcasses could do the same for enclosed premises.
Emergence of ASF in areas where it is not endemic, either in or outside the African continent, including across international borders and over long distances, can be ascribed to movement (legal or otherwise) of live pigs, pork used for swill feeding, or contaminated fomites such as transport trucks, which have been identified as posing a high risk in Europe and may have played a role in spread of ASF in isolated island.314, 377 Recent sources of ASF outbreaks in new countries have included incursions by infected wild boars.75, 195, 213, 471 In Africa damage limitation by selling pigs as soon as an outbreak starts has been identified as a source of both local and transboundary transmission.81, 307, 383, 559
Intercontinental transmission of ASFV over long distances has invariably been ascribed to movement of infected pork products that have subsequently been accessed by pigs either through swill feeding or scavenging,260, 366, 494, 495, 520 although the evidence is usually circumstantial. Introduction to island nations has usually been thought to have occurred in the same way.13, 314, 476, 503 The 2014 reintroduction of ASF into C ôte d ’Ivoire in the port city of San Pedro could also be ascribed to pigs having access to galley waste carelessly disposed at a landfill; a similar source of infection has been proposed for the 1996 introduction.120, 294
Molecular epidemiology of ASF
As is the situation with all infections of livestock capable of causing severe losses, it is vital to determine the origin of outbreaks when they occur and to be in a position to monitor the spread of the infection. Molecular methods permit the study of the relationships of outbreak viruses.
Restriction enzyme (RE) mapping of ASFV genomes was the first molecular technique used to group viruses on the basis of differential RE cut sites within the central genomic region, which is approximately 125 kbp in length and conserved across different isolates ( see Aetiology ). Results from these studies indicated a common origin for the viruses introduced into the Iberian Peninsula and from there to the rest of Europe, South America and the Caribbean.62, 583 Within this geographically heterogeneous but genetically homogeneous virus group, only four RE profiles were discerned. All viruses of European, American and Caribbean origin were found to correspond to one of the four possible Sal I profiles, represented by Lis/57, Lis/60, BA60 and BA71,62 the former two isolates being of Portuguese origin and the latter two of Spanish origin. Differences in RE profiles of the 1957 and 1960 Lisbon viruses were confirmed in a separate study.147
Nucleotide sequencing has superseded RE mapping and is now widely used to study ASF viruses and has proven particularly useful in tracing origins of outbreaks and relationships between them. Application of a nucleotide sequencing method to 55 viruses of diverse geographical and species origin identified the presence of at least ten genotypes on the African continent, based on partial p72 gene sequencing.50 The partial p72 sequencing data concurred with RFLP typing, recovering the same major groups and confirming the genetic homogeneity of viruses from Europe, South America, the Caribbean and West Africa (genotype I, the so-called ESAC-WA genotype). In keeping with initial RFLP group designations, the ten genotypes were assigned roman numerals I-X.50 The same study revealed high levels of heterogeneity in central, eastern and southern Africa, where ASFV-infected Ornithodoros tampans are known to occur.51, 453, 454, 544, 545, 590 Multiple (three or more) genotypes have been shown to occur in the DRC, Kenya, Malawi, Mozambique, South Africa, Tanzania, Zambia, and Zimbabwe.50, 51, 77, 312, 313, 358, 369, 469, 525 To date 24 p72 genotypes ( Figure 7b ) have been identified, all of which are present in eastern and southern Africa, with the two most recently identified genotypes emanating from outbreaks in domestic pigs in Ethiopia3 and Ornithodoros moubata s.l. from both warthog burrows and pig pens in the Gorongosa district in Mozambique.469 A phylogeographic analysis based on the partial p72 gene sequences of 22 genotypes identified three major evolutionary lineages (A-C), corresponding to discrete geographical regions in sub-Saharan Africa.312 Clade A incorporates the widely distributed but homogeneous genotype I viruses that occur throughout West Africa, with the basal position of viruses from Zambia confirming an East African origin for the West African virus cluster.312 Seven p72 genotypes were originally assigned to Clade A,viz . genotypes I-VII,50, 312 with a subsequent study with a Southern African focus identifying five additional clade A genotypes (XVII-XXI).77 The 13th genotype shown to cluster within clade A, genotype XXIV, was identified in Mozambique,469 making clade A the most geographically widespread (occurring in Southern, East, Central and West Africa) and genotype-rich clade. Clade B currently comprises of seven genotypes (VIII and XI-XVI) with an East African origin,50, 312 whereas Clade C, which presently incorporates three genotypes (IX, X and XXIII) has the most restricted geographical distribution ( Figure 7a ) of the three clades, so far reported from six countries in East and Central Africa.3, 50, 194, 369
While the first incursions into Europe involved genotype I viruses, the incursion that started in the Republic of Georgia in 2007 and has since spread throughout large parts of Eastern Europe with incursions into some Central European countries, one Western European country and most recently into south-east Asia involves a genotype II virus first identified in Madagascar in 199850, 226 and subsequently from current and historical isolates from Mozambique, Tanzania, Zambia and Zimbabwe.51, 312, 357, 495, 559
The p72 genotyping permitted the conclusion that the 1957 and 1960 incursions of ASF into Portugal originated in a western coastal African country while the 2007 incursion into the Caucasus was due to a virus so far only found in four East African countries.50, 51, 312, 495 To obtain higher resolution that might enable more precise pinpointing of the origin of outbreaks, an alternative method targeting a highly variable repeat region within the 9RL open reading frame of the ASFV genome indicated that this approach may be useful for resolving intragenotypic virus relationships.276 Genetic characterisation of the9RL central variable region (CVR) of geographically diverse ESAC-WA viruses identified 12 discrete sequence groups.445 The results relating to Europe supported the previous suggestion of more than one introduction to Portugal, on the basis of RFLP analysis.147 Furthermore, the presumption that the virus that caused the 1957 outbreak in Lisbon came from Angola, at the time an overseas department of Portugal, was supported by identity between sequences of viruses from these countries.196, 445 Central variable region typing further confirmed p72 genotyping results, indicating that two genetically distinct viruses circulated in C ôte d ’Ivoire during the 1996 outbreak.18, 445 One of these was identical to a historical Senegal isolate and closely related to the virus recovered from the outbreak in Gambia in 2000. The other 1996 C ôte d ’Ivoire virus could be directly linked to subsequent outbreaks occurring in Benin in 1997, in Nigeria from 1998 to 2000 and in Ghana in 2000. Interestingly, viruses recovered from outbreaks in Cameroon in the 1980s were genetically distinct from those occurring in West African countries in the 1990s. Thus p72 genotyping when followed by CVR characterization is an effective approach for determining relatedness of outbreaks and possible sources of infection.313 However, it has been suggested that additional genetic markers are needed to study the evolution of viruses over time, in particular in prolonged outbreaks such as the infection in Eastern Europe, and to discriminate between circulating viruses in order to more accurately pinpoint their origin.195
Further resolution has been obtained by sequencing the p54 gene, which provided enhanced discrimination amongst viruses within the p72 genotype I and revealed identity between outbreak viruses from Kenya in 2006 and 2007 with viruses from 2003 Uganda outbreaks,193 as well as a probable common source for outbreaks that occurred in three Zambian provinces in 2015548 and the identity of a virus from Mbeya in Tanzania in 2011 with the Georgia 2007 isolate.555 Combining p72, p54 and CVR typing permitted confirmation of the discovery of a new genotype (XXIII) with two intragenotypic variants from a small number of ASF outbreaks that occurred in Ethiopia over a three year period, prompting the suggestion that these viruses may have been present in a warthog-tick cycle and were only revealed when the recent development of pig farming in Ethiopia caused a spill-over into domestic pigs.3 Furthermore, the study indicated shared ancestry with the two predominantp72 genotypes in neighbouring Kenya and Uganda (genotypes IX and X), clustering within clade C. The combination of p72, p54 and CVR typing has been used in informative studies in Republic of Congo,194 DRC,369 Kenya,199, 405 Nigeria,315, 414 Sardinia,212 Tanzania,358, 359 Uganda,35, 193 Zambia,525 and Zimbabwe.559 The studies in Zambia and Zimbabwe revealed the presence of a p72 genotype variant identical with the 2007 Georgian virus. The study of viruses from outbreaks in Uganda in 2007 showed that they shared 100 per cent identity with isolates from outbreaks in Kenya in 2007.193 Molecular typing using p72, p54 and CVR of an ASF virus that caused outbreaks around the port city San Pedro in C ôte d ’Ivoire in 2014 confirmed that a coastal West African country was the most likely source of the virus via carelessly disposed catering waste from ships and that the genotype I virus did not cluster with the genotype I viruses isolated from the 1996 outbreaks but was more closely related to viruses circulating in Cameroon.120
The use of the p30 gene and/or variable regions of the ASFV genome other than the CVR region has been described.195, 390, 469, 527 To enable greater discrimination of p72genotype variants that infected the Baltic states of Poland and Lithuania in 2014, p72 and P54 sequencing with CVR typing of viruses from those and neighbouring countries was enhanced by the use of further primers that detected a tandem repeat sequence (TRS) shared among isolates from Poland, Lithuania, Belarus and Ukraine but not with the Russian isolates included in the study. It could therefore be inferred that the infection detected in wild boar carcasses sampled close to the borders of Poland and Lithuania with Belarus may have originated in that country, which had suffered outbreaks in 2013.195 A subsequent investigation revealed the same sequence in Russian isolates that were fairly widespread in Russia from 2011 onwards, including in areas adjacent to Belarus and Ukraine.214 Genetic analysis of an isolate from an outbreak in Siberia in 2017 using a similar approach indicated closer similarity to the Georgia 2007 virus than to most variants circulating in Russia at that time.292 Similar studies have also attempted to discover the source of the introductions into China and Belgium in 2018, but have failed to pinpoint a precise link.207, 209 Studies in Zambia usingp30 sequencing in addition to typing using p72, p54 and CVR provided further information on isolates, in particular of genotype II, from historic and recent outbreaks and were able to disprove a long held belief that all outbreaks in Zambia originated in the endemic area of the Eastern Province, explaining why a ban on movement of pigs and pork from that area had not prevented numerous outbreaks of ASF in the rest of the country.526, 527
Full genome sequencing of a recent isolate from China and comparison with related p72 genotype II viruses isolated from Eastern Europe confirmed a close similarity to those viruses and the potential of the technique to determine relationships and evolution of viruses within genotypes, similar to studies that compared the genomes of two Georgian isolates and of five Ugandan isolates.44, 170, 333, 580 However, the full genomes of seven Polish isolates from domestic pigs in 2016 and 2017 were not sufficiently diverse to enable the origins of field isolates to be traced.338 Nevertheless, the study revealed differences between the original Georgia 2007 virus that triggered the epidemic and the viruses currently circulating in Poland.
The use of p72 genotyping, refined by the addition of p54 and CVR typing, remains a practical approach to determining relationships and potential epidemiological links. Although new classification systems based on or differing from the p72 nomenclature have been proposed and may be informative in terms of evolution of ASFV,14, 356 they are useful for research but similar to full genome sequencing are less suitable for rapid diagnosis.134
To date it has not been possible to correlate molecular genetic variation with biological variation e.g. in virulence, but comparison of complete genome sequences has been suggested as potentially enabling linking genetic characteristics to virulence.134 Comparison of genotype IX and X viruses of different virulence from Kenya suggested that this might be the case.61 Recent research has also proposed a serological classification of ASFV that is not congruent with p72 genotyping but may prove more informative about virulence and also cross-protection for vaccine development. It is, however, is still in a preliminary stage in this respect ( see Immunology ).83, 325, 326
Pathogenesis
In pigs exposed to ASFV shed by infected cohorts, virus is usually first detected in the pharyngeal tonsils and mandibular lymph nodes,178, 236, 237, 587 Exceptions have been described, for example virus was first detected in the lower respiratory tract including the bronchial lymph node in pigs infected by aerosol.588 It was noted, however, that early infection occurred in the tonsils even when pigs were infected parenterally.178 When infection occurs via the tonsils, larger amounts of virus may be detected in the mandibular lymph nodes, suggesting that this may be the site of primary replication.236 Local replication and shedding occur in the oral cavity prior to systemic dissemination of the virus.270 Subsequent spread is haematogenous,111, 262, 455 and an experimental study indicated that this occurred more rapidly after intranasal inoculation of a virulent ASFV than in pigs inoculated by the intramuscular route or by direct contact.270 Viraemia in acute cases of ASF often reaches 108 HAD50 / ml and the virus is strongly cell-associated, with whole blood samples containing almost two log10 more virus than serum due to most of the virions being bound to erythrocytes or present in leukocytes.270, 571, 578, 587 Virus is predominantly associated with erythrocytes,455 which may contain more than 95 per cent of the circulating virus.211, 578 Virions have been demonstrated on indentations of the membrane or within erythrocytes.484, 582
Replication takes place primarily in mononuclear phagocytes, namely monocytes and fixed-tissue macrophages.78, 176, 222, 270, 364, 367, 472, 473 with a predilection for the antigen-presenting cells of the macrophage-mononuclear system.234, 486 An interesting demonstration of the infection of dendritic macrophages of the Langerhans type by ASFV is the effect that prior ASFV infection has on subsequent exposure of pigs or dendritic cell cultures to foot and mouth disease virus (FMDV). Both in vivo and in vitro , ASFV is able to prevent or at least reduce the capacity of FMDV to cause infection, showing that both ASF and FMD viruses infect the same cell type.233, 235
Entry into macrophages can apparently be effected in various ways that are not yet fully understood ( see Aetiology ).10, 190 After entry into the host cell virus particles enter the endosomal pathway and after undergoing decapsidation in mature endosomes the naked virions enter the cytosol, where they are transported by microtubules to the replication sites near the nucleus.189 Replication occurs in ‘viral factories ’, where the virions are associated with ribosomes.219, 501 Mature virions produced in the viral factories leave the cell by budding at the plasma membrane or via apoptotic bodies.189
Various mechanisms have been described that enable replication and dissemination of ASFV after infection of a suitable host. Studies of the effects of the virus in particular organs and tissues, in particular lymph nodes, spleen, lung, liver, kidney and bone marrow have demonstrated markedly increased numbers and/or activity of macrophages.97, 98, 219, 223, 224, 497 Viral antigen could be detected in monocytes in the liver from the third day post infection, but the numbers of circulating sinusoidal monocytes and Kupffer cells expressing TNF-a, IL-1a and IL6 increased significantly from the first day, suggesting the existence of a viral mechanism to attract cells suitable for infection.507 Elevated levels of the chemokine CCL2 after infection with virulent ASFV are known to cause monocytic phagocytes to be attracted to the infected area,179 providing more host cells for the virus.
Mechanisms have been described that prevent death of the macrophages before replication has been completed and that suppress the immune response to infection. Marked lymphopenia is a consistent feature of ASF and was at first believed to be the result of viral replication in lymphocytes, but this has been disproven.178, 411 The detection of ASF viral genome in a low number of T cells using a highly sensitive probe does not provide proof of replication and is unlikely to be significant in terms of the disease.41 There is, however, widespread destruction of both T and B lymphocytes,411 which is characterized by apoptosis (programmed cell death) believed to be precipitated by proinflammatory cytokines, in particular tumour necrosis factor-α(TNF-α) and interleukins (IL-1a and IL-6), released from infected macrophages.145, 216, 222, 411, 472, 497, 498 Another chemokine expressed in macrophages, CXCL10, also increased markedly in blood after infection with a highly virulent ASFV isolate and is associated with apoptosis of bystander lymphocytes.179 Severe apoptosis of thymocytes associated with increased numbers of activated macrophages has been described in pigs affected with acute ASF but was not considered to contribute significantly to the course of disease.499
Conversely, ASFV also contains several genes that encode proteins, e.g. p21, known to inhibit apoptosis.5, 411, 463, 479 In order to achieve productive replication followed by release and spread of the virus, death of the cells in which replication is taking place must be prevented before completion of replication, after which cell death facilitates the release of the virions. An in vitro study of apoptosis caused by ASFV in macrophages indicated that although viral entry into the cell rapidly triggered the signal for apoptosis, the processes leading to apoptosis occurred close to conclusion of replication.463 One of the anti-apoptotic factors, p21, may also facilitate establishment of persistent infection.5 Based on detection of viral DNA in monocytes/macrophages by PCR for more than 500 days following infection, it is possible that some macrophages, rather than dying, become persistently infected by virulent viruses. Intact virus, however, could not be recovered from these macrophages.103 Viral recovery from lymph nodes of pigs infected with a virus strain of medium virulence was only achieved for a period of 48 days following infection.411 The pro- and anti-apoptotic factors produced by ASFV have recently been reviewed.145
As the disease progresses, with destruction of large numbers of macrophages, viral replication may take place in other cell types, including endothelial cells, pericytes, glomerular mesangial cells, renal collecting duct epithelial cells, hepatocytes, neutrophils and megakaryocytes.176, 219, 221, 223-225, 591, 601 The effects of replication in cells other than macrophages are considered to be limited, particularly in acute disease caused by virulent ASFV, and probably do not contribute significantly to the outcome of the disease, but the presence of virus in immature neutrophils released into the bloodstream probably increases haematogenous dissemination.219 Infection of pigs with virulent ASF viruses results in an acute phase response with variably increased serum levels of C-reactive protein, serum amyloid A, haptoglobin and pig major acute phase protein, with decreased apolipoprotein A-1.63, 96, 506 Induction of the acute phase response in hepatocytes is mainly the result of activation by proinflammatory cytokines such as TNF-a and IL-1, with Kupffer cells playing an intermediate role.63, 506 The subsequent manifestations of the disease are generally agreed to result from the release of active substances such as proinflammatory cytokines rather than any direct effects of virus.63 In a study of blood parameters in pigs infected with a moderately virulent virus, high levels of IL-10 were observed in pigs that survived the infection, possibly due to its anti-inflammatory effects.464
One of the most striking observed effects of ASFV is haemorrhage in multiple organs. Widespread effusion and haemorrhage in acute ASF are attributed by most authors to increased vascular permeability and disseminated intravascular coagulation.63, 98 In earlier studies vascular damage was attributed to replication of the virus in endothelial cells.63 This was supported by some in vitro studies that described replication of ASFV in porcine aortic endothelial cells shortly after infection.558, 591 Early surface expression and mRNA transcription of tissue, which is important in initiating the coagulation cascade, was observed within four hours of infection of the cells with a virulent ASFV virus.558 However, the majority of studies have indicated that replication in endothelial cells in vivo takes place later in the course of infection than the initiation of haemorrhages, or not at all.20, 63, 219, 222-224, 569 It is now generally accepted that the activation and eventual massive destruction of macrophages plays a major role in impaired haemostasis owing to the release of active substances including cytokines, enzymes, complement factors and arachidonic acid metabolites.20, 221, 486 Haemorrhages, particularly in lymph nodes, appear in the earliest stage of the disease while macrophages that are activated by viral replication are still intact.98 The initial vascular changes are therefore probably induced by pro-inflammatory cytokines like TNF-a and IL-6, which are known to have a procoagulant effect on endothelium that results in activation of the clotting cascade.63 The most important vascular changes leading to death are thought to result from the effect on endothelial cells of mediators, including prostaglandin E2, released by the infected macrophages undergoing apoptosis,20, 224, 231 that cause activation of the clotting cascade and disseminated intravascular coagulation. Impairment of prostacyclin production by endothelial cells has also been reported.20, 224, 231 The increased levels of these mediators are produced under the influence of TNF-α.231
The cause and role of thrombocytopenia, which is a frequent but not inevitable component of the disease, has been extensively debated.20, 150, 219, 486, 569 Thrombocytopenia has been attributed variously to loss of platelets due to aggregation or destruction and to failure of thrombocytopoiesis.63, 149, 220, 221 Failure of thrombocytopoiesis has been attributed to direct effects of virus replication in megakaryocytes or destruction of megakaryocytes by structural alterations and apoptosis induced by cytokines released by macrophages in bone marrow.220, 486 Investigation of the effect of ASF on platelets ruled out direct infection of platelets as a cause of thrombocytopenia, as only a small number contained virus.220, 486
After experimental infection with a virulent strain of ASFV, only slight thrombocytopenia was observed at a later stage of infection, after haemorrhages had developed and when some of the affected pigs had already died.569, 570 In subacute ASF caused by inoculation with a moderately virulent strain, pigs developed intense transitory thrombocytopenia in the early to middle stages of disease.569, 570 Therefore, severe thrombocytopenia seems to be related to the prolonged course of disease caused by viruses of moderate to lower virulence, and may be mild or absent during acute and rapidly fatal disease.569, 570 However, an immediate but transient fall in thrombocytes after infection of pigs with both virulent and moderately virulent strains of ASFV has been reported.20
A study of the effects of infection with virulent ASFV in bone marrow indicated that activation of macrophages was followed by early replication in monocytes/macrophages and their precursors, reticular cells and immature neutrophils.219 Replication in megakaryocytes, endothelial cells and pericytes was detected two days later, but replication occurred in only 5 per cent of megakaryocytes. Thrombocytopenia did not occur in spite of disseminated intravascular coagulation, indicating that production of thrombocytes was not significantly impaired. The level of infection of megakaryocytes may, however, depend upon the virulence of the strain of virus and length of survival of the pigs. Infection of larger numbers of megakaryocytes has been reported in studies using a viral strain of moderate virulence.435, 486 However, the intense transient thrombocytopenia induced by infection with a moderately virulent strain was associated with the appearance of apoptotic megakaryocytes.569, 570 The destruction of the megakaryocytes was attributed to pro-apoptotic cytokines released by macrophages rather than a direct effect of replication in the megakaryocytes,220, 221 which appears only to become important when the course of disease is protracted, if at all.221, 435, 486
Peripheral platelet consumption has been attributed either to direct or indirect effects of the virus on the vascular epithelium that activate the clotting cascade or to an immune-mediated process involving complexes of ASF antigen and antibody that cause aggregation of platelets.149 The observation that the platelet count in experimental infection fell before endothelial damage was present and before antibodies were produced suggested that early thrombocytopenia was neither due to substances released by damaged endothelium nor to the action of immune complexes.20 Peripheral platelet consumption becomes important in the later stages of disease,63, 221 but was observed from the third day post infection in subacute ASF99, 569, 570 and acute ASF,598 possibly correlating with procoagulant factors released by activated macrophages.52, 219 A study of pigs infected with a highly virulent Armenian genotype II virus reported haemophagocytosis in 50 per cent of lung samples examined, 80 per cent of lymph node smears and 90 per cent of bone marrow smears, which could contribute to thrombocytopenia.286
Death is due to shock and/or to excessive fluid exudation in the lungs.569, 570 Experimental infection with a highly virulent Malawi virus suggested that the profound shock observed could be due to the release of mediators such as vasoactive amines, free radicals and complement components by activated neutrophils and macrophages in the wake of consumption coagulopathy.570 Tumour necrosis factor-αincreases prostaglandin E2 and thromboxane A2, and decreases prostacyclin.231 Pathological changes in the renal interstitial capillaries confirmed that haemorrhages in the kidney are the result of phagocyte activation and endothelial destruction in renal interstitial capillaries, accompanied by disseminated intravascular coagulation.223 Haemorrhages in lymph nodes are ascribed to the same causes.98 Changes in the lungs, in particular alveolar oedema, are ascribed to activation of pulmonary intravascular macrophages that results in the release of IL-1, TNF-α, LTB4 and oxygen radicals.97 An important role for pulmonary intravascular macrophages (PIMs) in acute ASF has been confirmed by demonstrating that replication in large numbers of PIMs with concomitant intense activation and production of TNF-a and IL-1a coincided with the appearance of interstitial oedema and sequestration of neutrophils and fibrin microthrombi in septal capillaries.97, 100 Increased haematopoiesis in response to activation of macrophages was apparently responsible for normalization of the numbers of circulating monocytes and total white blood cell count (WBC). Lymphopenia was marked and could not be compensated for by increased haematopoiesis.219
The similarity of the effects of ASFV infection in domestic pigs and Eurasian wild boars indicates a similar pathogenesis in the two subspecies.63, 187 Only limited information is available for African wild suids that are naturally resistant to the virus. A study in the eastern bushpig (P. larvatus ) revealed that replication was much more restricted than in domestic pigs, occurring mainly in the spleen with slow spread to lymph nodes, although viraemia sufficient to cause transmission did develop.410
Immunology
Apparent contradictions characterize the current understanding of immunity to ASFVs. Chief amongst these is the fact that solid immunity to homologous viruses clearly occurs in the few pigs that survive infection with virulent viruses;259, 323, 546, 573 furthermore, repeated infection seems to broaden the spectrum of resistance to heterologous viruses.451 On the other hand, attempts made over many decades using a variety of approaches have as yet failed to result in the production of an effective vaccine.483
Recently reported findings may portend an end to this unfortunate situation in that progress has been made towards vaccine development in two important respects: (1) identification of the basis of viral diversity (i.e. enabling the grouping of immunologically related ASFVs) and (2) discovery of two viral proteins (CD2v, a viral homologue of a T-lymphocyte surface protein that is responsible for haemadsorption displayed by infected cells, and C-type lectin) involved in the induction of protective immunity.83 Unfortunately however, exploitation of this progress may still be some way off because fundamental understanding of the immune responses to ASFV infection remains inadequate.483 This was shown by immunization of pigs with an experimental subunit vaccine containing these two viral proteins; the experimental vaccine induced only partial protection, indicating that for achievement of solid immunity other, as yet unidentified, proteins need also to be incorporated into future vaccines.83
The predilection of ASF viruses for cells of the monocyte/macrophage lineage means that these viruses have major direct and indirect effects on the immune system of infected pigs.107, 141, 228, 354, 410, 512 Initially, necrosis of macrophages occurs as a direct result of infection and viral replication, thereby disturbing effective antigen presentation to competent immunocytes.107 Indirect effects of infection are related to apoptosis of both T and B lymphocytes in the physical vicinity of necrotic macrophages and to functional alterations of surviving lymphocytes and modulation of swine leukocyte antigens. Furthermore, early investigators found that antibodies to ASFVs produced by recovered pigs were incapable of neutralizing ASFVs.332, 459 That, however, has been disproven and neutralization sites have been identified on viral proteins p30, p54 and p72.158 It has moreover been shown that both circulating antibody and at least a subset of T cells (CD8+) are necessary for effective immune protection against lethal challenge with virulent homologous virus.28, 408
Apoptosis of lymphocytes, a defense mechanism adopted by animals to some viral infections, is assumed to occur in both spleen and lymph nodes as a result of the release of cytokines from infected macrophages. In general, apoptosis of T cells in pigs following infection occurs prior to and to a greater extent than for B cells and these events happen earlier in the spleen than in lymph nodes.410 Although numbers of B lymphocytes become depleted as a result of acute ASF infection, there is an initial increase in circulating B lymphocytes in pigs following infection with virulent viruses.472
A study of ASFV infection in bushpigs revealed that in these animals, in contrast to domestic pigs, apoptosis of B lymphocytes predominated.410 Evidence for infection of dendritic macrophages in germinal centres was also found as previously reported for pigs.234 In bushpigs, levels of viral replication are orders of magnitude lower than in domestic pigs (5 –7 log10 HAD50 ) and numbers of apoptotic lymphocytes are correspondingly lower (approximately 30-fold difference).410 It is likely that the situation in warthogs is similar because, although the extent of apoptosis in lymphoid tissues of that species has not been measured directly, levels of viral replication in warthogs are also lower than in domestic pigs.547 A direct relationship between levels of viral replication and numbers of mononuclear cells undergoing apoptosis has been demonstrated.411 Conversely it is likely that in wild boars the effects of infection on lymphocytes are similar to those suffered by domestic pigs.63
In contrast to lymphoid depletion that occurs in the course of acute infections in pigs and wild boars, lymphoid hyperplasia, causing physical enlargement of lymph nodes, characterizes chronic infections with ASF viruses.63
The existence of immunological variation among ASF viruses was initially supported by studies focused on cross haemadsorption inhibition (HAI) testing performed in vitro . In general, inhibition of haemadsorption to infected cells in macrophage cultures was shown only for homologous antisera, i.e. HAI usually did not occur with anti-sera derived from pigs that had been infected with heterologous viruses. However, these reactions were found to be too inconsistent to use as a means for establishing immunological groups within the ASFV population.323, 451 More recent investigation, however, has contradicted the finding that HAI test results are unreliable and confirmed the specificity of sero-groups identified on the basis of cross-HAI testing. Currently, eight HAI sero-groups have been identified and more are likely to be present in the field.83
Infected pigs produce antibodies measurable using conventional techniques such as enzyme-linked immunosorbent assay (ELISA) and radio-immuno-assay as early as three to four days or after seven days by complement fixation, immuno-precipitation and immunofluorescence. Circulating antibodies persist for up to two years or longer, with the half-life estimated to be 1.8 years.432, 466, 467 Chronically infected pigs may become hypergammaglobulinaemic, suggesting continuous antigenic stimulation.419, 421
As indicated above, lymphocytes, unlike macrophages, do not support viral replication in pigs infected with ASFVs.576 Pigs that have recovered from infection with ASFV show the usual T cell responses as measured by lymphocyte mitogenesis, lymphokine production and cytotoxic T cell effects. There are, however, a number of reports indicating that T cell responses are inhibited.17, 90, 91, 480, 519, 584 In vitro measures of T cell responses usually show, as with HAI responses, better reaction to homologous- than to heterologous viruses.228, 480, 519 Cell fractionation and reconstitution experiments conducted on inbred pigs infected with a virulent ASFV showed that the proliferative capacity of surviving (i.e. those that do not undergo apoptosis) CD4+ and CD8+ T-lymphocytes, as well as B lymphocytes, obtained from infected spleens were inhibited in their response to mitogens.107
It has furthermore been shown that human interferon alpha (IFN-α) and gamma (INF-γ) inhibited ASF replication in Vero cells, i.e. their actions are synergistic. While human tumour necrosis factor did not inhibit replication in Vero cells, it had an additive effect on the combined actions of IFNs αand γ.415 Moreover, continuous treatment of cell cultures with IFN-γwas able to cure Vero cells in the course of both lytic and non-cytolytic infection with ASFV.
Attempts to develop vaccines against ASFV
A number of different approaches to vaccine development have been attempted over more than half a century without material success. These attempts have recently been well reviewed.29, 483 The following approaches have been attempted:
- Inactivated vaccines
No success in this respect has been reported following testing based on inactivation of purified virions, inactivated cell culture supernatants or extracts and infected cells fixed with gluteraldehyde. Various adjuvants used with these antigen preparations have been assessed without indication of practical benefits.
- Live attenuated vaccines
Various methods have been tried in attempts to produce attenuated vaccines, including use of viruses of naturally reduced virulence, serial passage of ASF viruses in cell cultures and deletion/knock-out of viral genes associated with virulence; in some cases double or multiple gene deletions or mutations were effected. These approaches have provided more promising but, on the whole so far, unsatisfactory results.189 Nevertheless, it has been suggested that live attenuated vaccines still offer the best prospects in the shorter to medium term.29
- Subunit vaccines
As indicated above, subunit vaccines have been tested and found to produce partial protection at best, indicating that there are important additional immunogens that remain to be identified.278 For example, baculovirus-expressed proteins (p30, p54, p72 &p22) induced high levels of neutralizing antibody in vaccinated pigs but did not protect them against subsequent disease following challenge with the homologous virus.386
- DNA vaccines
Constructs containing various ASFV genes have been used as experimental DNA vaccines with some success in that partial protection against lethal challenge was demonstrated.28, 299
Ironically however, the report by Lacasta et al.299 showed that a DNA construct that lacked functional genes coding for known ASFV immunogenic proteins also afforded partial protection against virulent viral challenge. Nevertheless, after many years of fruitless investigation it appears that there is light at the end of the tunnel as far as the development of an effective vaccine or vaccines against ASF is concerned.
Clinical signs
Acute, peracute, subacute and chronic manifestations of infection with ASFV have been described.56, 63, 192, 288, 362, 364, 431, 459, 511 The acute and hyperacute forms of ASF are most common in African outbreaks and very few animals recover, with the apparent exception of the endemic areas where infection is subclinical or results only in mild disease in a varying proportion of the pig population.394, 431, 432
On the basis of existing information, the incubation period for ASF under natural conditions is considered to be four to 19 days with a median of five days.56, 119 As determined in experimental studies, the incubation period varies according to the virulence of the virus and the dose and route of infection as well as the response of individual pigs. Clinical signs may appear as early as 24-48 hours after parenteral infection with a virulent pig-adapted virus,459 three days post infection,389 and infection with a virulent virus induced clinical signs within 1 to 7 days of infection regardless of the route of infection.270 However, pigs inoculated via the intramuscular route had a statistically significant shorter time to development of viraemia and a shorter mean survival time that was not statistically significant.270 In the first of several experiments investigating natural resistance in local breed pigs from an endemic area in Mozambique, two pigs were inoculated intramuscularly in the gluteal muscle with 104 HAD50 /ml of a virulent virus from the same area (MOZ/1/98). One developed clinical signs of fever and lethargy on day 5 pi and died the following day, while the other pig also died on day 6 pi but without developing clinical signs. The 18 in-contact pigs either died without developing clinical signs or developed clinical signs 13 to 19 days after inoculation of the donor pigs and died or were euthanized 12 to 25 (mean 15.2 in the first group of nine and 15.7 in the second group) days after the donors were inoculated.432 In one study using the Malta/78 virus considered to be of moderate virulence the mean time from exposure to donor pigs to development of clinical signs in recipient pigs was 3.7 days, with only one pig remaining asymptomatic until the 8th day.592 Infection with lower doses of virulent viruses resulted in failure to infect some wild boars and prolonged incubation periods of between 11 and 19 days but the boars all developed severe fatal ASF.446 Infection with viruses of low virulence resulted in prolonged incubation periods or failure to develop any clinical signs.202, 530 It is evident that considerable variation in both incubation period and time to death or euthanasia has been observed in experimental infection, and there is less information on natural infection in the field.
The clinical signs of ASF are usually described as non-specific because they resemble those of a variety of other diseases, notably CSF and septicaemia ( see Differential diagnosis ). However, the combination of high fever, haemorrhages and high mortality affecting pigs of all ages should give rise to a strong suspicion of ASF. The clinical signs and pathology of the different manifestations of ASF (peracute, acute, subacute and chronic) have been reviewed recently511 and are briefly described below.
Rectal temperatures usually attain a plateau of about 41 to 42 °C within 48 hours of the initial rise, and in peracute cases death may occur during this time when, very often, other clinical signs are not evident. In animals that survive longer, listlessness, partial or complete anorexia, huddling together and a disinclination to stand become apparent; some animals develop a swaying gait, incoordination, convulsions and muscular tremors or even paresis. There is increasing congestion and cyanosis of the skin of the tail, limbs, ears, snout and abdomen, easily seen in white-skinned pigs but not evident in black-skinned pigs or wild boars. Haemorrhages often develop in the skin. The respiration is shallow and rapid and the heart rate accelerated. Slight mucopurulent ocular and nasal discharges are often present, followed by a profuse, watery or frothy, blood-stained nasal discharge in those recumbent animals with severe lung oedema. The latter is often the immediate cause of death in acute and peracute cases.
Vomiting is common and some animals become constipated, with blood-stained mucus on the faeces; others develop watery diarrhoea or dysentery, with fresh or blackened blood adhering to the tail and perineum. Pregnant sows often abort early in the clinical course and at all stages of pregnancy.517 Towards the end of the acute disease the rectal temperature falls rapidly, often to subnormal levels, followed by coma and death.
The survival time (the period from the onset of pyrexia to death) is characteristically short for virulent African strains of the virus, varying between two and nine days in more than 90 per cent of cases, with a mean of about five days.113, 237, 349, 454, 455, 546 There is, however, a tendency for isolates derived from or passaged in pigs, such as the Tengani strain,123 to have a shorter survival period (two to four days) than ‘wild ’isolates from warthogs and ticks, where the period is usually about seven days. Passage of ASFV in pigs resulting in heightened virulence was observed in early experiments,136 but, as indicated above, this is contrary to field experience in Europe and elsewhere outside Africa.
Clinical signs in subacute cases, i.e. those lasting three to four weeks,260 more closely resemble those of classical swine fever, with the development of irregular remittent fever, anorexia, and loss of condition. Pneumonia is frequent and leads to serofibrinous pleuritis with pleural effusions and adhesions that cause coughing and dyspnoea, especially on exercise. Other animals develop cardiac insufficiency due to extensive serofibrinous pericarditis and adhesions that may result in intermandibular oedema and death on forced exertion. Painful swelling of the joints of the limbs as a result of joint and tendon sheath effusions may also appear, with oedema of the periarticular tissues. Some longer-term survivors with chronic infection become emaciated and stunted in growth and may develop areas of haemorrhagic necrosis of the skin, particularly where it overlies bony protuberances, followed by abscessation and deep ulceration. These lesions also occur on the ears and snout.
Pathology
The clinical pathology of ASF is unlikely to be studied other than under experimental conditions. In acute ASF, total leukocyte count may be reduced or normal, but differential counts reveal lymphopenia and neutrophilia with a left shift.137, 219, 364, 486, 512 In pigs that survive long enough to manifest subacute or chronic disease, the leukocyte count normalizes, probably owing to increased haematopoiesis.486
The pathology of acute ASF has been described in detail in a number of studies.113, 132, 337, 362, 364, 511, 561 The development of lesions depends on the duration of infection. Pigs that die of peracute ASF often do so before either clinical signs or significant lesions develop. There may be a degree of skin flushing of extremities and the ventral abdomen in white-skinned pigs, and general congestion of organs, with some fluid exudation into body cavities and possibly fibrin strands on organ surfaces.
Acute ASF is characterized by marked reddening to purplish cyanosis of the extremities and the ventral surface in white-skinned pigs. Frank haemorrhages may be present. Mucosae (ocular, oral, genital) are usually congested to haemorrhagic. Tear marks with mucopurulent ocular exudate may be evident. A mucopurulent nasal discharge may be observed, or there may be bloody froth at the nostrils, indicative of severe lung oedema. Opening the carcass usually reveals accumulation of straw-coloured to bloody fluid in body cavities, and widespread haemorrhage in organs and on the parietal surfaces. Petechiae and/or ecchymoses are usually evident in the renal cortex ( Figure 8 and 9 ) if the kidneys are not too congested to permit these to be seen, as well as on the capsule of the spleen. Extensive haemorrhage is often evident epi- and endocranially. Organs are generally congested. The spleen may be markedly enlarged and darkly congested, but may also be of almost normal size. Infarcts are occasionally evident at the margins. Lymph nodes, in particular those of the head and the gastrointestinal tract (the hepatogastric and mesenteric lymph nodes) are markedly swollen and haemorrhagic, sometimes resembling blood clots ( Figure 8 ).
The lungs do not collapse on opening of the thoracic cavity. They are usually congested to haemorrhagic, with a mottled appearance, and the interlobular septa are prominent owing to the accumulation of fluid ( Figure 9 ). On cut surface there is exudation of fluid and froth, and the trachea is usually filled with froth, which may be blood-stained. The gastrointestinal tract may appear normal to severely congested, and haemorrhages are usually present in the gastric mucosa ( Figure 12 ). Contents of the intestines are generally scant, fluid and sometimes blood-stained, and the rectum may contain bloody fluid or hard faeces covered with bloody mucus.
Pigs that survive longer may exhibit severe interstitial pneumonia, with mottled lungs that may be covered by a fibrinopurulent exudate ( Figure 13 ). Lymph nodes are enlarged and haemorrhagic to fibrous. Joints may be swollen due to accumulation of turbid fluid. Chronic ASF is characterized by severe emaciation and, in the case of growing pigs, growth retardation, and the pigs have a long hairy coat. Ulcerative non-healing sores may be present, especially over bony points. Joints may not be swollen, but there is clinical and microscopic evidence of arthritis. Other lesions of chronic ASF include fibrinous pericarditis and interstitial pneumonia, and the lymph nodes are usually enlarged and firm.
Pigs that recover fully from acute ASF may not develop lesions of chronic ASF and may appear completely normal at necropsy.364 Descriptions of chronic forms of ASF that were recorded in Angola included necrosis and ulceration around the ileo-caecal valve, as described in classical swine fever,188, 561 but this has not been described elsewhere.
Histopathological lesions of acute ASF include fibrinoid vasculitis, best seen in the lymphoid organs, and severe karyorrhexis of macrophages in lymphoid tissues ( Figure 14 ). In the spleen, the Schweiger-Seidel (SS) sheaths are obliterated due to destruction of macrophages ( Figure 15 ). Infiltration of monocytes and macrophages, often with marked karyorrhexis, and often but not always perivascular, has been described in numerous organs including the tonsils, skin, peri-ocular tissues, splenic red pulp, lymph nodes, gastro-intestinal mucosa, lung, liver, and brain, and less commonly in the oral and pharyngeal mucosa, kidneys, and adrenal glands.364
Individual organs reveal haemorrhages and other lesions that are not pathognomic but result from processes caused by ASFV replication in host cells, mainly macrophages. Lung lesions vary from severe congestion, haemorrhage and accumulation of serous fluid in alveoli and septa to acute interstitial pneumonia, with infiltration of mononuclear cells into alveolar septa and accumulation of mononuclear cells, which may appear necrotic, in alveoli. The portal tracts of the liver may be infiltrated by mononuclear cells and eosinophils, and groups of mononuclear cells may also occur in sinusoids. Individual hepatocytes may be necrotic. Lesions in the kidneys vary from haemorrhage to acute fibrinous glomerulonephritis, accompanied by varying degrees of tubular degeneration and necrosis, and protein casts. In pigs that survive for a few days, non-suppurative meningoencephalitis is usually present.
The histopathological lesions of chronic ASF have been described.364, 365 The peri- and epicardium may be thickened with granulation tissue covered by a fibrinous exudate and infiltrated by mononuclear cells.
Lung septa are thickened due to infiltration of mononuclear cells. Focal accumulations of mononuclear cells in alveoli become necrotic and surrounded by infiltrating mononuclear cells including plasma cells. These foci may be mineralized and walled off by fibrosis, similar to the sequestra encountered in contagious bovine pleuropneumonia. Articular swellings are characterized by granulation tissue infiltrated by mononuclear cells.364 Infiltration of mononuclear cells in the leptomeninges and around blood vessels in the brain, in particular the brain stem, is a constant finding in chronic ASF.364 Chronic changes in the lymph nodes result from proliferation of reticular cells, which often obliterate the sinuses and occupy and enlarge the germinal centres ( Figures 16 and 17 ).364
Diagnosis
Outbreaks of acute ASF, which predominate in Africa, should not be difficult to recognize when factors such as the epidemiology, clinical signs and lesions are taken into account. There are few diseases that cause such high mortality among pigs of all ages. Difficulties may arise when subacute, chronic, or even subclinical infection exists, especially in countries where the disease has become endemic in free-ranging, unimproved pigs. Fortunately, among African countries, CSF appears to occur only in Madagascar, where it has largely been controlled by vaccination, so that the major difficulties encountered elsewhere in distinguishing between the two diseases do not usually arise, but with the spread of ASF to countries in eastern Europe and Asia, where CSF is present this may become problematic.
Whenever possible, field diagnoses of ASF should be confirmed in the laboratory, particularly if drastic control measures such as stamping out are to be imposed. Many techniques are available. These include methods for the detection of infectious virus, viral antigens, viral DNA, and specific antibodies against ASFV.
The haemadsorption:cytopathogenesis test322, 324 to detect infectious virus is carried out by inoculating suspect blood or tissue suspensions, especially of spleen and lymph nodes, into porcine monocyte or macrophage cultures derived from peripheral blood, bone marrow, or lung washings. The adsorption of several layers of erythrocytes to infected cells (the virus itself is incapable of haemagglutination) usually becomes visible in one to five days, depending on the quantity of infectious virus present. Generalization occurs rapidly, though it is sometimes necessary to subculture to demonstrate weak haemadsorption, which may then be only one or two cells thick. When non-haemadsorbing viruses are involved, the macrophage cultures undergo cytolysis after two to seven days, the cause of which can be confirmed, using methods for detection of viral antigen (such as immunofluorescence) or DNA (e.g. PCR). Rarely, two or three passages are required to demonstrate haemadsorption. Other cell types such as LLC-MK2 line can be used for isolation but are less sensitive448 and are better employed for virus propagation after an adaptation process. The need to develop cell lines to replace primary cell cultures remains high on the list of research priorities identified by the Global African Swine Fever Research Alliance.15
Ultimately, strains of ASFV need to be isolated as a prerequisite for further studies e.g. examination for virulence in pigs and for genetic or antigenic variation. However, the specificity of haemadsorption, allied with PCR, immunofluorescence and the unique virion morphology demonstrable by transmission electron microscopy of infected cell-spreads, makes inoculation of pigs unnecessary for virus identification.
A wide variety of techniques have been used to detect viral antigens in tissues of infected pigs. All are of decreasing value from 7 to 12 days following onset, when antibodies begin to appear in quantity. They include direct immunofluorescence on impression or blood smears, frozen sections or inoculated cell cultures,78, 112, 263, 267 and ELISA.247, 577 The haemadsorption:cytopathogenesis test remains definitive in detecting infectious virus and both virus isolation combined with haemadsorption and direct immunofluorescence are still recommended, particularly in outbreaks representing new introductions into ASF-free areas.31 The direct immunofluorescence test is a robust test that is able to produce rapid results on clinical specimens during outbreaks and is highly sensitive for detecting acute infections. Antigen-detecting ELISAs provide another rapid test that can be used in laboratories that do not possess capacity for molecular diagnosis.197, 409 A commercial kit (Antigen ELISA INGEZIM PPA K2 (INGENASA) and an Ag pen-side test (INGENASA) are available and are recommended for surveillance of ASF.31
Highly sensitive techniques exist for detection of viral DNA. These methods have the advantage of enabling the diagnosis to be made in the absence of infective virus (for example in preserved material), as well as in the presence of circulating antibodies.424 Cloning of fragments of the ASFV genome allowed the production of radioactive probes86 that under optimal conditions could detect a minimum of 100 infected MS cells (20pg viral DNA), whilst non-radioactive probes (biotinylated or sulphonated) were less sensitive.540 However, subsequently a biotinylated probe was described that could detect 10pg of viral DNA.442 The polymerase chain reaction (PCR) has become the method of choice for detection of ASFV in most laboratories. It is rapid, sensitive, and specific, and eliminates the need to use infectious virus as a control.532 A range of PCR tests are available409 and generally show good agreement when compared.31, 197
Isothermal assays have the advantage of not requiring expensive thermocycling equipment.409 Two have been developed for detection of ASF virus, the Invader® assay268 and an assay based on loop-mediated isothermal amplification (LAMP).277 A study on field samples in Uganda found that LAMP showed fair agreement with the OIE-recommended PCR in detecting ASFV and had advantages in being simpler to apply and providing results in a shorter time.34 Recently, a chimeric DNA/LNA-based biosensor showed promise as a preliminary screening assay for detecting ASF viral DNA in blood samples.58
Viral antigen and DNA can also be detected in preserved, paraffin wax-embedded tissues by immunocytochemical methods and in situ hybridization.41, 177, 205, 234, 412, 437 These techniques are mainly used as research tools to determine viral localization. For diagnostic purposes as well as research detection of ASFV in tissues fixed in formalin or formol-glycerine has been reported.51, 316
In outbreaks of acute ASF, most pigs die before producing antibodies, and antibody detection is therefore usually of little value as a diagnostic tool in uncomplicated outbreaks. However, serological tests are the most important laboratory tool for studying endemic ASF in pigs in African countries, and are currently also applied for surveillance in wild boars in Europe.197, 201 They have been used extensively to support eradication and restocking operations in countries infected by strains of much reduced virulence, such as Spain, the Dominican Republic, Belgium, and the Netherlands.60, 481, 503, 581 They are also necessary for the investigation of vertebrate wildlife reservoirs, such as warthogs and bushpigs. Numerous techniques have been developed successfully as the requirement for rapid, large-scale testing has evolved, and various ELISAs now obviously offer great advantages for this purpose. However, the lengthy duration of ASF antibodies means that their presence should not be interpreted as proof of current infection; they simply demonstrate history of infection.
Antibodies in pig sera that inhibit the adsorption of erythrocytes by infected cells, but do not neutralize infectivity, were described324 at the same time as haemadsorption-cytopathogenesis. They were later shown to be essentially isolate-specific.323 The haemadsorption-inhibition technique was modified by Coggins,110 who confirmed its strain specificity and improved its sensitivity. These tests were used, therefore, in some earlier attempts to classify isolates of ASFV and, in particular, to show that the 1960 Lisbon isolate was different from that causing the 1957 epidemic.110, 259 They have, however, been superseded by molecular techniques.
Complement fixation (CF) was the first serological technique to be used, but the procomplementary effect of sera from pigs and wild suids is a complication,78, 121 and enhancement of antibody activity by selected normal calf sera is desirable.122
Malmquist323 developed the immunodiffusion (ID) test, which incorporated cell culture antigens. This, like the CF test, is group-specific, which means that it detects antibody (or antigen) from all isolates of ASFV, whether haemadsorbing or not. The simple ID test was later modified and accelerated by immuno-electrophoresis (IEOP) on slides418 or by reverse radial immunodiffusion incorporating viral antigens into the agar.424
The indirect immunofluorescence (IF) test has the advantage that by using a single porcine antiglobulin conjugate large numbers of sera can be examined within hours. It uses cells containing antigens of ASFV on slides or coverslips in which virus has been rendered non-infectious by treatment with, for example, lipid solvents. Hence the slides or coverslips can be safely held in laboratories in countries free of ASF. The method was long employed as a standard procedure in Spain69, 505 to confirm positives in IEOP tests. A modification of this technique that uses indirect immunoperoxidase (IIP) staining of ASFV plaques has comparable sensitivity.420 Indirect immunofluorescence has the disadvantage of being relatively laborious and requires subjective interpretation, and is expensive. In the Netherlands the IIP method was adapted with monoclonal antibodies to give antibody isotype specificity and an indication of the duration of infection.581
Enzyme-linked immunosorbent assays for the detection of antibody have great advantages in that they can be carried out on very large numbers of sera by semi-automated technology. They have been compared with IIF tests for field use and have proved to be somewhat more sensitive, although false positives occur with poor quality sera or those from particular farms.247, 508 The test can be rendered quantitative, but is usually carried out with a single serum dilution of 1:30.341 It has been shown to be more specific and sensitive when the major structural protein, VP73, in semi-purified form is used instead of an extract of infected cells.508, 541 However, VP73 did not detect antibody as early in infection as a dot immunobinding assay using ASFV cytosoluble antigen.422, 423 The ELISA was used on a massive scale to trace the spread and to confirm the eradication of ASF in Belgium after the 1985 outbreak; a serological survey of about 5 to 10 per cent of pigs on 3 008 farms gave negative results and 100 per cent agreement with IIF results.60 The use of an ELISA based on p30 and a Western blot based on p54 was found to be highly sensitive and specific.413
Apparent low incidence of seropositive virus-infected pigs detected in some eastern and southern African countries raised concerns that the assays used might not be working efficiently and that this might be due to the genetic diversity of ASFV in the region.124, 199, 200, 438 However, a study that compared novel ELISAs based on different antigens with the OIE-recommended ELISA concluded that the OIE ELISA could detect an array of genotypes and suggested that the observed anomaly might be host-related.201
To reduce the impact of possible false negative or positive results, it is recommended that more than one serological test should be used.201 Other techniques that have been described for detecting antibody include radioimmunoprecipitation11 and immunoblotting,12, 159 as well as a dot immunobinding assay.422 Immunoblotting has mostly been used to confirm results obtained by ELISA, and has been demonstrated to give better results than ELISA on sera that were kept at ambient temperature for longer periods.30 This may be of importance in developing countries where the cold chain is absent or poorly conserved. Another confirmatory test used is an immunoperoxidase plaque-staining assay (IP)420 that has proven more sensitive and specific than the ELISAs currently available, in particular when testing haemolysed sera, and is therefore the reference test recommended by the European Union Reference Laboratory for ASF.197 For routine testing of large numbers of sera, ELISA is the method of choice as the technique is rapid and can be used in automated systems, while IP is labour-intensive.197 Quartz crystal bioassays to detect antibody to specific proteins have been described.1, 556
Early diagnosis is of great advantage and therefore there has been a strong focus on developing pen-side tests. One of the earliest to be developed for ASFV was a lateral flow dipstick that showed good ability to detect ASFV at high loads during the acute phase of the disease, but could yield false negative results if low amounts of virus were present.515 A duplex lateral flow assay to detect antibodies to ASF and CSF performed well as a rapid pen-side test but the delay to the appearance of measurable antibodies in both diseases would exclude detection of acute or peracute disease.516 A commercial one-step immunochromatographic pen-side test for detecting antibodies compared well with ELISA and IP performed on the same samples and could be applied by hunters to test wild boars in the field.93 A portable PCR for rapid detection of ASFV under field conditions and able to detect the relatively low quantities of virus present in the preclinical phase of ASF infection has been described.600 A real-time PCR performed using a portable thermocycler also demonstrated potential for use as a pen-side test, although performance was better on reference samples than on field samples.310 A recent study recommended developing suitable sample preparation methods and using a PCR assay with control of inhibitory substances and a battery-operated portable thermocycler to obtain the best results under difficult conditions in the field.309
Duplex PCR assays have been developed to enable simultaneous diagnosis/exclusion of CSF6, 246 and multiplex PCR assays to detect ASF, CSF and other important diseases of pigs.157, 212, 230, 271, 272
Performance of diagnostic assays depends on the suitability of samples. Traditionally, the samples of choice have been whole blood or serum from live pigs and tissue samples, in particular lymphoid tissues, taken post mortem and moved to the laboratory as quickly as possible on ice but, in the case of blood, not frozen. Under field conditions, particularly in tropical countries but also when sampling wildlife, rapid transfer at low temperatures to a laboratory may not be feasible. Obtaining samples might also depend on lay persons who are not equipped or trained to collect blood by venipuncture. A range of alternative samples, including oral fluid samples obtained by allowing pigs to chew on ropes,373, 376 blood drops collected on filter papers or FTA cards and dried,79, 355, 574 swab samples for both virus and antibody detection,65, 95 formalin-fixed or formol-glycerine-fixed tissues,51, 177, 316 and faeces129, 388 have been used with variable levels of success.
In addition to detecting ASFV in its vertebrate hosts, diagnostic tests are necessary to determine possible involvement of arthropod vectors, in particular Ornithodoros ticks. Isolating virus from tick homogenates was time-consuming and could fail due to cytotoxicity that prevented observation of haemadsorption or cytopathic effects and inactivation of the virus during sample processing. A nested PCR with an internal control for PCR inhibitors was developed to facilitate detection in tick samples.48 A duplex PCR that can in one step detect both an ASFV p72 target and the 16S rRNA mitochondrial gene of the Ornithodoros vector has been developed, with the latter serving as an internal control.49
Searching for Ornithodoros , particularly in animal burrows, can be tedious and a negative result does not necessarily confirm absence. The antibodies elicited against salivary antigens in pigs when bitten by Ornithodoros have been used as a means of indirect detection of presence of the ticks.281 An early antibody detecting assay based on a complete extract of Ornithodoros erraticus salivary glands92 proved sensitive but had poor specificity, providing many false positive results.281 Improved specificity was reported for an ELISA using a soluble salivary antigen extract now known as SGE.281, 375 A similar test was developed to detect antibodies to Ornithodoros moubata complex ticks45, 46, 281 but the specificity in the field was reported to be low.476 Assays using purified antigens that differentiate between O. moubata and O. erraticus have shown more promising results but specificity was lower in the field than in the laboratory.138, 395, 447
Differential diagnosis
The clinical presentation and post mortem lesions of ASF are similar to those of a number of other diseases, although few cause such high mortality. Classical swine fever is the most important differential diagnosis: epidemics generally result in lower mortality than ASF. At necropsy, button ulcers at the ileocaecal junction may be observed in classical swine fever but have only been reported in ASF historically in Angola.188, 561 However, in general the gross and histopathological lesions are very similar, and laboratory confirmation is mandatory. Other viral diseases that may be confused with ASF are certain manifestations of porcine reproductive and respiratory disease (PRRS) (fever, reddening of the ears and extremities, abortion, respiratory signs) and porcine dermatitis and nephropathy syndrome (PDNS) (fever, red blotches on the skin, death). Apart from the abortions, PRRS usually manifests in piglets under the age of three to four months. PDNS is one of the syndromes associated with porcine circovirus-2 and usually affects a few individuals in the herd.
Bacterial septicaemias, in particular acute erysipelas, septicaemic pasteurellosis and salmonellosis, are important differential diagnoses for acute ASF. Mortality and case fatality rate are generally lower, and certain age groups are usually preferentially affected. High mortality across the age spectrum, failure to respond to antimicrobial treatment, and failure to isolate the bacterial pathogens are suggestive of ASF where CSF has been excluded. It should be noted that isolation of pathogenic bacteria or identification of parasites on blood smears will not necessarily exclude ASF, since concurrent bacteraemia and parasitaemia may occur, and virological examination if ASF is suspected is always necessary.
Neitz387 identified protozoal and rickettsial diseases of pigs as major differential diagnoses for ASF. Trypanosoma simiae causes very high mortality in pigs within a short time, with similar clinical signs of febrile disease. Examination of blood smears will demonstrate the parasites. In practical terms, T. simiae causes such fatal disease that zones where it occurs are generally free of pigs, although African local breed pigs appear to be unaffected.114 The other blood parasites of pigs (Babesia , Mycoplasma suis (formerly Eperythrozoon suis ) other trypanosomes including T. suis ) generally cause mild disease, with low mortality. Post mortal lesions if any differ markedly from those of ASF.
Certain intoxications also cause high mortality in all age groups, but deaths due to these generally occur over a much shorter period than those caused by ASF. Necropsy will usually exclude ASF, but widespread haemorrhage is a feature of a number of toxicoses, in particular poisoning with coumarin rodenticides and mycotoxicoses such as aflatoxicosis and stachybotryotoxicosis. Stachybotryotoxicosis is additionally characterized by widespread karyorrhexis of lymphoid tissues. Differentiation depends on identification of the toxin or the virus.
The subacute, chronic and atypical forms of ASF that were described in the Iberian Peninsula and some countries subsequently infected usually resulted from viruses of lower virulence including insufficiently attenuated vaccine viruses and have also been described or experimentally induced elsewhere.459, 511, 513, 530 It is hardly possible to list differential diagnoses for the range of non-specific signs and suspicion would depend largely on history and on exclusion of other diseases.
Control
The lack of a vaccine or any effective treatment for ASF dictates that management of ASF in domestic pigs means preventing contact between the pigs and sources of infection. The onus is finally on the pig producer to ensure that his/her herd does not become infected. How this can be done depends on the ASF situation in the area where the pigs are farmed, which determines the risks that have to be mitigated. The resources available to the farmer in general determine the husbandry system in which the pigs are raised.
The need for a risk-based approach to managing ASF has given rise to a plethora of risk assessments and models for different scenarios. In broad terms, risk assessments have looked at wild suids (including feral pigs) and farming and trade practices. In Africa the majority of risk assessments have focused on farm-level risks, including contact with wildlife reservoirs, and trade-associated risks. Elsewhere the focus has been largely on risk of introduction of ASF into new areas, with the exception of Sardinia, where the focus has been similar to that in Africa.
Failure to manage ASF in Africa has had serious consequences at home and abroad. In spite of its negligible contribution to international trade in pigs and pork, Africa was the source of the introductions of ASF into Portugal in the last century and the Republic of Georgia in 2007.118, 433 However, the main imperative for improving management in Africa is to remove one of the most important limiting factors for the potentially important contribution of pig production to food security, income generation and poverty alleviation.37, 81, 370, 434
Eradication of ASFV infection in domestic pig populations in Africa is feasible, but a major challenge is the fact that in most countries the majority of the pigs are raised in low biosecurity husbandry systems by smallholders who lack the resources needed to modernize their enterprises.104, 117, 434 As smallholder pig production requiring low investment is and will remain economically important for Africa at least in the short and medium term ( see Introduction ), eradication from domestic pigs is seen as a gradual and long term process. Elsewhere the focus is on eradication in order to achieve freedom from ASFV infection to eliminate the trade disruption that has been caused by ASF, but feasibility remains problematic.
Many non-African countries have succeeded in eradicating ASF in domestic pigs.13, 32, 40, 60, 68, 366, 385, 459, 481, 585, 587 The campaigns involved the elimination of large to enormous numbers of pigs, in the case of Haiti, Dominican Republic and Malta all the pigs, and the expenditure of large amounts of money provided by governments or by international organizations.13, 40, 459, 481 ASF is still present in Sardinia and there have not been many success stories following the 2007 introduction via Georgia into Russia and subsequently its neighbours.204, 282, 371, 510 Efforts to eradicate ASF from mainland African countries and the island of Madgascar were also less successful.81, 153, 434, 475 In poorer settings and even in commercial farming systems the dire socio-economic consequences of massive elimination of pigs (or other livestock) generally outweigh the advantages, particularly when, as with ASF, there is no zoonotic threat to human health and access to high-priced export markets is not an issue.232, 320, 440, 441
Managing the ASF risk of the warthog-tick cycle
Eradication of infection from the areas where African wild suids provide a reservoir for the virus is impossible, because extermination of wildlife is unacceptable both morally and aesthetically, and is usually neither successful nor cost-effective. Attempts in the past to reduce the numbers of warthogs and bushpigs by shooting and gassing them,132 paying a bounty for snouts in Kenya, and declaring them vermin in the affected area in South Africa387 did not succeed in eradicating ASF. It is therefore accepted that control measures that prevent contact between domestic pigs and potentially infected wild suids will be required indefinitely for successful pig production in areas where the warthog-tick cycle occurs. Fortunately, interface areas where the warthog-tick cycle occurs are limited in comparison to pig-producing areas in general. The warthog-tick cycle does not present an important threat globally as neither of the major excursions of ASF beyond Africa ’s borders had any demonstrable links with this sylvatic cycle.
The measures used to prevent contact between domestic pigs and warthogs in the savannah areas of southern and eastern Africa where the virus is maintained in the warthog-tick cycle have proven successful,56, 520 and are sometimes considered to be a forerunner of compartments. Separation is achieved by maintaining domestic pigs in pig-proof enclosures, ideally surrounded by a double perimeter fence or a solid wall. The barrier should extend below the ground surface to a depth of at least 0.5 m to prevent burrowing.56 Warthog carcasses and offal may not be brought into the enclosures or fed to the pigs, although the risk of ASFV transmission by feeding warthog tissues to pigs does not appear to be high.459, 544, 547 By applying these measures, Kenya apparently successfully controlled ASF between 1964 and 1994; the outbreak that occurred in the environs of Nairobi in 1994 was not associated with warthogs.428 In South Africa, a Swine Fever Control Area that includes parts of the North West, Limpopo, Mpumalanga and KwaZulu-Natal provinces, was gazetted in 1935.132 African swine fever remained confined to that area since 1939448, 449 apart from several outbreaks in the former southern Transvaal (now in Gauteng Province) in 1951387 and an outbreak just outside the control area in Limpopo Province in 1996.210 Outbreaks in the control area have invariably occurred on single farms among relatively small herds of pigs that have been kept free-range or in insecure premises that permitted considerable contact with warthogs and their burrows. Control has otherwise been so successful that a system of approval allows accredited farms with a high health status and level of management to sell pigs outside the Control Area both for purposes of slaughter and breeding.431 Although maintaining the ‘compartment ’type of separation described above requires considerable investment by the farmer, more affordable options are available and are discussed below under farm biosecurity.
Managing the ASF risk of the domestic pig-tick cycle
Control is considerably complicated where pig-associated tampans maintain the virus because the tampans are potentially able to survive for several years without feeding in cracks and crevices in the floors and walls of infested huts and pig shelters.66 Other than by burning down such structures it is almost impossible to get rid of them, as their cryptic habitat strongly reduces the efficacy of acaricide application. The problem of their persistence was amply demonstrated in the Iberian Peninsula.502 Strict control measures were applied, with serological testing and slaughter of pigs that were positive for antibodies to ASF,32, 53 but eradication took more than 30 years to achieve and the infection lingered longest in areas where the ticks were involved.66, 433 The best approach in areas where the domestic pig-tick cycle is present is to provide pig housing that does not offer suitable habitats for the ticks, i.e. with concrete or slatted floors and smooth walls without cracks in which the ticks can hide, but unfortunately such structures may be beyond the resources of poorer pig farmers without access to financial support and higher value markets.
In circumstances where tick vectors are not involved the disease is easier to control as long as the pigs are confined and protected from exposure to infected pigs, contaminated feed and fomites, as described below.
Managing the ASF risk in wild boar populations
Although wild boars have been involved in ASF outbreaks in many countries where there was contact with domestic pigs, a potential major role in maintenance and circulation of the virus was only identified after the introduction of ASF into the Baltic countries in 2014. This gave rise to risk assessments focusing on wild boar populations,74, 75, 151, 460, 565 most of which recommended targeted population reduction, elimination of risky hunting practices, with increased surveillance and safe disposal of carcasses. Various strategies for managing wild boar numbers through drastic or targeted hunting and reducing possible exposure of domestic pigs through changes in hunting practices including feeding of boars and construction of strategic fences are considered, but managing large free-living metapopulations is at best challenging.74, 75, 133, 208, 239, 244, 302, 465 Since mortality amongst wild boars is high,63, 64, 187, 391, 392 environmental contamination by clinically sick and dead boars is suspected to play an important role in the epidemiology of the disease.105, 465, 579 In these circumstances it is probable that in the short term at least rigorous protection of domestic pigs from contact with wild boars and in particular with the remains of wild boars and anything that may have been contaminated by them will remain critical in the affected areas. The ultimate aim in non-African countries would obviously be complete eradication of infection, but eradication of wild boar populations is not only undesirable but also impossible. Therefore development of an effective vaccine that could be administered by oral bait would be ideal, but in the short term at least the focus should be on avoiding spillover to domestic pigs by implementing basic on-farm biosecurity measures, which are discussed in the following sub-section.
Managing ASF risk in domestic pig production
Low biosecurity pig production and marketing practices have been identified as a risk for ASF in many countries in the African region59, 81, 104, 117, 139, 140, 171, 285, 296, 307, 383, 394, 403, 496, 521 and elsewhere,55, 119, 213, 282, 297, 319, 331, 366, 371, 393, 402, 528, 564 Although most of the reports refer to pig production practised by smallholders, lapses in biosecurity have also resulted in outbreaks on commercial farms.106, 564 However, maintaining adequate biosecurity on commercial pig farms is comparatively easy, as the pigs are permanently housed and are fed commercial rations, and reports to OIE so far suggest that in both Europe and Africa outbreaks of ASF in large commercial pigs farms have been the exception rather than the rule.572
Modern commercial pig production is the norm in most European countries and in Africa is growing in response to the increased demand in rapidly expanding cities166-168, 234 and, in some countries, incentives to supply good quality products for an increasingly important tourist industry. To prevent not only ASF but other profit-reducing diseases, most commercial enterprises implement at least basic biosecurity measures. These include limited access by people and vehicles, cleaning and disinfection, not feeding catering waste to pigs and maintaining a closed herd or ensuring that new stock is acquired from ASF-free sources and that new entries are kept separate from the rest of the herd for a period of at least 21 days.55, 164, 171, 172, 403, 431 For larger commercial pig enterprises, particularly if they are targeting regional export markets, compartmentalization of farms as described in Chapters 4.3 and 4.4 of the Terrestrial Animal Health Code of the OIE ( http://www.oie.int/international-standard-setting/terrestrial-code/access-online/ ) is recommended, as already practised in the commercial pig sectors in South Africa and Zimbabwe. Compartments need to have an auditable biosecurity system approved by the veterinary authorities of the country. Confirmation of freedom from ASF and other trade sensitive diseases by regular veterinary supervision and prescribed laboratory testing requires investment on the part of the owners, but has the advantage of assured protection from devastating losses due to ASF and other diseases and enables negotiation of bilateral trade agreements that permit trade to continue even if there is an outbreak of ASF in the area. Although modern commercial pig and poultry production systems are highly suited to compartmentalization, the principle has not been widely adopted in industrialized countries, possibly because disease control at national level is such that they seem unnecessary, but features of ASF such as the involvement of large wild boar populations in the epidemiology74, 75, 208 may lead to wider acceptance of the usefulness of compartments in preventing ASF.
Pig keepers benefiting from low input systems are usually understandably reluctant and often unable to change to a higher input system even when they understand the potential advantages.104, 304, 334, 566 The most important constraints for producers with limited resources are housing and feed. Investment is discouraged because the quantity and quality of the pigs they produce satisfy the local and only readily accessible market and additional investment would make no difference to the prices that they receive. Allowing pigs to scavenge or feeding them potentially dangerous swill is a reality that needs to be addressed as far as possible within the means of the producers. To control ASF in Africa, an innovative approach is required that takes account of the realities in the affected countries. To this end, a comprehensive strategy for the control of ASF in sub-Saharan Africa has been developed.169 The strategy encourages the ongoing efforts to develop an effective vaccine against ASF, but it mainly focuses on measures to prevent ASF in the absence of a vaccine, as that is likely to remain important for the near future at least. Key components are prevention of ASF in production and marketing systems by a process of risk mitigation throughout value chains.165 Maintaining an adequate level of biosecurity is key to preventing ASF, but in practical terms the measures to be implemented must be acceptable and affordable to the producers. Factors to be considered in selecting an approach include available financial and technical resources and the production goal, which depends on the type of markets that are available. There is also a focus on improving market access and profitability as incentives for modernization of the pig sector. Although the strategy is designed to be appropriate for Africa, many of the principles are applicable to pig sectors worldwide.
Risk assessments for infection of pig farms with ASFV in Africa have concluded that on-farm biosecurity measures would be effective in preventing ASF.139, 140, 171, 285, 351 One study has demonstrated that the implementation of simple biosecurity measures aimed at preventing ASF on a medium-sized pig farm in Nigeria would be cost-effective, partly because the measures would prevent other diseases as well.172 In Benin and Ghana the success of on farm biosecurity measures was demonstrated during the outbreaks in those countries, since farms that applied them remained free of infection.81 Basic biosecurity measures for preventing ASF include confining pigs in pig-proof premises, limiting contact with external sources of infection, implementing basic hygienic measures and providing safe feed. Fly control should form part of the recommended hygienic measures although flies are unlikely to represent a major risk. A recent study excluded blowfly larvae as a source of infection.181 Although stable flies can transmit the virus mechanically ( see Epidemiology ), a significant role in spread of ASF is unlikely. The extent to which these measures can or will be applied is determined by the husbandry system, which in turn is usually determined by the resources available to the pig keepers.
The highest risk of exposure to ASF virus is in free-ranging systems that facilitate contact amongst domestic pigs of different origin and potentially infected wildlife, as well as scavenging.81, 296, 327, 429, 434 Confining pigs is facilitated by identifying low cost, locally available building materials and locally available forage and feeds in the form of agricultural by- and waste products that are safe.434 In parts of Africa, for example Mozambique, hedges consisting of prickly plants or barriers constructed from thorny vegetation are used to exclude wildlife and free-ranging livestock from premises where pigs or other livestock are kept. Rural pigs are often fed crop rests and forages, which are generally safe, although grass contaminated by a dead wild boar was incriminated in an ASF outbreak on a smallholder farm in Latvia.402 In urban and peri-urban settings where food waste is available to backyard pig producers with limited resources it is likely to be the food of choice for their pigs. The EU banned swill feeding after it was identified as the source of the 2001 introduction of foot and mouth disease to the United Kingdom, but the practice remains widespread and there is considerable pressure even in the EU to lift the ban and permit swill to be fed provided that it is rendered safe in terms of the agents of important pig diseases.26 Therefore, in practical terms, boiling swill for 30-60 minutes with periodic stirring is recommended and in some countries is included in legislation.26, 108, 164, 431 Processing waste food by drying and heat treatment to provide nutritious animal feed as a home-based or commercial industry could make feeding smallholder pigs more affordable and reduce the level of food wastage, which is a matter of concern globally.488 Commercial rations are generally considered safe but dried blood pig feeds used in China were found ASFV-positive on PCR.580
Where poverty or other adverse circumstances dictate that pig-keeping is only possible if the pigs are allowed at least partial freedom to roam, exploitation of the natural resistance to ASF that has been observed in areas where the disease is endemic in domestic pigs might be an option, although it is clear that this resistance is not simply inherited by offspring of resistant parents and may need an undesirable degree of inbreeding.432, 560
Managing ASF risk in trade
Various studies have been undertaken to assess the risks posed by trade in pigs and pork.139, 172, 243, 297, 307, 477, 478, 521 A stochastic model estimated the risk of spread between EU member states through free trade within the bloc to be low provided member states were aware of ASF and surveillance was adequate for early detection.389 In Africa, the risk of spread after an introduction has proven to be high.81, 490 Pigs are kept largely for income generation, providing a strong imperative to sell pigs to higher priced markets or to limit losses due to disease.434 When an ASF outbreak occurs, panic selling of pigs from affected herds, often targeting more distant markets, has been identified as a major risk for spread of ASF.119, 140, 174, 307, 383 It is a coping mechanism to offset expected losses due to ASF that may have far-reaching consequences like interruption of children ’s education due to inability to pay school fees and lack of funds to pay for other necessities including food. Since 2012 South Africa has experienced more extensive outbreaks outside the control area with spread through trade in domestic pigs and/or their products.210, 572 A study conducted among smallholder pig farmers in the Control Area in Limpopo province confirmed that pigs from the endemic area are routinely marketed at auction facilities outside the control area in spite of movement regulations.173 An outbreak on the north-eastern border of Zimbabwe in 2015 was attributed to cross-border trade in pigs from an endemic area of Mozambique where a larger than usual outbreak had occurred and a study in adjacent parts of Kenya and Uganda revealed that during an outbreak pigs are sold to markets that are further away from the usual ones.307, 559 Therefore risk mitigation along pig value chains and improving opportunities for safer marketing of pigs are important elements in better management of ASF.165, 169, 434
Preventing introduction of ASF into new areas
Widespread and badly managed ASF in Africa will always pose a risk to the rest of world.434 However, the introduction of ASF into Russia in 2007 with subsequent spread in western Russia and endemic establishment in the southern and central areas since 2011 induced a shift of focus from Africa to Russia and its neighbours in risk assessments for introduction of ASF into the EU and USA,116, 133, 258, 298, 376, 377, 389, 489 although one risk model included a high possibility of introduction with waste from ships originating Angola and Nigeria.377 Spread to a number of Eastern and Central European countries, most of them members of the EU that started with infection of Poland, Lithuania and Latvia in early 2014 added risk assessments focusing on wild boar but also low biosecurity farming systems and trade in pigs and pork.55, 119, 243, 283, 477, 478 There have also been further risk assessments for introduction into the USA and the possible consequences.215, 284, 595 By virtue of China ’s strong and growing connections with Africa, a risk assessment concluded that Africa remains a likely source of ASF for ‘the pig empire ’,563 but molecular investigation of recent Chinese isolates suggested an Eastern European origin for the 2018 introduction.44, 306, 599 However, experience to date has suggested that knowing the risks, although useful, will not necessarily prevent the introduction of ASF into new areas, and that anthropogenic factors, in particular illegal activities, are likely to drive the spread of ASF.
Managing ASF outbreaks
In the event of an outbreak, conventional control approaches include preventing movement of pigs and their products and stamping out of all infected and in-contact pigs, with proper disposal of carcasses by burning or deep burial, and disinfection of premises.163 To enable trade to continue when a limited outbreak occurs in an otherwise free country, a containment zone may be established according to guidelines provided by the OIE. ( http://www.oie.int/index.php?id=169 &L=0 &htmfile=chapitre_zoning_compartment.htm ) Implementation of these measures has to date not prevented continuation and spread of ASF in Europe and Asia.
Where outbreaks in Africa have been countered by movement control and stamping out, varying degrees of success have been achieved, since the efficacy of these measures depends upon how rigorously they can be applied.81, 431 Governments are often reluctant to commit funds to what is seen as a minor industry. Export to ASF-free countries from the region is minimal, as the free countries in the region have small pig populations without surplus for export and the few countries that do export pork or pigs have endemic ASF in wildlife or domestic pigs or both so compartments are usually the only option. When fragile livelihoods depend on producing and selling pigs, it is critical to avoid socio-economic catastrophe due either to the disease or to control.169, 430, 440 The Africa strategy is based on the principle that the aim of controlling ASF must always be to limit as much as possible pig mortality due either to ASF or to unnecessary destruction of healthy pigs.169 In order to achieve maximum producer co-operation, producers need to understand their role in the spread and in the prevention of ASF. If this can be accomplished, producer-based control systems become a real possibility, with the added advantage that the producers themselves become an intrinsic part of the surveillance and early warning system, which should eliminate the delays in diagnosis that usually complicate control. Conversely, measures that are negatively perceived by producers, such as stamping out without compensation and lengthy closure of markets are disincentives for reporting disease and often encourage clandestine and therefore risky trade. Studies have indicated that producer education and awareness are important but will not result in better control if the solutions to the ASF problem proposed are not feasible or acceptable for the producers, usually for economic reasons.104, 119 The strategy for Africa therefore considers a wide range of measures to enable national authorities to adopt approaches that are appropriate, cost-effective and feasible in their circumstances.169 The difficulties encountered in trying to control particularly the outbreaks in West Africa, as well as the successes, offered pointers to ways in which cost-effective control might be achieved.81
Quarantine and slaughter of infected herds with proper disposal of the carcasses and compensation of the owners remains the best option in an outbreak diagnosed in a commercial setting before significant spread has occurred.163 Stamping out of a single herd or only a few herds may be necessary, limiting the amount of compensation to be paid and the amount of pigs to be buried or burnt. Burial sites for carcasses of pigs that have died of disease as well as those slaughtered should be as close to the infected site as practically possible, to avoid moving carcasses over distances. Carcasses must be deeply buried after treatment with quicklime. Under some circumstances, or if the terrain does not permit deep burial, burning of carcasses may be necessary. The premises should be cleaned and disinfected immediately after depopulation. Disinfectants most frequently recommended are two per cent sodium hypochlorite or sodium hydroxide, detergents, and commercial virucidal disinfectants.
When an outbreak of ASF has become widespread or compensation for slaughter of healthy pigs in is not available, stamping out becomes impractical and is more likely to spread the disease than to eliminate it. Knowledge that compensation will be paid for pigs without clinical signs can encourage producer cooperation, but may not overcome their resistance to the prospect of having all the pigs killed to control the disease.320 The declaration of a containment zone in which all pigs are stamped out regardless of their health status can enable early declaration that the outbreak is over but it usually results in the elimination of unaffected pig farms with a high level of biosecurity that were not at risk, as happened in C ôte d ’Ivoire in 1996 and again in 2014.81 This is undesirable if export is not the issue, as it either carries high costs of compensation for healthy pigs or is completely unacceptable in the absence of compensation, and, with or without compensation, it is a disincentive to future investment in biosecurity. Under some circumstances replacement stock in lieu of financial recompense can be acceptable to producers.
Modified stamping out, i.e. culling of infected herds only or even infected houses on larger farms or, in some cases, clinically sick animals, with the proviso that quarantine will be maintained for the rest of the herd, is often an option because of the relatively slow spread of ASF. This approach succeeded in eradicating ASF from Ghana until it was reintroduced into a different area from a neighbouring country.81 The approach included authorizing the sale of pigs from healthy farms through approved outlets, which avoided welfare issues of pigs ‘piling up ’on farms due to movement restrictions, reduced the number of susceptible pigs and also reduced the temptation for producers to indulge in high risk clandestine trade.81
Indirect spread of ASFV during outbreaks may occur by dissemination of infected meat derived either from panic sales or from the carcasses of pigs culled for ASF control. Since wholesale destruction of meat perceived to be edible is impossible to justify in poor countries, the alternative of cooking the meat from apparently healthy slaughtered pigs should be explored, as it destroys the virus.430 This approach was perceived as ‘poorly effective and practical ’by a panel of experts focusing mainly on ASF in the European context, apparently due to food safety concerns,244 an opinion that does not take into account the extreme poverty that prevails in Africa, where meat not only from healthy pigs but also from pigs that have died of ASF is consumed because scarcity dictates that discarding food is forbidden.104 As meat that becomes available during ASF outbreaks will be eaten, recommending that it should be cooked before being sold could improve control without adding to the impoverishment of the pig producers. Spread by fomites should be prevented by prohibiting non-essential access to infected premises, effective disinfection of clothing, footwear and equipment of necessary visitors, e.g. veterinarians, and of vehicles used to transport infected pigs or material. Air- and water-borne transmission of ASFV only occurs where there is close contact with infected pigs so should not be responsible for spread between herds.231
The period for which premises should remain empty before restocking recommended by the OIE is 40 days. ( www.oie.int/index.php?id=0 &htmfile=chapitre_asf.htm ) In the past, periods as long as six months or even longer have been recommended.40, 81, 385, 481 Evidence suggests that such long periods are not necessary, since pigsties in the tropics were found to be safe after five days without disinfection,362, 459 and similar results were obtained (three to seven days) in Poland.399 Lengthy stoppages can be intolerable for producers dependent on pigs for necessary income and may result in perpetuation of the outbreak due to repopulation with pigs from infected herds. To ensure that premises area safe, sentinel pigs (i.e. fully susceptible, serologically negative pigs) can be introduced 30 days after depopulation with cleaning and disinfection at approximately 10 per cent of the stocking density (minimum two pigs) and allowed to range freely through the premises, with careful observation.163, 231 If after six weeks the pigs have not developed any signs of ASF and remain serologically negative, the farm may be fully restocked. Free-ranging sentinel pigs have also been used in villages, where the risk of residual infection in carelessly disposed remains of dead pigs is much higher.
Conclusion
An effective vaccine would be of inestimable value in managing ASF and eradicating the virus at least from domestic and possibly wild boar populations. Especially in Africa, it would be important for the vaccine to be sufficiently thermotolerant to remain viable in tropical climates under less than optimal cold chain conditions, to cross protect pigs against a wide range of viruses across the 24 genotypes known so far, and to be affordable to countries with limited resources. Increasingly promising developments have occurred in recent years.29, 31, 189, 361, 483
Until an effective vaccine becomes available, including an oral preparation for wild boars, prevention of ASF will depend upon the implementation of biosecurity measures, which in turn depends upon the commitment of producers. In low biosecurity husbandry systems this will require changes that are radical and can only be possible if they have clear financial benefits. Marketing in the pig sector in sub-Saharan Africa is largely disorganized and poorly supported in terms of infrastructure and access to market information.27, 166-168 Modernization of the pig sector will result in better management of ASF and even eventual eradication from domestic pigs but it will require investment in the identification and development of inclusive pig value chains to provide incentives for investment by producers and governments as well as non-governmental organizations, and is a vital goal of the strategy for control of ASF in Africa.169
References
- ABAD, J. M., PARIENTE, F., HERNANDEZ, F. &LORENZO, E., 1998. A quartz crystal microbalance assay for detection of antibodies against the recombinant swine fever virus attachment protein p12 in swine serum. Analytica Chimica Acta , 368, 183 –189.
- ABREU, E. F., DE VALAD ÃO, F. B., LIMPO SERRA, J. J. B., ORNELAS M ÁRIO, R. &SOUSA MONTENEGRO, A., 1962. Peste su ína africana em Mo çambique. Anais dos Servi ços Veterin árias de Mo çambique , 8, 105 –123.
- ACHENBACH, J. E., GALLARDO, C., NIETO-PELEGRIN, E., RIVERA-ARROYO, B., DEGEFA-NEGI, T., ARIAS, M., JENBERIE, S., MULISA, D. D., GIZAW, D., GELAYE, E., CHIBSSA, T. R., BELAYE, A., LOITSCH, A., FORSA, M., YAMI, M., DIALLO, A., SOLER, A., LAMIEN, C. E. &S ÁNCHEZ-VIZCA ÍNO, J. M., 2017. Identification of a new genotype of African swine fever virus in domestic pigs from Ethiopia. Transboundary and Emerging Diseases , 64(5), 1393-1404.
- ADKIN, A., COBURN, H., ENGLAND, T., HALL, S., HARTNETT, E., MAROONEY, C., WOOLDRIDGE, M., WATSON, E., COOPER, J., COX, T. &SEAMAN, M., 2004. Risk assessment for the import of contaminated meat and meat products into Great Britain and the subsequent exposure of GB livestock (IIRA): foot and mouth disease (FMD), African swine fever (ASF), classical swine fever (CSF), swine vesicular disease (SVD). Veterinary Laboratories Agency . New Haw.
- AFONSO, C. L., NEILAN, J. G., KUTISH, G. F. &ROCK, D. L., 1996. An African swine fever virus Bcl-2 homolog, 5-HL, suppresses apoptotic cell death. Journal of Virology, 70, 4858 –4863.
- AG ÜERO, M., FERN ÁNDEZ, J., ROMERO, L. J., ZAMORA, M. J., S ÁNCHEZ, C., BEL ÁK, S., ARIAS, M. &S ÁNCHEZ-VIZCA ÍNO, J. M., 2004. A highly sensitive and specific gel-based multiplex RT-PCR for the simultaneous and differential diagnosis of African swine fever and classical swine fever in clinical samples. Veterinary Research , 35, 551-563.
- AKOL, G. W. &LUBISI, B. A., 2010. Classical swine fever control in South Africa 2008-2009: results of the disease surveillance in the Eastern Cape province. Proceedings of the 9th Annual Congress of the Southern African Society for Veterinary Epidemiology and Preventive Medicine, 18-20 August 2010. Farm Inn, Pretoria, South Africa, 120-125. (http://sasvepm.org/wp-content/uploads/2016/05/proceedingsofthe9thsasvepmcongress.pdf )
- ALAWNEH, J. I., BARNES, T. S., PARKE, C., LAPUZ, E., DAVID, E., BASINANG, V., BALUYUT, A., VILLAR, E., LOPEZ, E. L. &BLACKALL, P. J., 2014. Description of the pig production systems, biosecurity practices and herd health providers in two provinces with high swine density in the Philippines. Preventive Veterinary Medicine , 114, 73-87.
- ALCAMI, A., ANGULO, A., LOPEZ-OTIN, C., MU ÑOZ, M., FREIJE, J. M. P., CARRASCOSA, A. L. &VI ÑUELA, E., 1992. Amino acid sequence and structural properties of protein p12, an African swine fever virus attachment protein. Journal of Virology, 66, 3860 –3868.
- ALCAMI, A., CARRASCOSA, L. &VI ÑUELA, E., 1990. Interaction of African swine fever virus with macrophages. Virus Research , 17, 93 –104.
- ALCARAZ, C., DE DIEGO, M., PASTOR, M. J. &ESCRIBANO, J. M., 1990. Comparison of a radioimmunoprecipitation assay to immunoblotting and ELISA for detection of antibody to African swine fever virus. Journal of Veterinary Diagnostic Investigation, 2, 191 –196.
- ALCARAZ, C., RODRIGUEZ, F., OVIEDO, J. M., EIRAZ, A., DE DIEGO, M., ALONSO, C. &ESCRIBANO, J. M., 1995. Highly specific confirmatory Western blot test for African swine fever virus antibody detection using the recombinant virus protein p54. Journal of Virological Methods, 52, 111 –119.
- ALEXANDER, F. C., 1992. Experiences with African swine fever in Haiti. Annals of the New York Academy of Science , 653, 251-256.
- ALKHAMIS, M. A., GALLARDO, C., JURADO, C., SOLER, A., ARIAS, M. &S ÁNCHEZ-VIZCA ÍNO, J. M., 2018. Phylodynamics and evolutionary epidemiology of African swine fever p72-CVR genes in Eurasia and Africa. PLoS One , 13, e0192565.
- ALLIANCE., G. A. S. F. R., 2018. African swine fever (ASF): Gap Analysis Workshop Report. Agricultural Research Service, Washington, D.C. (https://www.star-idaz.net/app/uploads/2018/11/GARA-Gap-Analysis-Report-2018.pdf ).
- ALONSO, C., BORCA, M., DIXON, L., REVILLA, Y., RODR ÍGUEZ, F., ESCRIBANO, J. M. &CONSORTIUM., I. R., 2018. ICTV Virus Taxonomy Profile. Asfarviridae. Journal of General Virology , 99, 613-614.
- ALONSO, F., DOMINGUEZ, J., VI ÑUELA, E. &REVILLA, Y., 1997. African swine fever virus-specific cytotoxic T lymphocytes recognize the 32 kDa immediate early protein (vp32). Virus Research, 49, 123 –130.
- AMILLS, M., RAM ÍREZ, O., GALMAN-OMITOGUN, O. &CLOP, A., 2013. Domestic pigs in Africa. African Archaeological Review , 30, 73-82.
- ANDERSON, E. C., HUTCHINGS, G. H., MUKARATI, N. &WILKINSON, P. J., 1998. African swine fever virus infection of the bushpig (Potamochoerus porcus ) and its significance in the epidemiology of the disease. Veterinary Microbiology , 62, 1 –15.
- ANDERSON, E. C., WILLIAMS, S. M., FISHER-HOCH, S. P. &WILKINSON, P. J., 1987. Arachidonic acid metabolites in the pathophysiology of thrombocytopenia and haemorrhage in acute African swine fever. Research in Veterinary Science , 42, 387 –394.
- ANDR ÉS, G., ALEJO, A., SIM ÓN-MATEO, C. &SALAS, M., 2001. African swine fever virus protease, a new viral member of the SUMO-1-specific protease family. Journal of Biological Chemistry, 276, 780 –787.
- ANDR ÉS, G., GARC ÍA-ESCUDERO, R., SALAS, M. L. &RODRIGUEZ, J. M., 2002. Repression of African swine fever virus polyprotein pp220-encoding gene leads to the assembly of icosahedral core-less particles. Journal of Virology, 76, 2654 –2666.
- ANDR ÉS, G., GARC ÍA-ESCUDERO, R., SIM ÓN-MATEO, C. &VI ÑUELA, E., 1998. African swine fever virus is enveloped by a two-membraned collapsed cisterna derived from the endoplasmic reticulum. Journal of Virology, 72, 8988 –9001.
- ANDR ÉS, G., SIMON-MATEO, C. &VI ÑUELA, E., 1997. Assembly of African swine fever virus: Role of polyprotein pp220. Journal of Virology, 71, 2331 –2341.
- ANGULO, A., ALCAMI, A. &VI ÑUELA, E., 1993. Virus-host interactions in African swine fever: The attachment to cellular receptors. In: KAADEN, O. R., EICHHORN, W. &CZERNY, C.P., (eds.). Unconventional agents and unclassified viruses: Archives of Virology , 7, 169 –183.
- ANON., 2016. Should swill feed be regulated in the EU? (viewed on 01 January 2018 at http://www.pigprogress.net/Nutrition/Articles/2016/3/Should-swill-feed-be-regulated-in-the-EU-2765056W/ ).
- ANTWI, M. &SEAHLODI, P., 2011. Marketing constraints facing emerging small-scale pig farmers in Gauteng Province, South Africa. Journal of Human Ecology , 36(1), 37-42.
- ARGILAGUET, J. M., P ÉREZ-MART ÍN, E., NOFRAR ÍAS, M., GALLARDO, C., ACCENSI, F., LACASTA, A., MORA, M., BALLESTER, M., GALINDO-CARDIEL, I., L ÓPEZ-SORIA, S., ESCRIBANO, J. M., RECHE, P. A. &RODR ÍGUEZ, F., 2012. DNA vaccination partially protects against African swine fever virus lethal challenge in the absence of antibodies. PLoS One , 7(9), e40942.
- ARIAS, M., DE LA TORRE, A., DIXON, L., GALLARDO, C., JORI, F., LADDOMADA, A., MARTINS, C., PARKHOUSE, R. M., REVILLA, Y., RODRIGUEZ, F. &SANCHEZ-VIZCAINO, J. M., 2017. Approaches and perspectives for development of African swine fever virus vaccines. Vaccine 5, 35.
- ARIAS, M., ESCRIBANO, J. M. &SANCHEZ-VIZCAINO, J. M., 1993. Persistence of African swine fever antibody reactivity on ELISA and immunoblotting assays. Veterinary Record, 133, 189 –190.
- ARIAS, M., JURADO, C., GALLARDO, C., FERN ÁNDEZ-PINERO, J. &S ÁNCHEZ-VIZCA ÍNO, J. M., 2018. Gaps in African swine fever: Analysis and priorities. Transboundary and Emerging Diseases , 65(1), 235-247.
- ARIAS, M. &S ÁNCHEZ-VIZCA ÍNO, J. M., 2002. African swine fever eradication: The Spanish model. In: MORILLA, A., YOON, K. J., ZIMMERMAN, J. J., (eds.). Trends in Emerging Viral Infections of Swine. Iowa State Press, Ames. 1, 133-139.
- ARNOT, L., DU TOIT, J. T. &BASTOS, A. D. S., 2009. Molecular monitoring of African swine fever virus using surveys targeted at adult Ornithodoros ticks: a re-evaluation of Mkuze Game Reserve, South Africa. Onderstepoort Journal of Veterinary Research , 76, 385-392.
- ATUHAIRE, D. K., AFAYOA, M., OCHWO, S., KATITI, D., MWIINE, F. N., NANTEZA, A., MUGASA, C. M., MATOVO, E., OKUNI, J. B., OLAHO-MUKANI, W. &OJOK, L., 2014. Comparative detection of African swine fever virus by loop-mediated isothermal amplification assay and polymerase chain reaction in domestic pigs in Uganda. African Journal of Microbiology Research ,8(23), 2322-2328.
- ATUHAIRE, D. K., AFAYOA, M., OCHWO, S., MWESIGWA, S., OKUNI, J. B., OLAHO-MUKANI, W. &OJOK, L., 2013. Molecular characterization and phylogenetic study of African swine fever isolates from recent outbreaks in Uganda (2010-2013). Virology Journal , 10, 247.
- AU-IBAR., 2011. Panafrican Animal Health Yearbook 2011. Interafrican Bureau for Animal Resources, Nairobi.
- AYOADE, G. O. &ADEYEMI, I. G., 2003. African swine fever: An overview. Revue d ’Élevage et M édecine V éterinaire des Pays Tropicaux , 56(3-4), 129-134.
- BABALOBI, O. O., OLUGASA, B. O., OLUWAYELU, D. O., IJAGBONE, I. F., AYOADE, G. O. &AGBEDE, S. A., 2007. Analysis and mortality losses of the 2001 African swine fever outbreak, Ibadan, Nigeria. Tropical Animal Health and Production , 39, 533-542.
- BAKKES, D. K., DE KLERK, D., LATIF, A. A. &MANS, B. J., 2018. Integrative taxonomy of Orhithodoros (Ornithodoros) (Acari: Ixodidae: Argasidae). Ticks and Tick-Borne Diseases , 9, 1006-1037.
- BALBO, S. &IANNIZZOTTO, G., 1983. Epidemiological investigation, prophylaxis and eradication of African swine fever in Malta. In: WILKINSON, P. J., (ed.). African Swine Fever . Commission of the European Communities, 42-48. EUR 8466 EN.
- BALLESTER, M., GALINDO-CARDIEL, I., GALLARDO, C., ARGILAGUET, J. M., SEGAL ÉS, J., RODR ÍGUEZ, J. M. &RODR ÍGUEZ, F., 2010. Intranuclear detection of African swine fever virus DNA in several cell types from formalin-fixed and paraffin-embedded tissues using a new in situ hybridisation protocol. Journal of Virological Methods , 168(1-2), 38-43.
- BAN-BO, B. A., IDRISS, O. A. &SQUARZONI, C. D., 2012. Controle de peste porcine africaine (PPA) dans les él évages traditionnels au Tchad. Journal of Animal and Plant Sciences ,15(3), 2261-2266.
- BANJARA, S., CARIA, S., DIXON, L. K., HINDS, M. G. &KVANSAKUL, M., 2017. Structural insight into African swine fever virus A179L-mediated apoptosis. Journal of Virology , 91(6), e0228-16.
- BAO, J., WANG, Q., LIN, P., LIU, C., LI, L., WU, X., CHI, T., XU, T., GE, S., LIU, Y., LI, J., WANG, S., QU, H., JIN, T. &WANG, Z., 2019. Genome comparison of African swine fever virus China/2018/AnhuiXCGQ strain and related European p72 genotype II strains. Transboundary and Emerging Diseases . E-pub ahead of print 13 January 2019. doi: 10.1111/TBED.13124.
- BARANDA, J. A., P ÉREZ-S ÁNCHEZ, R., OLEAGA, A., MANZANO, R. &ENCINAS-GRANDES, A., 2000. Purification, N-terminal sequencing and diagnostic value of the major antigens of Ornithodoros erraticus and Ornithodoros moubata. Veterinary Parasitology , 87, 193-206.
- BARANDA, J. A., P ÉREZ-S ÁNCHEZ, R., OLEAGA-P ÉREZ, A. &ENCINAS-GRANDES, A., 1997. Antigens of interest for the diagnosis of parasitism in pigs by Ornithodoros erraticus and Ornithodoros moubata. Journal of Parasitology , 83(5), 831-838.
- BARONGO, M. B., STAHL, K., BETT, B., BISHOP, R. P., F ÈVRE, E. M., ALIRO, T., OKOTH, E., MASEMBE, C., KNOBEL, D. &SSEMATIMBA, A., 2015. Estimating the basic reproductive number (R0 ) for African swine fever virus (ASFV) transmission between pig herds in Uganda. PLoS One, 10(5), e0125842.
- BASTO, A. P., PORTUGAL, R. S., NIX, R. J., CARTAXEIRO, C., BOINAS, F., DIXON, L. K., LEIT ÃO, A. &MARTINS, C., 2006. Development of a nested PCR and its internal control for the detection of African swine fever virus (ASFV) in Ornithodoros erraticus. Archives of Virology , 151(4), 819-826.
- BASTOS, A. D., ARNOT, L. F., JACQUIER, M. D. &MAREE, S., 2009. A host species-informative internal control for molecular assessment of African swine fever virus infection rates in the African sylvatic cycle Ornithodoros vector. Medical and Veterinary Entomology , 23(4), 399-409.
- BASTOS, A. D. S., PENRITH, M. L., CRUCI ÈRE, C., EDRICH, J. L., HUTCHINGS, G., ROGER, F., COUACY-HYMANN, E. &THOMSON, G. R., 2003. Genotyping field strains of African swine fever virus by partial p72 gene characterization. Archives of Virology, 148, 693 –706.
- BASTOS, A. D. S., PENRITH, M. L., MACOME, F., PINTO, F. &THOMSON, G. R., 2004. Co-circulation of two genetically distinct viruses in an outbreak of African swine fever in Mozambique: no evidence for individual infection. Veterinary Microbiology , 103, 169-182.
- BAUTISTA, M. J., G ÓMEZ-VILLAMANDOS, J. C., CARRASCO, L., RU ÍZ-VILLAMOR, E., SALGUERO, F. J. &SIERRA, M. A., 1998. Ultrastructure of the bone marrow in pigs inoculated with a moderately virulent strain (DR ’78) of African swine fever virus. Histology and Histopathology , 13(3), 713-720.
- BECH-NIELSEN, B., ARIAS, M. L., PANADERO, J., ESCRIBANO, J. M., GOMEZ-TEJEDOR, C., BONILLA, Q. P. &SANCHEZ-VIZCAINO, J. M., 1993. Laboratory diagnosis and disease occurrence in the current African swine fever eradication program in Spain. Preventive Veterinary Medicine, 17, 225 –234.
- BECH-NIELSEN, S., FERN ÁNDEZ, J., MART ÍNEZ-PEREDA, F., ESPINOSA, J., PEREZ BONILLA, Q. &S ÁNCHEZ-VIZCA ÍNO, J. M., 1995. A case study of an outbreak of African swine fever in Spain. British Veterinary Journal , 151(2), 203-214.
- BELLINI, S., RUTILI, D. &GUBERTI, V., 2016. Preventive measures aimed at minimizing the risk of African swine fever virus spread in pig farming systems. Acta Veterinaria Scandinavica , 58, 82.
- BELTR ÁN-ALCRUDO, D., ARIAS, M., GALLARDO, C., KRAMER, S. A. &PENRITH, M. L., 2017. African swine fever: Detection and diagnosis –A manual for veterinarians. FAO Animal Health and Production Manual No 19. Food and Agriculture Organization of the United Nations, Rome.
- BERNARD, J., HUTET, E., PABOEUF, F., RANDRIAMPARANY, T., HOLZMULLER, P., LANCELOT, R., RODRIGUES, V., VIAL, L. &LE POTIER, M. F., 2016. Effect of O. porcinus salivary gland extract on the African swine fever virus infection in the domestic pig. PLoS One ,11(2), e0147869.
- BIAGETTI, M., CUCCIOLONI, M., BONFILI, L., CECARINI, V., SEBASTIANI, C., CURCIO, L., GIAMMARIOLI, M., DE MIA, G. M., ELEUTERI, A. M. &ANGELETTI, M., 2018. Chimeric DNA/LNA-based biosensor for the rapid detection of African swine fever virus. Talanta ,184, 35-41.
- BIDJEH, K., BAN-BO, B. A. &MOPATE LOGTENE, Y., 2015. Factors contributing to the introduction and the spread of African swine fever in Chad. International Journal of Current Microbiology and Applied Sciences , 4(8), 607-613.
- BIRONT, P., CASTRYCK, F. &LEUNEN, J., 1987. An epizootic of African swine fever in Belgium and its eradication. Veterinary Record, 120, 432 –434.
- BISHOP, R. P., FLEISCHAUER, C., DE VILLIERS, E. P., OKOTH, E. A., ARIAS, M., GALLARDO, C. &UPTON, C., 2015. Comparative analysis of the complete genome sequences of Kenyan African swine fever isolates within p72 genotypes IX and X. Virus Genes , 50(2), 303-309.
- BLASCO, R., AGU ËRO, M., ALMENDRAL, J. M. &VI ÑUELA, E., 1989. Variable and constant regions in African swine fever virus DNA. Virology, 168, 330 –338.
- BLOME, S., GABRIEL, C. &BEER, M., 2013. Pathogenesis of African swine fever in domestic pigs and European wild boar. Virus Research , 173(1), 122-130.
- BLOME, S., GABRIEL, C., DIETZE, K., BREITHAUPT, A. &BEER, M., 2012. High virulence of African swine fever virus Caucasus isolate in European wild boars of all ages. Emerging Infectious Diseases , 18(4), 708.
- BLOME, S., GOLLER, K. V., PETROV, A., DR ÄGER, C., PIETSCHMANN, J. &BEER, M., 2014. Alternative sampling strategies for passive classical and African swine fever surveillance in wild boar –extension towards African swine fever virus antibody detection. Veterinary Microbiology , 174, 607-608.
- BOINAS, F., RIBEIRO, R., MADEIRA, S., PALMA, M., LOPES DE CARVALHO, I., N ÚNCIO, S. &WILSON, A. J., 2014. The medical and veterinary role of Ornithodoros erraticus complex ticks (Acari: Ixodida) on the Iberian Peninsula. Journal of Vector Ecology , 39(2), 238-248.
- BOINAS, F. S., HUTCHINGS, G. H., DIXON, L. K. &WILKINSON, P. J., 2004. Characterization of pathogenic and non-pathogenic African swine fever virus isolates from Ornithodoros erraticus inhabiting pig premises in Portugal. Journal of General Virology , 85, 2177-2187.
- BOINAS, F. S., WILSON, A. J., HUTCHINGS, G. H., MARTINS, C. &DIXON, L. K., 2011. The persistence of African swine fever virus in field-infected Ornithodoros erraticus during the ASF endemic period in Portugal. PLoS One , 6(5), e20383.
- BOOL, P. H., ORDAS, A. &SANCHEZ BOTIJA, C., 1969. Fluorescent antibody test for African swine fever. Bulletin de l ’Office International des Épizooties, 72, 819 –823.
- BOOMKER, J., HORAK, I. G., BOOYSE, D. G. &MEYER, S., 1991. Parasites of South African wildlife. VIII. Helminth and arthropod parasites of warthogs, Phacochoerus aethiopicus , in the eastern Transvaal. Onderstepoort Journal of Veterinary Research ,58, 195-202.
- BORCA, M. V., CARRILLO, C., ZSAK, L., LAEGREID, W. W., KUTISH, G. F., NEILAN, J. G., BURRAGE, T. G. &ROCK, D. L., 1998. Deletion of a CD2-like gene, 8-DR, from African swine fever virus affects viral infection in domestic swine. Journal of Virology , 72, 2881-2889.
- BORCA, M. V., IRUSTA, P., CARRILLO, C., AFONSO, C. L., BURRAGE, T. &ROCK, D. L., 1994. African swine fever virus structural protein p72 contains a conformational neutralizing epitope. Virology, 201, 413-418.
- BORCA, M. V., O ’DONNELL, V., HOLINKA, L. G., RAI, D. K., SANFORD, B., ALFANO, M., CARLSON, J., AZZINARO, P. A., ALONSO, C. &GLADUE, D. P., 2016. The Ep152R ORF of African swine fever virus strain Georgia encodes for an essential gene that interacts with host protein BAG6. Virus Research ,223, 181-189.
- BOSCH, J., IGLESIAS, I., MU ÑOZ, M. J. &DE LA TORRE, A., 2017. A cartographic tool for managing African swine fever in Eurasia: mapping wild boar distribution based on the quality of available habitats. Transboundary and Emerging Diseases , 64(6), 1720-1733.
- BOSCH, J., RODR ÍGUEZ, A., IGLESIAS, I., MU ÑOZ, M. J., JURADO, C., S ÁNCHEZ-VIZCA ÍNO, J. M. &DE LA TORRE, A., 2017. Update on the risk of introduction of African swine fever by wild boar into disease-free European Union countries. Transboundary and Emerging Diseases , 64(5), 1424-1432.
- BOSHOFF, C. I., BASTOS, A. D. S., DUBE, M. M. &HEATH, L., 2014. First molecular assessment of the African swine fever virus status of Ornithodoros ticks from Swaziland. Onderstepoort Journal of Veterinary Research , 81 (1), 846.
- BOSHOFF, C. I., BASTOS, A. D. S., GERBER, L. J. &VOSLOO, W., 2007. Genetic characterisation of African swine fever viruses from outbreaks in southern Africa (1973-1999). Veterinary Microbiology , 121, 45-55.
- BOULANGER, P., BANNISTER, G. L., GREIG, A. S., GRAY, D. P. &RUCKERBAUER, G. M., 1966. Diagnosis of African swine fever by immunofluorescence and other serological methods. Bulletin de l ’Office International des Épizooties, 66, 723 –739.
- BRAAE, U. C., JOHANSEN, M. V., NGOWI, H. A., RASMUSSEN, T. B., NIELSEN, J. &UTTENTHAL, Ǻ., 2015. Detection of African swine fever virus DNA in blood samples stored on FTA cards from asymptomatic pigs in Mbeya Region, Tanzania. Transboundary and Emerging Diseases , 62(1), 87-90.
- BREESE, S. S. &DE BOER, C. J., 1966. Electron microscope observations of African swine fever virus in tissue culture cells. Virology, 28, 420-428.
- BROWN, A. A., PENRITH, M. L., FASINA, F. O. &BELTR ÁN-ALCRUDO, D., 2017. The African swine fever epidemic in West Africa, 1996-2002. Transboundary and Emerging Diseases , 65(1), 64-76.
- BROWN, F., 1986. The classification and nomenclature of viruses: Summary of results of meeting of the International Committee of Taxonomy of Viruses in Senday, September 1984. Intervirology, 25, 141 –143.
- BURMAKINA, G., MALOGOLOVKIN, A., TULMAN, E. R., ZSAK, L., DELHON, G., DIEL, D. G., SHOBOGOROV, N. M., MORGUNOV, Y. P., MORGUNOV, S. Y., KUTISH, G. F., KOLBASOV, D. &ROCK, D. L., 2016. African swine fever serotype-specific proteins are significant protective antigens for African swine fever. Journal of General Virology , 97(7), 1670-1675.
- BURRAGE, T. G., 2013. African swine fever virus infection in Ornithodoros ticks. Virus Research ,173(1), 131-139.
- BUTLER, J. F., WILSON, D. D., GARRIS, G. I., KOCH, H. G., CRUM, J. M. &CASTELLANOS, V. E., 1985. Survey for potential soft tick (Acari: Argasidae) vectors of African swine fever on the island of Hispaniola. Experimental and Applied Acarology , 1(1), 63-72.
- CABALLERO, R. G. &TABAR ÉS, E., 1986. Application of p RPEL2 plasmid to detect African swine fever virus by DNA:DNA hybridisation. Archives of Virology , 87, 119 –125.
- CAEIRO, F., MEIRELES, M., RIBEIRO, G. &COSTA, J. V., 1990. In vitro DNA replication by cytoplasmic extracts from cells infected with African swine fever virus. Virology, 179, 87 –94.
- CAIADO, J. M., BOINAS, F. S. &LOUZA, A. C., 1988. Epidemiological research of African swine fever (ASF) in Portugal: the role of vectors and virus reservoirs. Acta Veterinaria Scandinavica , 84, 136-138.
- CAMACHO, A. &VI ÑUELA, E., 1991. Protein p22 of African swine fever virus. An early structural protein that is incorporated into the membrane of infected cells. Virology, 181, 251 –257.
- CANALS, A., ALONSO, F., TOMILLO, J. &DOMINGUEZ, J., 1992. Analysis of T lymphocyte subsets proliferating in response to infective and UV-inactivated African swine fever viruses. Veterinary Microbiology, 33, 117 –127.
- CANALS, A., DOMINGUEZ, J., TOMILLO, J., BABIN, M. &ALONSO, F., 1995. Inhibition of IL-2R and SLA class II expression on stimulated lymphocytes by a suppressor activity found in homogenates of African swine fever virus infected cultures. Archives of Virology, 140, 1075-1085.
- CANALS, A., OLEAGA, A., P ÉREZ, R., DOM ÍNGUEZ, J., ENCINAS, A. &S ÁNCHEZ-VIZCA ÍNO, J. M., 1990. Evaluation of an enzyme-linked immunosorbent assay to detect specific antibodies in pigs infested with the tick Ornithodoros erraticus (Argasidae). Veterinary Parasitology , 37, 145-153.
- CAPPAI, S., LOI, F., COCCOLONE, A., COCCO, M., FALCONI, C., DETTORI, G., FELIZIANO, F., SANNA, M. L., OGGIANO, A. &ROLESU, S., 2017. Evaluation of a commercial field test to detect African swine fever. Journal of Wildlife Diseases , 53(3), 602-606.
- CARGILL, C. &DAVIES, P. R., 2006. External parasites. In: STRAW, B. E., ZIMMERMAN, J. J., D ’ALLAIRE, S. &TAYLOR, D. J., (eds.). Diseases of Swine , 9th edn, 875-889. Iowa State University Press, Ames.
- CARLSON, J., ZANI, L., SCHWAIGER, T., NURMOJA, I., VILTROP, A., VILEM, A., BEER, M. &BLOME, S., 2018. Simplifying sampling for African swine fever surveillance: assessment of antibody and pathogen detection from blood swabs. Transboundary and Emerging Diseases , 65(1), e165-e172.
- CARPINTERO, R., ALONSO, C., PI ÑEIRO, M., ITURRALDE, M., ANDR ÉS, M., LE POTIER, M. F., MADEC, F., ÁLAVA, M. A., PI ÑEIRO, A. &LAMPREAVE, F., 2007. Pig major acute-phase protein and apolipoprotein A-I responses correlate with the clinical course of experimentally induced African swine fever and Aujeszky ’s disease. Veterinary Research , 38(5), 741-753.
- CARRASCO, L., CHACON-M DE LARA, F., GOMEZ-VILLAMANDOS, J. C. &BAUTISTA, M. J., 1996. The pathogenic role of pulmonary intravascular macrophages in acute African swine fever. Research in Veterinary Science , 61, 193 –198.
- CARRASCO, L., CHACON-M DE LARA, F., MARTIN DE LAS MULAS, J., GOMEZ-VILLAMANDOS, J. C., SIERRA, M. A., VILLEDA, C. J. &WILKINSON, P. J., 1997. Ultrastructural changes related to the lymph node haemorrhages in acute African swine fever. Research in Veterinary Science, 62, 199 –204.
- CARRASCO, L., G ÓMEZ-VILLAMANDOS, J. C., BAUTISTA, M. J., MARTIN DE LAS MULAS, J., VILLEDA, C. J., WILKINSON, P. J. &SIERRA, M. A., 1996. In vivo replication of African swine fever virus (Malawi ’83) in neutrophils. Veterinary Research , 27(1), 55-62.
- CARRASCO, L., NU ÑEZ, A., SALGUERO, F. J., DIAZ SAN SEGUNDO, F., S ÁNCHEZ-CORD ÓN, P., G ÓMEZ-VILLAMANDOS, J. C. &SIERRA, M. A., 2002. African swine fever: expression of interleukin-1 alpha and tumour necrosis factor-alpha by pulmonary intravascular macrophages. Journal of Comparative Pathology , 126(2-3), 194-201.
- CARRASCOSA, A. L., DEL VAL, M., SANTAR ÉN, J. F. &VI ÑUELA, E., 1985. Purification and properties of African swine fever virus. Journal of Virology, 54, 337 –344.
- CARRASCOSA, J. L., CARAZO, J. M., CARRASCOSA, A. L., GARCIA, N., SANTISTEBAN, A. &VI ÑUELA, E., 1984. General morphology and capsid fine structure of African swine fever virus particles. Virology, 132, 160 –172.
- CARRILLO, C., BORCA, M. V., AFONSO, C. L. O., D. V. &ROCK, D. L., 1994. Long-term persistent infection of swine monocytes/macrophages with African swine fever virus. Journal of Virology , 58, 580 –583.
- CHENAIS, E., BOQVIST, S., STERNBERG-LEWERIN, S., EMANUELSON, U., OUMA, E., DIONE, M., ALIRO, T., CRAFOORD, F., MASEMBE, C. &ST ÅHL, K., 2017. Knowledge, attitudes and practices related to African swine fever within smallholder pig production in northern Uganda. Transboundary and Emerging Diseases 64(1), 101-115.
- CHENAIS, E., ST ÅHL, K., GUBERTI, V. &DEPNER, K., 2018. Identification of wild boar - habitat epidemiologic cycle in African swine fever epizootic. Emerging Infectious Diseases , 24(4), 810-812.
- CHENAIS, E., STERNBERG-LEWERIN, S., BOQVIST, S., LIU, L., LEBLANC, N., ALIRO, T., MASEMBE, C. &ST ÅHL, K., 2017. African swine fever outbreak on a medium-sized farm in Uganda: biosecurity breaches and within-farm virus contamination. Tropical Animal Health and Production , 49(2), 337-346.
- CHILDERSTONE, A., TALAMATSU, H., YANG, H., DENVER, M. &PARKHOUSE, R. M. E., 1998. Modulation of T cell and monocyte function in the spleen following infection of pigs with African swine fever virus. Veterinary Immunology and Immunopathology, 52, 281-295.
- COBB, S. P., PHARO, H., STONE, M., GROENENDAAL, H. &ZAGMUTT, F. J., 2015. Quantitative risk assessment of the likelihood of introducing porcine reproductive and respiratory syndrome virus into New Zealand through the importation of pig meat. Revue scientifique et Technique, Office International des Épizooties , 34(3), 967-975.
- COGGINS, L., 1966. Growth and certain stability characteristics of African swine fever virus. American Journal of Veterinary Research , 27, 1351-1358.
- COGGINS, L., 1968. A modified haemadsorption-inhibition test for African swine fever virus. Bulletin of Epizootic Diseases of Africa , 16, 61 –64.
- COLGROVE, G., HAELTERMAN, E. O. &COGGINS, L., 1969. Pathogenesis of African swine fever in young pigs. American Journal of Veterinary Research, 30, 1343 –1359.
- COLGROVE, G. S., 1969. Diagnosis of African swine fever by fluorescent antibody staining of blood films and buffy coat smears. Bulletin of Epizootic Diseases of Africa , 17, 39 –44.
- CONCEI ÇÃO, J. M., 1949. Estudo das zoonoses porcinas de Angola. Pecu ária: Anais dos Servi ços Pecu ários da Col ónia de Angola, 1, 217-245.
- CONNOR, R. J. &VAN DEN BOSSCHE, P., 2004. African animal trypanosomes. In: COETZER, J. A. W., &TUSTIN, R. C., (eds.). Infectious Diseases of Livestock , 2nd edn, 1, 251-296. Oxford University Press, Cape Town.
- COSTA, J. V., 1990. African swine fever virus. In: DARAI, G., (ed.). Molecular Biology of Iridoviruses . Boston: Kluwer Academic Publishers.
- COSTARD, S., JONES, B. A., MART ÍNEZ-L ÓPEZ, B., MUR, L., DE LA TORRE, A., MART ÍNEZ, M., S ÁNCHEZ-VIZCA ÍNO, F., S ÁNCHEZ-VIZCA ÍNO, J. M., PFEIFFER, D. U. &WIELAND, B., 2013. Introduction of African swine fever into the European Union through illegal importation of pork and pork products. PLoS One , 8(4), e61104.
- COSTARD, S., PORPHYRE, V., MESSAD, S., RAKOTONDRAHANTA, S., VIDON, H., ROGER, F. &PFEIFFER, D. U., 2009. Multivariate analysis of management and biosecurity practices in smallholder pig farms in Madagascar. Preventive Veterinary Medicine , 92, 199-209.
- COSTARD, S., WIELAND, B., DE GLANVILLE, W., JORI, F., ROWLANDS, E., VOSLOO, W., ROGER, F., PFEIFFER, D. U. &DIXON, L. K., 2009. African swine fever: how can global spread be prevented? Philosophical Transactions of the Royal Society B , 364, 2683-2696.
- COSTARD, S., ZAGMUTT, F. J., PORPHYRE, T. &PFEIFFER, D. U., 2015. Small-scale pig farmers ’behaviour, silent release of African swine fever virus and consequences for disease spread. Scientific Reports ,5, 17074.
- COUACY-HYMANN, E., KOUAKOU, K. V., ACHENBACH, J. E., KOUADIO, L., KOFFI, Y. M., GODJI, H. P., ADJ É, K. E., OULAI, J., PELL-MINHIAUD, H. G. &LAMIEN, C. E., 2019. Re-emergence of genotype I of African swine fever virus in Ivory Coast. Transboundary and Emerging Diseases , 66(2), 882-896.
- COWAN, K. M., 1961. Immunologic studies on African swine fever virus. I. Elimination of the procomplementary activity of swine serum with formalin. Journal of Immunology , 86, 465-470.
- COWAN, K. M., 1963. Immunologic studies on African swine fever virus. II. Enhancing effect of normal bovine serum on the complement-fixation reaction. American Journal of Veterinary Research , 24, 756 –761.
- COX, B. F. &HESS, W. R., 1962. Notes on an African swine fever investigation in Nyasaland. Bulletin of Epizootic Diseases of Africa, 10, 439-440.
- CUBILLOS, C., G ÓMEZ-SEBASTIAN, S., MORENO, N., NU ÑEZ, M. C., MULUMBA-MFUMU, L. K., QUEMBO, C. J., HEATH, L., ETTER, E. M., JORI, F., ESCRIBANO, J. M. &BLANCO, E., 2013. African swine fever virus serodiagnosis: a general review with a focus on the analysis of African serum samples. Virus Research , 173(1), 159-167.
- D ’HUART, J. P. &GRUBB, P., 2001. Distribution of the common warthog (Phacochoerus africanus ) and the desert warthog (Phacochoerus aethiopicus ) in the Horn of Africa. African Journal of Ecology , 39, 156-169.
- DAVIES, K., GOATLEY, L. C., GUINAT, C., NETHERTON, C. L., GUBBINS, S., DIXON, L. K. &REIS, A. L., 2017. Survival of African swine fever virus in excretions of pigs experimentally infected with the Georgia 2007/1 isolate. Transboundary and Emerging Diseases , 64, 425-431.
- DE CARVALHO FERREIRA, H. C., BACKER, J. A., WEESENDORP, E., KLINKENBERG, D., STEGEMAN, J. A. &LOEFFEN, W. L. A., 2013. Transmission rate of African swine fever virus under experimental conditions. Veterinary Microbiology , 165, 296-304.
- DE CARVALHO FERREIRA, H. C., WEESENDORP, E., ELBERS, A. R., BOUMA, A., QUAK, S., STEGEMAN, J. A. &LOEFFEN, W. L. A., 2012. African swine fever virus excretion patterns in persistently infected animals: a quantitative approach. Veterinary Microbiology , 160(3-4), 327-340.
- DE CARVALHO FERREIRA, H. C., WEESENDORP, E., QUAK, S., STEGEMAN, J. A. &LOEFFEN, W. L., 2014. Suitability of faeces and tissue samples as a basis for non-invasive sampling for African swine fever virus in wild boar. Veterinary Microbiology , 172(3-4), 449-454.
- DE CARVALHO FERREIRA, H. C., WEESENDORP, E., QUAK, S., STEGEMAN, J. A. &LOEFFEN, W. L. A., 2013. Quantification of airborne African swine fever virus after experimental infection. Veterinary Microbiology ,165, 243-251.
- DE CARVALHO FERREIRA, H. C., Z ÚQUETE, S. T., WIJNVELD, M., WEESENDORP, E., JONGEJAN, F., STEGEMAN, A. &LOEFFEN, W. L. A., 2014. No evidence of African swine fever virus replication in hard ticks. Ticks and Tick-Borne Diseases ,5, 582-589.
- DE KOCK, G., ROBINSON, E. M. &KEPPEL, J. J. G., 1940. Swine fever in South Africa. Onderstepoort Journal of Veterinary Science and Animal Industry, 14, 31 –93.
- DE LA TORRE, A., BOSCH, J., IGLESIAS, I., MU ÑOZ., M. J., MUR, L., MART ÍNEZ-L ÓPEZ, B., MART ÍNEZ, M. &S ÁNCHEZ-VIZCA ÍNO, J. M., 2015. Assessing the risk of African swine fever introduction into the European Union by wild boar. Transboundary and Emerging Diseases ,62(3), 272-279.
- DE VILLIERS, E., GALLARDO, C., ARIAS, M., DA SILVA, M., UPTON, C., MARTIN, R. &BISHOP, R. P., 2010. Phylogenomic analysis of 11 complete African swine fever virus genome sequences. Virology , 400, 128-136.
- DETRAY, D. E., 1957. Persistence of viremia and immunity in African swine fever. American Journal of Veterinary Research ,18, 811-816.
- DETRAY, D. E., 1963. African swine fever. Advances in Veterinary Science and Comparative Medicine, 8, 299 –333.
- DETRAY, D. E. &SCOTT, G. R., 1957. Blood changes in swine with African swine fever. American Journal of Veterinary Research, 18, 484-490.
- D ÍAZ-MARTIN, V., MANZANO-ROMAN, R., SILES-LUCAS, M., OLEAGA, A. &P ÉREZ-S ÁNCHEZ, R., 2011. Cloning, characterization and diagnostic performance of the salivary lipocalin protein TSGP1 from Ornithodoros moubata . Veterinary Parasitology , 178, 163-172.
- DIONE, M., OUMA, E., OPIO, F., KAWUMA, B. &PEZO, D., 2016. Qualitative analysis of the risks and practices associated with the spread of African swine fever within the smallholder pig value chains in Uganda. Preventive Veterinary Medicine , 135, 102-112.
- DIONE, M. M., AKOL, J., ROESEL, K., KUNGU., J., OUMA, E. A., WIELAND, B. &PEZO, D., 2017. Risk factors for African swine fever in smallholder pig production systems in Uganda. Transboundary and Emerging Diseases , 64(3), 872-882.
- DIXON, L. K., ABRAMS, C. C., BOWICK, G., GOATLEY, L. C., KAY-JACKSON, P. C., CHAPMAN, D., LIVERANI, E., NIX, R., SILK, R. &ZHANG, F., 2004. African swine fever virus proteins involved in evading host defence systems. Veterinary Immunology and Immunopathology , 100, 117-134.
- DIXON, L. K., BAYLIS, S. A., VYDELINGUM, S., TWIGG, S. R. F., HAMMOND, J. M., HINGAMP, P. M., BRISTOW, C., WILKINSON, P. J. &SMITH, G. L., 1993. African swine fever virus genome content and variability. Archives of Virology, 7, 185-199.
- DIXON, L. K., CHAPMAN, D. A., NETHERTON, C. L. &UPTON, C., 2013. African swine fever replication and genomics. Virus Research , 173(1), 3-14.
- DIXON, L. K., ROCK, D. &VI ÑUELA, E., 1995. African swine fever-like viruses. In: MURPHY, F. A., FAUQUET, C. M., BISHOP, D. H. L., GHABRIAL, S. A., JARVIS, A. W., MARTELLI, G. P., MAYO, M. A. &SUMMERS, M. D., (eds.). 1995. Virus Taxonomy: Classification and Nomenclature of viruses (Sixth report of the International committee on taxonomy of viruses). Wien and New York: Springer-Verlag.
- DIXON, L. K., S ÁNCHEZ-CORD ÓN, P. J., GALINDO, I. &ALONSO, C., 2017. Investigations of pro- and anti-apoptotic factors affecting African swine fever virus replication and pathogenesis. Viruses, 9(9), e241.
- DIXON, L. K., TWIGG, S. R., BAYLIS, S. A., VYDELINGUM, S., BRISTOW, C., HAMMOND, J. M. &SMITH, G. L., 1994. Nucleotide sequence of a 55 kbp region from the right end of the genome of a pathogenic African swine fever virus isolate (Malawi LIL20/1). Journal of General Virology , 75, 1655-1684.
- DIXON, L. K., WILKINSON, P. J., SUMPTION, K. J. &EKUE, F., 1990. Diversity of the African swine fever virus genome. In: DARAI, G., (ed.). Molecular Biology of Iridoviruses . Boston, Dordrecht and London: Academic Publishers.
- DOUGHERTY, W. G. &SEMLER, B. L., 1993. Expression of virus-encoded proteinases: Functional and structural similarities with cellular enzymes. Microbiological Reviews, 57, 781-822.
- EDWARDS, J. F., DODDS, W. J. &SLAUSON, D. O., 1985. Mechanism of thrombocytopenia in African swine fever. American Journal of Veterinary Research , 46, 2058-2063.
- EDWARDS, R. G., 1983. The pathogenesis of thrombocytopenia and haemorrhage in African swine fever. Ph.D. Thesis, Cornell University, Ithaca, New York.
- EFSA., 2015. Scientific opinion on a request for a review of a scientific publication concerning the zoonotic potential of ovine scrapie prions. EFSA Journal , 13, 4197.
- EKUE, N. F. &WILKINSON, P. J., 1990. Absence of Ornithodoros moubata , the vector of African swine fever virus, from the main pig producing area of Cameroon. Tropical Animal Health and Production, 22, 127 –131.
- EKUE, N. F., WILKINSON, P. J. &WARDLEY, R. C., 1989. Infection of pigs with the Cameroon isolate (CAM/82) of African swine fever virus. Journal of Comparative Pathology , 100(2), 145-154.
- EL-HICHERI, K., GOMEZ-TEJEDOR, C., PENRITH, M. L., DAVIES, G., DOUATI, A., EDOUKOU, G. D. &WOJCIECHOWSKI, K., 1998. L ’epizootie de peste porcine africaine de 1996 en C ôte d ’Ivoire. Revue Scientifique et Technique, Office International des Epizooties, 17, 660 –673.
- ENDRIS, R. G., HASLETT, T. M., GEERING, G., HESS, W. R. &MONAHAN, M. J., 1981. A haemolymph test for the detection of African swine fever in Ornithodoros coriaceus (Acari: Argasidae). Journal of Medical Entomology, 24, 192 –197.
- ENDRIS, R. G., HASLETT, T. M. &HESS, W. R., 1992. African swine fever virus infection in the soft tick, Ornithodoros (Alectorobius) puertoricensis (Acari: Argasidae). Journal of Medical Entomology , 29(6), 990-994.
- ERICKSON, A., FISHER, M., FURUKAWA-STOFFER, T., AMBAGALA, A., HODKO, D., PASICK, J., KING, D. P., NFON, C., ORTEGA POLO, R. &LUNG, O., 2018. A multiplex reverse transcription PCR and automated electronic microarray assay for detection and differentiation of seven viruses affecting swine. Transboundary and Emerging Diseases , 65(2), e272-e283.
- ESCRIBANO, J. M., GALINDO, I. &ALONSO, C., 2013. Antibody-mediated neutralization of African swine fever virus: myths and facts. Virus Research , 173(1), 101-109.
- ESCRIBANO, J. M., PASTOR, M. J., ARIAS, M. &SANCHEZ-VIZCAINO, J. M., 1990. Confirmacion de sueros positivos a ELISA-peste porcina africana mediante la tecnica de ‘immunoblotting ’. Utilizacion de las proteinas inducidas por el virus, con pesos moleculares comprendidos entre 23 y 35 kilodaltons, en el desarrollo de un ‘kit ’de diagnostico. Medicina Veterinaria , 7, 135-138, 140-141.
- ESCRIBANO, J. M. &TABAR ÉS, E., 1987. Proteins specified by African swine fever virus. V. Identification of immediate early, early and late proteins. Archives of Virology, 92, 221-232.
- ESTEVES, A., MARQUES, M. I. &COSTA, J. V., 1986. Two-dimensional analysis of African swine fever virus 149. proteins and proteins induced in infected cells. Virology, 152, 192-206.
- ETTER, E. M. C., SECK, I., GROSBOIS, V., JORI, F., BLANCO, E., VIAL, L., AKAKPO, A. J., BADA-ALHAMBEDJI, R., KONE, P. &ROGER, F. L., 2011. Seroprevalence of African swine fever in Senegal, 2006. Emerging Infectious Diseases , 17, 49-54.
- FAO., 2009. Preparation of African swine fever contingency plans. In: PENRITH, M.L., GUBERTI, V., DEPNER, K. &LUBROTH, J., (eds.). FAO Animal Production and Health Manual, Food and Agriculture Organization of the United Nations, Rome, 8.
- FAO., 2010. Good practices for biosecurity in the pig sector –issues and options in developing and transit countries. FAO Animal Production and Health Paper. Food and Agriculture Organization of the United Nations, Rome, 169.
- FAO., 2011. A value chain approach to animal diseases risk management –Technical foundations and practical framework for application. Animal Production and Health Guidelines, Food and Agriculture Organization of the United Nations, Rome, 4.
- FAO., 2012a. Secteur porcin Burkina Faso. Revues nationales de l ’élevage de la division de la production et de la sant éanimales de la FAO. Food and Agriculture Organization of the United Nations, Rome, 1.
- FAO., 2012b. Secteur porcin Republique Democratique du Congo. Revues nationales de l ’élevage de la division de la production et de la sant éanimales de la FAO. Food and Agriculture Organization of the United Nations, Rome, 2.
- FAO., 2012c. Pig sector Kenya. FAO Animal Production and Health Livestock Country Reviews. Food and Agriculture Organization of the United Nations, Rome, 3.
- FAO/AU-IBAR/ILRI., 2017. Regional strategy for the control of African swine fever in Africa. Food and Agriculture Organization of the United Nations, Rome. (http://www.fao.org/3/a-i6053e.pdf )
- FARLOW, J., DONDUASHVILI, M., KOKHREIDZE, M., KOTORASHVILI, A., VEPHKVADZE, N. G., KOTARIA, N. &GULBANI, A., 2018. Intra-epidemic genome variation in highly pathogenic African swine fever virus (ASFV) from the country of Georgia. Virology Journal , 15, 190.
- FASINA, F. O., AGBAJE, M., AJANI, F. L., TALABI, O. A., LAZARUS, D. D., GALLARDO, C., THOMPSON, P. N. &BASTOS, A. D. S., 2012. Risk factors for farm-level African swine fever infection in major pig-producing areas in Nigeria, 1997 –2011. Preventive Veterinary Medicine , 107(1-2), 218-225.
- FASINA, F. O., LAZARUS, D. D., SPENCER, B. T., MAKINDE, A. A. &BASTOS, A. D. S., 2012. Cost implications of African swine fever in smallholder farrow-to-finish units: economic benefits of disease prevention through biosecurity. Transboundary and Emerging Diseases , 59, 244-255.
- FASINA, F. O., MOKOELE, J. M., SPENCER, B. T., VAN LEENGOED, L. A. M. L., BEVIS, Y. &BOOYSEN, I., 2015. Spatio-temporal patterns and movement analysis of pigs from smallholder farms and implications for African swine fever spread, Limpopo province, South Africa. Onderstepoort Journal of Veterinary Research, 82(1), 795.
- FASINA, F. O., SHAMAKI, D., MAKINDE, A. A., LOMBIN, L. H., LAZARUS, D. D., RUFAI, S. A., ADAMU, S. S., AGOM, D., PELAYO, V., SOLER, A., SIM ÓN, A., ADEDJI, A. A., YAKUBU, M. B., MANTIP, S., BENSHAK, A. J., OKEKE, I., ANAGOR, P., MANDENG, D. C., AKANBI, B. O., AJIBADE, A. A., FARAMADE, I., KAZEEM, M. M., ENURAH, L. U., BISHOP, R., ANCHUELO, R., MARTIN, J. H. &GALLARDO, C., 2010. Surveillance for African swine fever in Nigeria, 2006 –2009. Transboundary and Emerging Diseases , 57, 244-253.
- FAUQUET, C. M. &MAYO, M. A., 2001. The 7th ICTV report. Archives of Virology , 146, 189-194.
- FERNANDEZ, A., P ÉREZ, J., CARRASCO, L., BAUTISTA, M. J., SANCHEZ-VIZCAINO, J. M. &SIERRA, M., 1992. Distribution of ASFV antigens in pig tissues experimentally infected with two different Spanish virus isolates. Journal of Veterinary Medicine (B) , 39, 393-402.
- FERNANDEZ, A., P ÉREZ, J., CARRASCO, L., SIERRA, M. A., SANCHEZ-VIZCAINO, J. M. &JOVER, A., 1992. Detection of African swine fever viral antigens in paraffin-embedded tissues by use of immunohistologic methods and polyclonal antibodies. American Journal of Veterinary Research, 53, 1462-1467.
- FERN ÁNDEZ DE MARCO, M., SALGUERO, F. J., BAUTISTA, M. J., N ÚÑEZ, A., S ÁNCHEZ-CORD ÓN, P. J. &G ÓMEZ-VILLAMANDOS, J. C., 2007. An immunohistochemical study of the tonsils in pigs with acute African swine fever virus infection. Research in Veterinary Science , 83, 198-203.
- FISHBOURNE, E., HUTET, E., ABRAMS, C. C., CARIOLET, R., LE POTIER, M. F., TAKAMATSU, H. H. &DIXON, L. K., 2013. Increase in chemokines CXCL10 and CCL2 in blood from pigs infected with high compared to low virulence African swine fever isolates. Veterinary Research , 44, 87.
- FOIS, F., CULURGIONI, J., CAPPAI, S., MEREU PIRAS, P., TOMA, L., ROLESU, S. &LICIARDI, M., 2016. An overview on Sardinia ’s soft ticks (Ixodida: Argasidae). Experimental and Applied Acarology , 69, 225-232.
- FORTH, J. H., AMENDT, J., BLOME, S., DEPNER, K. &KAMPEN, H., 2017. Evaluation of blowfly larvae (Diptera: Calliphoridae) as possible reservoirs and mechanical vectors of African swine fever virus. Transboundary and Emerging Diseases , 65(1), e210-e213.
- FRANT, M., WOZNIAKOWSKI, G. &PEJSAK, Z., 2017. African swine fever (ASF) and ticks. No risk of tick-mediated ASF spread in Poland and Baltic states. Journal of Veterinary Research , 61, 375-380.
- FREIJE, J. M. P., MU ÑOZ, M., VI ÑUELA, E. &LOPEZ-OTIN, C., 1993. High-level expression in Escherichia coli of the gene coding for the major structural protein (p72) of African swine fever virus. Gene , 123, 259 –262.
- FREITAS, F. B., FROUCO, G., MARTINS, C. &FERREIRA, F., 2018. African swine fever virus encodes for an E2-ubiquitin conjugating enzyme that is mono- and di-ubiquitinated and required for viral replication cycle. Scientific Reports , 8, 3471.
- FREITAS, F. B., FROUCO, G., MARTINS, C., LEIT ÃO, A. &FERREIRA, F., 2016. In vitro inhibition of African swine fever virus-topoisomerase-II disrupts viral replication. Antiviral Research , 134, 34-41.
- FROUCO, G., FREITAS, F. B., COELHO, J., LEIT ÃO, A., MARTINS, C. &FERREIRA, F., 2017. DNA-binding properties of the African swine fever virus pA104R, a histone-like protein involved in viral replication and transcription. Journal of Virology , 91(12), e02498-16.
- GABRIEL, C., BLOME, S., MALOGOLOVKIN, A., PARILOV, S., KOLBASOV, D., TEIFKE, J. P. &BEER, M., 2011. Characterization of African swine fever virus Caucasus isolate in European wild boars. Emerging Infectious Diseases , 17(12), 2342-2345.
- GAGO DA CAMARA, J. N., 1933. Hist ória da peste su ína em Angola. Pecu ária: Anais dos Servi ços Pecu ários da Col ónia de Angola , 1, 25-40.
- GALINDO, I. &ALONSO, C., 2017. African swine fever virus: A review. Viruses , 9, 103.
- GALINDO, I., VI ÑUELA, E. &CARRASCOSA, A. L., 1997. Protein cell receptors mediate the saturable interaction of African swine fever virus attachment protein p12 with the surface of permissive cells. Virus Research , 49, 193 –204.
- GALINDO, I., VI ÑUELA, E. &CARRASCOSA, A. L., 2000. Characterization of the African swine fever virus protein p49: a new late structural polypeptide. Journal of General Virology , 81, 59 –65.
- GALINDO-CARDIEL, I., BALLESTER, M., SOLANES, D., NOFRAR ÍAS, M., L ÓPEZ-SORIA, S., ARGILAGUET, J. M., LACASTA, A., ACCENSI, F., RODR ÍGUEZ, F. &SEGAL ÉS, J., 2013. Standardization of pathological investigations in the framework of experimental ASFV infections. Virus Research , 173(1), 180-190.
- GALLARDO, C., ADEMUN, A. R., NIETO, R., NANTIMA, N., ARIAS, M., MART ÍN, E., PELAYO, V. &BISHOP, R. P., 2011. Genotyping of African swine fever virus (ASFV) isolates associated with disease outbreaks in Uganda in 2007. African Journal of Biotechnology , 10(17), 3488-3497.
- GALLARDO, C., ANCHUELO, R., PELAYO, V., POUDEVIGNE, F., TATI, L., NZOUSSI, J., BISHOP, R., P ÉREZ, C., SOLER, A., NIETO, R., MARTIN, H. &ARIAS, M., 2011. African swine fever virus p72 genotype IX in domestic pigs, Congo, 2009. Emerging Infectious Diseases , 17, 1556-1558.
- GALLARDO, C., FERN ÁNDEZ-PINERO, J., PELAYO, V., GAZAEV, I., MARKOWSKA-DANIEL, I., PRIDOTKAS, G., NIETO, R., FERN ÁNDEZ-PACHECO, P., BOKHAN, S., NEVOLKO, O., DROZHZHE, Z., P ÉREZ, C., SOLER, A., KOLBASOV, D. &ARIAS, M., 2014. Genetic variation among African swine fever genotype II viruses. Eastern and Central Europe. Emerging Infectious Diseases , 20(9), 1544-1547.
- GALLARDO, C., KALABEKOV, I., NIETO, R., YELSUKOVA, A., S ÍMON, A., TCYBANOV, S., KOLBASOV, D. &ARIAS, M., 2009. Genetic characterization of Caucasus African swine fever virus isolates. World Association of Veterinary Laboratory Diagnosticians –14th International Symposium, Madrid, Spain, 17-20 June 2009, 181.
- GALLARDO, C., NIETO, R., SOLER, A., PELAYO, V., FERN ÁNDEZ-PINERO, J., MARKOWSKA-DANIEL, I., PRIDOTKAS, G., NURMOJA, I., GRANTA, R., S ÍMON, A., P ÉREZ, C., MARTIN, E., FERN ÁNDEZ-PACHECO, P. &ARIAS, M., 2015. Assessment of African swine fever diagnostic techniques as a response to the epidemic outbreaks in the eastern European Union countries: how to improve surveillance and control programs. Journal of Clinical Microbiology , 53, 2555-2565.
- GALLARDO, C., NURMOJA, I., SOLER, A., DELICADO, V., SIM ÓN, A., MARTIN, E., PEREZ, C., NIETO, R. &ARIAS, M., 2018. Evolution in Europe of African swine fever genotype II viruses from highly to moderately virulent. Veterinary Microbiology , 219, 70-79.
- GALLARDO, C., OKOTH, E., PELAYO, V., ANCHUELO, R., MART ÍN, E., SIM ÓN, A., LLORENTE, A., NIETO, R., SOLER, A., MART ÍN, R., ARIAS, M. &BISHOP, R. P., 2011. African swine fever viruses with two different genotypes, both of which occur in domestic pigs, are associated with ticks and adult warthogs, respectively, at a single geographical site. Journal of General Virology ,92, 432-444.
- GALLARDO, C., REIS, A. L., KALEMA-ZIKUSOKA, G., MALTA, J., SOLER, A., BLANCO, E., PARKHOUSE, R. M. E. &LEIT ÃO, A., 2009. Recombinant antigen targets for serodiagnosis of African swine fever. Clinical and Vaccine Immunology , 16(7), 1012-1020.
- GALLARDO, C., SOLER, A., NIETO, R., CARRASCOSA, A. L., DE MIA, G. M., BISHOP, R. P., MARTINS, C., FASINA, F. O., COUACY-HYMMAN, E., HEATH, L., PELAYO, V., MART ÍN, E., SIM ÓN, A., MART ÍN, R., OKURUT, A. E., LEKOLOL, I., OKOTH, E. &ARIAS, M., 2013. Comparative evaluation of African swine fever virus (ASF) antibody detection techniques derived from specific ASF viral genotypes with the OIE internationally prescribed serological tests. Veterinary Microbiology ,162, 32-43.
- GALLARDO, C., SOLER, A., NIETO, R., S ÁNCHEZ, M. A., MARTINS, C., PELAYO, V., CARRASCOSA, A., REVILLA, Y., S ÍMON, A., BRIONES, V., S ÁNCHEZ-VIZCA ÍNO, J. M. &ARIAS, M., 2015. Experimental transmission of African swine fever (ASF) low virulent isolate NH/P68 by surviving pigs. Transboundary and Emerging Diseases ,62(6), 612-622.
- GALLARDO, C., SOLER, A., RODZE, I., NIETO, R., CANO-G ÓMEZ, C., FERNANDEZ-PINERO, J. &ARIAS, M., 2019. Attenuated and non-haemadsorbing (non-HAD) genotype II African swine fever virus (ASFV) isolated in Europe, Latvia 2017. Transboundary and Emerging Diseases , In Press. e-pub before print, doi: 10.1111/tbed.13132.
- GALLARDO, M. C., DE LA TORRE REOYO, A., FERN ÁNDEZ-PINERO, J., IGLESIAS, I., MU ÑOZ, M. J. &ARIAS, M. L., 2015. African swine fever: a global view of the current challenge. Porcine Health Management 1, 21.
- GALO, A. &PETISCA, N., 1990. Cellular localisation of African swine fever virus (ASFV) nucleic acid, using the in situ hybridisation in paraffin embedded tissue sections. Revista Portuguesa de Ciencias Veterin árias , 85, 493-494.
- GARCIA-BEATO, R., SALAS, M., VI ÑUELA, E. &SALAS, J., 1992. Role of the host cell nucleus in the replication of African swine fever virus DNA. Virology , 188, 637-649.
- GARIGLIANY, M., DESMECHT, D., TIGNON, M., CASSART, D., LESENFANT, C., PATERNOSTRE, J., VOLPE, R., CAY, A. B., VAN DEN BERG, T. &LINDEN, A., 2019. Phylogeographic analysis of African swine fever virus, Western Europe, 2018. Emerging Infectious Diseases , 25(1), 184-186.
- GAVIER-WID ÉN, D., ST ÅHL, K., NEIMANIS, A. S., H ÅRD AV SEGERSTAD, C., GORT ÁZAR, C., ROSSI, S. &KUIKEN, T., 2015. African swine fever in wild boar in Europe: a notable challenge. Veterinary Record , 176, 199-200.
- GE, S., LI, J., FAN, X., LIU, F., L., L., WANG, Q., REN, W., BAO, J., LIU, C., WANG, H., LIU, Y., ZHANG, Y., XU, T., WU, X. &WANG, Z., 2018. Molecular characterization of African swine fever virus, China, 2018. Emerging Infectious Diseases , 24(11), 2131-2133.
- GEERTSMA, P. J., MPOFU, D. &WALTERS, J., 2012. Investigation and control of an outbreak of African swine fever in the Gauteng Province in 2012. P roceedings of the 10th Annual Congress of the Southern African Society for Veterinary Epidemiology and Preventive Medicine, 1-3 August 2012, Farm Inn, South Africa, 17-21. (http://sasvepm.org/wp-content/uploads/2016/05/SASVEPM2012Proceedings.pdf ).
- GENOVESI, E. V., KNUDSEN, R. C., WHYARD, T. C. &MEBUS, C. A., 1988. Moderately virulent African swine fever virus infection: blood cell changes and infective virus distribution among blood components. American Journal of Veterinary Research , 49(3), 339-344.
- GIAMMARIOLI, M., GALLARDO, C., OGGIANO, A., ISCARO, C., NIETO, R., PELLEGRINI, C., DEI GIUDICI, S., ARIAS, M. &DE MIA, G. M., 2011. Genetic characterisation of African swine fever viruses from recent and historical outbreaks in Sardinia (1978-2009). Virus Genes , 42(3), 377-387.
- GOGIN, A., GERASIMOV, V., MALOGOLOVKIN, A. &KOLBASOV, D., 2013. African swine fever in the North Caucasus region and the Russian Federation in the years 2007-2012. Virus Research , 173(1), 198-203.
- GOLLER, K. V., MALOGOLOVKIN, A. S., KATORKIN, S., KOLBASOV, D., TITOV, I., H ÖPER, D., BEER, M., KEIL, G. M., PORTUGAL, R. &BLOME, S., 2015. Tandem repeat insertion in African swine fever virus, Russia, 2012. Emerging Infectious Diseases , 21(4), 731-732.
- GOLNAR, A. J., MARTIN, E., WORMINGTON, J. D., KADING, R. C., TEEL, P. D., HAMER, S. A. &HAMER, G. L., 2019. Reviewing the potential vectors and hosts of African swine fever virus transmission in the United States. Vector-borne and Zoonotic Diseases . In Press. e-pub ahead of print 20 February 2019; doi: 10.1089/vbz.2018.2387.
- G ÓMEZ DEL MORAL, M., ORTU ÑO, E., FERN ÁNDEZ-ZAPATERO, P., ALONSO, F., ALONSO, C., EZQUERRA, A. &DOM ÍNGUEZ, J., 1999. African swine fever infection induces tumor necrosis factor alpha production: implications in pathogenesis. Journal of Virology , 73(3), 2173-2180.
- GOMEZ-PUERTAS, P., RODRIGUEZ, F., OVIEDO, J. M., BRUN, A., ALONSO, C. &ESCRIBANO, J. M., 1998. The African swine fever virus proteins p54 and p30 are involved in two distinct steps of virus attachment and both contribute to the antibody-mediated protective immune response. Virology New York, 243, 451-471.
- GOMEZ-PUERTAS, P., RODRIGUEZ, F., OVIEDO, J. M., RAMIRO-IBA ÑEZ, F., RUIZ-GONZALVO, F., ALONSO, C. &ESCRIBANO, J. M., 1996. Neutralizing antibodies to different proteins of African swine fever virus inhibit both virus attachment and internalization. Journal of Virology , 70, 5689-5694.
- GOMEZ-VILLAMANDOS, J. C., BAUTISTA, M. J., CARRASCO, L., CABALLERO, M. J., HERVAS, J., VILLEDA, C. J., WILKINSON, P. J. &SIERRA, M. A., 1997. African swine fever virus infection of bone marrow: Lesions and pathogenesis. Veterinary Pathology, 34, 97-107.
- G ÓMEZ-VILLAMANDOS, J. C., BAUTISTA, M. J., CARRASCO, L., CHAC ÓN-MANRIQUE DE LARA, F., HERV ÁS., J., WILKINSON, P. J. &SIERRA, M. A., 1998. Thrombocytopenia associated with apoptotic megakaryocytes in a viral haemorrhagic syndrome induced by a moderately virulent strain of African swine fever virus. Journal of Comparative Pathology , 118(1), 1-13.
- G ÓMEZ-VILLAMANDOS, J. C., BAUTISTA, M. J., S ÁNCHEZ-CORD ÓN, P. J. &CARRASCO, L., 2013. Pathology of African swine fever: the role of monocyte-macrophage. Virus Research , 173(1), 140-149.
- GOMEZ-VILLAMANDOS, J. C., HERVAS, J., M ÉNDEZ, A., CARRASCO, L., MARTIN DE LAS MULAS, J., VILLEDA, C. J., WILKINSON, P. J. &SIERRA, M. A., 1995. Experimental African swine fever: Apoptosis of lymphocytes and virus replication in other cells. Journal of General Virology, 76, 2399-2405.
- GOMEZ-VILLAMANDOS, J. C., HERVAS, J., M ÉNDEZ, A., CARRASCO, L., VILLEDA, C. J., WILKINSON, P. J. &SIERRA, M. A., 1995. Pathological changes in the renal interstitial capillaries of pigs inoculated with two different strains of African swine fever virus. Journal of Comparative Pathology, 112, 283-298.
- GOMEZ-VILLAMANDOS, J. C., HERVAS, J., M ÉNDEZ, A., CARRASCO, L., VILLEDA, C. J., WILKINSON, P. J. &SIERRA, M. A., 1995. A pathological study of the perisinusoidal unit of the liver in acute African swine fever. Research in Veterinary Science, 59, 146-151.
- GOMEZ-VILLAMANDOS, J. C., HERVAS, J., M ÉNDEZ, A., CARRASCO, L., VILLEDA, C. J., WILKINSON, P. J. &SIERRA, M. A., 1995. Ultrastructural study of the renal tubular system in acute experimental African swine fever: Virus replication in glomerular mesangial cells and in the collecting ducts. Archives of Virology , 140, 581-589.
- GONZAGUE, M., ROGER, F., BASTOS, A., BURGER, C., RANDRIAMPANARY, T., SMONDACK, S. &CRUCI ÈRE, C., 2001. Isolation of a non-haemadsorbing, non-cytopathic strain of African swine fever virus in Madagascar. Epidemiology &Infection , 126, 453-459.
- GONZALEZ, A., TALAVERA, A., ALMENDRAL, J. M. &VI ÑUELA, E., 1986. Hairpin loop structure of African swine fever virus DNA. Nucleic Acids Research , 14, 6835-6844.
- GONZALEZ, S., MENDOZA, C., SANCHEZ-VIZCAINO, J. M. &ALONSO, F., 1990. Inhibitory effect of African swine fever virus on lectin-dependent swine lymphocyte proliferation. Veterinary Immunology and Immunopathology, 26, 71-80.
- GOORHA, R. &GRANOFF, A., 1979. Icosahedral cytoplasmic deoxyviruses. Newly characterised vertebrate viruses. Comparative Virology , 14, 367-369.
- GRAU, F. R., SCHROEDER, M. E., MULHERN, E. L., MCINTOSH, M. T. &BOUNPHENG, M. A., 2015. Detection of African swine fever, classical swine fever, and foot-and-mouth disease viruses by multiplex reverse transcription real-time polymerase chain reaction. Journal of Veterinary Diagnostic Investigation , 27(2), 140-149.
- GRAU, G. E. &LOU, J., 1993. TNF in vascular pathology: the importance of platelet-endothelium interactions. Research in Immunology, 144, 355-363.
- GREEN, B. L., 2007. The missing calculation: the human cost. Veterinaria italiana , 43(2), 299-301.
- GREGG, D. A., MEBUS, C. A. &SCHLAFER, D. H., 1995. African swine fever virus interference with foot-and-mouth disease infection and seroconversion in pigs. Journal of Veterinary Diagnostic Investigation , 7(1), 31-43.
- GREGG, D. A., MEBUS, C. A. &SCHLAFER, D. H., 1995. Early infection of interdigitating dendritic cells in the pig lymph node with African swine fever viruses of high and low virulence: immunohistochemical and ultrastructural studies. Journal of Veterinary Diagnostic Investigation, 7, 23-30.
- GREGG, D. A., SCHLAFER, D. H. &MEBUS, C. A., 1995. African swine fever virus infection of skin-derived dendritic cells in vitro causes interference with subsequent foot-and-mouth disease infection. Journal of Veterinary Diagnostic Investigation, 7(1), 44-51.
- GREIG, A., 1972. Pathogenesis of African swine fever in pigs naturally exposed to the disease. Journal of Comparative Pathology , 82, 73-79.
- GREIG, A. &PLOWRIGHT, W., 1970. The excretion of two virulent strains of African swine fever virus by domestic pigs. Journal of Hygiene, Cambridge, 68, 673-682.
- GROOCOCK, C. M., HESS, W. R. &GLADNEY, W. J., 1980. Experimental transmission of African swine fever virus by Ornithodoros coriaceus , an argasid tick indigenous to the United States. American Journal of Veterinary Research , 41, 591-594.
- GUINAT, C., GOGIN, A., BLOME, S., KEIL, G., POLLIN, R., PFEIFFER, D. U. &DIXON, L., 2016. Transmission routes of African swine fever virus to domestic pigs: current knowledge and future research directions. Veterinary Record , 178, 262-267.
- GUINAT, C., GUBBINS, S., VERGNE, T., GONZALES, J. L., DIXON, L. &PFEIFFER, D. U., 2016c. Experimental pig-to-pig transmission dynamics for African swine fever virus, Georgia 2007/1 strain. Epidemiology and Infection 144, 25-34.
- GUINAT, C., PORPHYRE, T., GOGIN, A., DIXON, L., PFEIFFER, D. U. &GUBBINS, S., 2018. Inferring within-herd transmission parameters for African swine fever virus using mortality data from outbreaks in the Russian Federation. Transboundary and Emerging Diseases , 65, e264-e271.
- GUINAT, C., REIS, A. L., NETHERTON, C. L., GOATLEY, L., PFEIFFER, D. U. &DIXON, L., 2014. Dynamics of African swine fever virus shedding and excretion in domestic pigs infected by intramuscular inoculation and contact transmission. Veterinary Research , 45, 93.
- GUINAT, C., RELUN, A., WALL, B., MORRIS, A., DIXON, L. &PFEIFFER, D. U., 2016. Exploring pig trade patterns to inform the design of risk-based disease surveillance and control strategies. Scientific Reports , 6, 28429.
- GUINAT, C., VERGNE, T., JURADO-DIAZ, C., S ÁNCHEZ-VIZCA ÍNO, J. M., DIXON, L. &PFEIFFER, D. U., 2017. Effectiveness and practicality of control strategies for African swine fever: what do we really know? Veterinary Record , 180(4), 97.
- GULENKIN, V. M., KORENNOY, F. I., KARAULOV, A. K. &DUDNIKOV, S. A., 2011. Cartographical analysis of African swine fever outbreaks in the territory of the Russian Federation and computer modeling of the basic reproduction ratio. Preventive Veterinary Medicine , 102(3), 167-174.
- HAINES, F. J., HOFMANN, M. A., KING, D. P., DREW, T. W. &CROOKE, H. R., 2013. Development and validation of a multiplex, real-time RTPCR assay for the simultaneous detection of classical and African swine fever viruses. PLoS One , 8(7), e71019.
- HAMDY, F. M., COLGROVE, G. S., DE RODRIGUES, E. M., SNYDER, M. L. &STEWART, W. C., 1981. Field evaluation of enzyme-linked immunosorbent assay for detection of antibody to African swine fever virus. American Journal of Veterinary Research , 42, 1441-1443.
- HAMDY, F. M. &DARDIRI, A. H., 1984. Clinical and immunologic responses of pigs to African swine fever virus isolated from the Western Hemisphere. American Journal of Veterinary Research, 45, 711-714.
- HARESNAPE, J. M., 1984. African swine fever in Malawi. Tropical Animal Health and Production, 16, 123-125.
- HARESNAPE, J. M., LUNGU, S. A. M. &MAMU, F. D., 1985. A four-year survey of African swine fever in Malawi. Journal of Hygiene, Cambridge , 95, 309-323.
- HARESNAPE, J. M., LUNGU, S. A. M. &MAMU, F. D., 1987. An updated survey of African swine fever in Malawi. Epidemiology and Infection , 99, 723-732.
- HARESNAPE, J. M. &MAMU, F. D., 1986. The distribution of ticks of the Ornithodoros moubata complex (Ixodoidea: Argasidae) in Malawi and its relation to African swine fever epizootiology. Journal of Hygiene, Cambridge , 96, 535-544.
- HARESNAPE, J. M. &WILKINSON, P. J., 1988. A study of African swine fever virus infected ticks (Ornithodoros moubata ) collected from three villages in the ASF enzootic area of Malawi following an outbreak of the disease in domestic pigs. Epidemiology and Infection, 102, 507-522.
- HARESNAPE, J. M., WILKINSON, P. J. &MELLOR, P. S., 1988. Isolation of African swine fever virus from ticks of the Ornithodoros moubata complex (Ixodoidea: Argasidae) collected within the African swine fever enzootic area of Malawi. Epidemiology and Infection , 101, 173-185.
- HAWES, P. C., NETHERTON, C. L., WILEMAN, T. E. &MONAGHAN, P., 2008. The envelope of intracellular African swine fever virus is composed of a single lipid bilayer. Journal of Virology, 82(16), 7905-7912.
- HENNING, M. W., 1956. Animal Diseases in South Africa. 3rd edn. Pretoria, South Africa: Central News Agency Ltd.
- HERN ÁEZ, B., GUERRA, M., SALAS, M. L. &ANDR ÉS, G., 2016. African swine fever virus undergoes outer envelope disruption, capsid disassembly and inner envelope fusion before core release from multivesicular endosomes. PLoS Pathogens , 12(4), e1005595.
- HERRERA-IBAT Á, D. M., MART ÍNEZ-L ÓPEZ, B., KIJADA, D., BURTON, K. &MUR, L., 2017. Quantitative approach for the risk assessment of African swine fever and classical swine fever introduction into the United States through legal imports of pigs and swine products. PLoS ONE , 12(8), e0182850.
- HESS, W. R., 1971. African swine fever. Virology Monographs , 9, 1 –33.
- HESS, W. R., 1981. African swine fever —a reassessment. Advances in Veterinary Science and Comparative Medicine , 25, 39-69.
- HESS, W. R., ENDRIS, R. G., HASLETT, T. M., MONAHAM, M. J. &MCCOY, J. P., 1987. Potential arthropod vectors of African swine fever virus in North America and the Caribbean basin. Veterinary Parasitology, 26, 145-155.
- HEUSCHELE, W. P., 1967. Studies on the pathogenesis of African swine fever. 1. Quantitative studies on the sequential development of virus in pig tissues. Archiv f ür die gesamte Virusforschung , 21, 349-356.
- HEUSCHELE, W. P. &BARBER, T. L., 1966. Changes in certain blood components of rinderpest-infected cattle. American Journal of Veterinary Research , 27, 1001 –1006.
- HEUSCHELE, W. P. &COGGINS, L., 1965. Isolation of African swine fever from a giant forest hog. Bulletin of Epizootic Diseases of Africa, 13, 255-256.
- HEUSCHELE, W. P. &COGGINS, L., 1965. Studies on the transmission of African swine fever by arthropods. Sixty-ninth Annual Proceedings of the United States Livestock Sanitary Association , 94-100.
- HEUSCHELE, W. P. &COGGINS, L., 1969. Epizootiology of African swine fever in warthogs. Bulletin of Epizootic Diseases of Africa, 17, 179-183.
- HEUSCHELE, W. P. &HESS, W. R., 1973. Diagnosis of African swine fever by immunofluorescence. Tropical Animal Health and Production, 5, 181-186.
- HJERTNER, B., MEEHAN, B., MCKILLEN, J., MCNEILLY, F. &BEL ÁK, S., 2005. Adaptation of an Invader ®assay for the detection of African swine fever virus DNA. Journal of Virological Methods , 124, 1-10.
- HORAK, I. G., BOOMKER, J., DE VOS, V. &POTGIETER, F. T., 1988. Parasites of domestic and wild animals in South Africa. XXIII. Helminth and arthropod parasites of warthogs, Phacochoerus aethiopicus , in the eastern Transvaal Lowveld. Onderstepoort Journal of Veterinary Research , 55, 145-152.
- HOWEY, E. B., O ’DONNELL, V., DE CARVALHO FERREIRA, H. C., BORCA, M. V. &ARZT, J., 2013. Pathogenesis of highly virulent African swine fever virus in domestic pigs exposed via intraoropharyngeal, intranasopharyngeal, and intramuscular inoculation, and by direct contact with infected pigs. Virus Research ,178(2), 328-339.
- HU, J. J., WEN, T., CHEN, X. W., LIU, T. T., ESCH, G. W. &HUANG, S., 2016. Prevalance, morphology, and molecular characterization of Sarcocystis heydorni sarcocysts from cattle (Bos taurus ) in china. Journal of Parasitology , 102, 545-548.
- HU, L., LIN, X. Y., YANG, Z. X., YAO, X. P., LI, G. L., PENG, S. Z. &YANG, Y., 2015. A multiplex PCR for simultaneous detection of classical swine fever virus, African swine fever virus, highly pathogenic porcine reproductive and respiratory syndrome virus, porcine reproductive and respiratory syndrome virus and pseudorabies in swine. Polish Journal of Veterinary Sciences , 18(4), 715-723.
- HUANG, Z. Y. X., VAN LANGEVELDE, F., HONER, K. J., NAGUIB, M. &DE BOER, W. F., 2017. Regional level risk factors associated with the occurrence of African swine fever in West and East Africa. Parasites and Vectors , 10, 16.
- IGLESIAS, I., MU ÑOZ, M. J., MONTES, F., PEREZ, A., GOGIN, A., KOLBASOV, D. &DE LA TORRE, A., 2016. Reproductive ratio for the local spread of African swine fever in wild boars in the Russian Federation. Transboundary and Emerging Diseases ,63(6), e237-e245.
- IGLESIAS, I., RODR ÍGUEZ, A., FELIZIANI, F., ROLESU, S. &DE LA TORRE, A., 2017. Spatio-temporal analysis of African swine fever in Sardinia (2012-2014): trends in domestic pigs and wild boar. Transboundary and Emerging Diseases , 64(2), 656-662.
- IRUSTA, P. M., BORCA, M. V., KUTISH, G. F., LU, Z., CALER, E., CARRILLO, C. &ROCK, D. L., 1996. Amino acid tandem repeats within a late viral gene define the central variable region of African swine fever virus. Virology, 220, 20-27.
- JAMES, H. E., EBERT, K., MCGONIGLE, R., REID, S. M., BOONHAM, N., TOMLINSON, J. A., HUTCHINGS, G. H., DENYER, M., OURA, C. A., DUKES, J. P. &KING, D. P., 2010. Detection of African swine fever virus by loop-mediated isothermal amplification. Journal of Virological Methods , 164(1-2), 68-74.
- JANCOVICH, J. K., CHAPMAN, D., HANSEN, D. T., ROBIDA, M. D., LOSKUTOV, A., CRACIUNESCU, F., BOROVKOV, A., KIBLER, K., GOATLEY, L., KING, K., NETHERTON, C. L., TAYLOR, G., JACOBS, B., SYKES, K. &DIXON, L. K., 2018. Immunization of pigs by DNA prime and recombinant vaccinia virus boost to identify and rank African swine fever virus iummunogenic and protective proteins. Journal of Virology , 92(8), e02219-17.
- JORDT, A. M., LANGE, M., KRAMER-SCHADT, S., NIELSEN, L. H., NIELSEN, S. S., THULKE, H. H., VEJRE, H. &ALBAN, L., 2016. Spatio-temporal modeling of the invasive potential of wild boar –a conflict-prone species –using multi-source citizen science data. Preventive Veterinary Medicine , 124, 34-44.
- JORI, F. &BASTOS, A. D. S., 2009. Role of wild suids in the epidemiology of African swine fever. EcoHealth , 6, 296-310.
- JORI, F., VIAL, L., PENRITH, M. L., P ÈREZ-S ÁNCHEZ, R., ETTER, E., ALBINA, E., MICHAUD, V. &ROGER, F., 2013. Review of the sylvatic cycle of African swine fever in sub-Saharan Africa and the Indian Ocean. Virus Research , 173, 212-227.
- JURADO, C., FERN ÁNDEZ-CARRI ÓN, E., MUR, L., ROLESU, S., LADDOMADA, A. &S ÁNCHEZ-VIZCA ÍNO, J. M., 2018. Why is African swine fever still present in Sardinia? Transboundary and Emerging Diseases , 65(2), 557-566.
- JURADO, C., MART ÍNEZ-AVIL ÉS, M., DE LA TORRE, A., STUKELJ, M., DE CARVALHO FERREIRA, H., CERIOLI, M., S ÁNCHEZ-VIZCA ÍNO, J. M. &BELLINI, S., 2018. Relevant measures to prevent the spread of African swine fever in the European Union domestic pig sector. Frontiers in Veterinary Science , 5, 77
- JURADO, C., PATERNOSTER, G., MART ÍNEZ-L ÓPEZ, B., BURTON, K. &MUR, L., 2019. Could African swine fever and classical swine fever viruses enter into the United States via swine products carried in air passengers' luggage? Transboundary and Emerging Diseases ,66 (1), 166-180.
- KABUUKA, T., KASAIJA, P. D., MULINDWA, H., SHITTU, A., BASTOS, A. D. S. &FASINA, F. O., 2014. Drivers and risk factors for circulating African swine fever virus in Uganda, 2012-2013. Research in Veterinary Science , 97, 218-225.
- KARALYAN, Z. R., TER-POGOSSYAN, Z. R., KARALYAN, N. Y., SEMERJYAN, Z. B., TATOYAN, M. R., KARAPETYAN, S. A. &KARALOVA, E. M., 2017. Hemophagocytic lymphohistiocytosis in acute African swine fever clinic. Veterinary Immunology and Immunopathology ,187, 62-68.
- KARNIYCHUK, U. U., GELDHOF, M., VANHEE, M., VAN DOORSSELAERE, J., SAVELEVA, T. A. &NAUWYNCK, H. J., 2010. Pathogenesis and antigenic characterization of a new East European subtype 3 porcine reproductive and respiratory syndrome isolate. BMC Veterinary Research , 6, 30.
- KLEIBOEKER, S. B., 2002. Swine fever: classical swine fever and African swine fever. Veterinary Clinics of North America: Food Animal Practice ,18, 431-451.
- KLEIBOEKER, S. B., BURRAGE, T. G., SCOLES, G. A., FISH, D. &ROCK, D. L., 1998. African swine fever virus infection in the argasid host, Ornithodoros porcinus porcinus. Journal of Virology , 72, 1711-1724.
- KLEIBOEKER, S. B. &SCOLES, G. A., 2001. Pathogenesis of African swine fever virus in Ornithodoros ticks. Animal Health Research Reviews , 2, 121-128.
- KLEIBOEKER, S. B., SCOLES, G. A., BURRAGE, T. G. &SUR, J. H., 1999. African swine fever virus replication in the midgut epithelium is required for infection of Ornithodoros ticks. Journal of Virology ,73(10), 8587-8598.
- KOLBASOV, D., TITOV, I., TSYBANOV, S., GOGIN, A. &MALAGOLOVKIN, A., 2018. African swine fever virus, Siberia, 2017. Emerging Infectious Diseases , 24(4), 796-798.
- KORENNOY, F. I., GULENKIN, V. M., GOGIN, A. E., VERGNE, T. &KARAULOV, A. K., 2017. Estimating the basic reproductive number for African swine fever using the Ukrainian historical epidemic of 1977. Transboundary and Emerging Diseases , 64(6), 1858-1866.
- KOUAKOU, K. V., MICHAUD, V., BIEGO, H. G., GNABRO, H. P. G., KOUAKOU, A. V., MOSSOUN, A. M., AWUNI, J. A., MINOUNGOU, G. L., APLOGAN, G. L., AWOUM É, F. K., ALBINA, E., LANCELOT, R. &COUACY-HYMANN, E., 2017. African and classical swine fever situation in Ivory-Coast and neighbouring countries, 2008-2013. Acta Tropica , 166, 241-248.
- KOVALENKO, Y. R. &SIDOROV, M. A., 1973. Reservoirs and mode of circulation of African swine fever virus in nature. Sel ’skokhozyaistvennaya Biologiya , 8, 598-606.
- KUKIELKA, E. A., JORI, F., MART ÍNEZ-L ÓPEZ, B., CHENAIS, E., MASEMBE, C., CHAVERNAC, D. &ST ÅHL, K., 2016. Wild and domestic pig interactions at the wildlife-livestock interface of Murchison Falls National Park, Uganda, and the potential association with African swine fever outbreaks. Frontiers in Veterinary Science , 3, 31.
- KUKIELKA, E. A., MART ÍNEZ-L ÓPEZ, B. &BELTR ÁN-ALCRUDO, D., 2017. Modelling the live-pig trade network in Georgia: implications for disease prevention and control. PLoS One ,12(6), e0178904.
- KYYR Ö, J., SAHLSTR ÖM, L. &LYTTIK ÄINEN, T., 2017. Assessment of the risk of African swine fever introduction into Finland using NORA –a rapid tool for quantitative assessment of risk. Transboundary and Emerging Diseases , 64(6), 2113-2115.
- LACASTA, A., BALLESTER, M., MONTEAGUDO, P. L., RODR ÍGUEZ, J. M., SALAS, M. L., ACCENSI, F., PINA-PEDRERO, S., BENSAID, A., ARGILAGUET, J., L ÓPEZ-SORIA, S., HUTET, E., LE POTIER, M. F. &RODR ÍGUEZ, F., 2014. Expression library immunization can confer protection against lethal challenge with African swine fever virus. Journal of Virology , 88(22), 13322-13332.
- LADDOMADA, A., PATTA, C., OGGIANO, A., CACCIA, A., RUIU, A., COSSU, P. &FIRINU, A., 1994. Epidemiology of classical swine fever in Sardinia: A serological survey of wild boar and comparison with African swine fever. Veterinary Record , 134, 183-187.
- LANGE, M., SIEMEN, H., BLOME, S. &THULKE, H. H., 2014. Analysis of spatio-temporal patterns of African swine fever cases in Russian wild boar does not reveal an endemic situation. Preventive Veterinary Medicine , 117(2), 317-325.
- LANGE, M. &THULKE, H. H., 2017. Elucidating transmission parameters of African swine fever through wild boar carcasses by combining spatio-temporal notification data and agent-based modelling. Stochastic Environmental Research and Risk Assessment , 31(2), 379-391.
- LEIT ÃO, A., CARTAXEIRO, C., COELHO, R., CRUZ, B., PARKHOUSE, R. M. E., PORTUGAL, F. C., VIG ÁRIO, J. D. &MARTINS, C. L. V., 2001. The non-haemadsorbing African swine fever isolate ASFV/NH/P68 provides a model for defining the protective anti-virus immune response. Journal of General Virology , 82, 513-523.
- LEKULE, F. P. &KYVSGAARD, N. C., 2003. Improving pig husbandry in tropical resource-poor communities and its potential to reduce risk of porcine cysticercosis. Acta Tropica , 87(1), 111-117.
- LI, L., WANG, Q., GE, S., LIU, Y., LIU, C., LIU, F., HU, Y., LI, J., BAO, J., REN, W., ZHANG, Y., XU, T., SUN, C., LI, L., WANG, S., FAN, X., HUANG, B., WU, X. &WANG, Z., 2018. Infection of African swine fever in wild boar, China, 2018. Transboundary and Emerging Diseases . In Press. e-pub ahead of print; doi: 10.1111/tbed.13114.
- LI, X. &TIAN, K., 2018. African swine fever in China. Veterinary Record , 183(9), 300-301.
- LICHOTI, J. K., DAVIES, J., KITALA, P. M., GITHIGIA, S. M., OKOTH, E., MARU, Y., BUKACHI, S. A. &BISHOP, R. P., 2016. Social network analysis provides insights into African swine fever epidemiology. Preventive Veterinary Medicine , 126, 1-10.
- LINDEN, A., LICOPPE, A., VOLPE, R., PATERNOSTRE, J., LESENFANTS, C., CASSART, D., GARIGLIANY, M., TIGNON, M., VAN DEN BERG, T., DESMECHT, D. &CAY, A. B., 2019. Summer 2018: African swine fever virus hits north-western Europe. Transboundary and Emerging Diseases , 66(1), 54-55.
- LIU, L., ATIM, S., LEBLANC, N., RAUH, R., ESAU, M., CHENAIS, E., MWEBE, R., NELSON, W. M., MASEMBE, C., NANTIMA, N., AYEBAZIBWE, C. &ST ÅHL, K., 2019. Overcoming the challenges of molecular pen-side diagnosis of African swine fever to support outbreak investigations under field conditions. Transboundary and Emerging Diseases , 66, 908-914.
- LIU, L., LUO, Y., ACCENSI, F., GANGES, L., RODR ÍGUEZ, F., SHAN, H., ST ÅHL, K., QIU, H. J. &BEL ÁK, S., 2017. Pre-clinical evaluation of a real-time PCR assay on a portable instrument as a possible field diagnostic tool: experiences from the testing of clinical samples for African and classical swine fever viruses. Transboundary and Emerging Diseases , 64(5), e31-35.
- LOPEZ-OTIN, C., FREIJE, J. M. P., PARRA, F., M ÉNDEZ, E. &VI ÑUELA, E., 1990. Mapping and sequence of the gene coding for protein p72, the major capsid protein of African swine fever virus. Virology , 175, 477-484.
- LUBISI, B. A., BASTOS, A. D. S., DWARKA, R. M. &VOSLOO, W., 2005. Molecular epidemiology of African swine fever in East Africa. Archives of Virology , 150, 2439-2452.
- LUBISI, B. A., BASTOS, A. D. S., DWARKA, R. M. &VOSLOO, W., 2007. Intra-genotypic resolution of African swine fever viruses from an East African domestic pig cycle: a combined p72 -CVR approach. Virus Genes , 35, 729-735.
- LUBISI, B. A., DWARKA, R. M., MEENOWA, D. &JAUMALLY, R., 2009. An investigation into the first outbreak of African swine fever in the Republic of Mauritius. Transboundary and Emerging Diseases , 56, 178-188.
- LUKA, P. D., ACHENBACH, J. E., MWIINE, F. N., LAMIEN, C. E., SHAMAKI, D., UNGER, H. &ERUME, J., 2017. Genetic characterization of circulating African swine fever viruses in Nigeria (2007-2015). Transboundary and Emerging Diseases , 64(5), 1598-1609.
- LUKA, P. D., JAMBOL, A. R. &YAKUBU, B., 2014. Detection of African swine fever virus from formalin fixed and non-fixed tissues by polymerase chain reaction. Veterinary World , 7(10), 811-815.
- LUTHER, N. J., MAJIYAGBE, K. A., SHAMAKI, D., LOMBIN, L. H., ANTIABONG, J. F., BITRUS, Y. &OWOLODUN, O., 2007. Detection of African swine fever virus genomic DNA in a Nigerian red river hog (Potamochoerus porcus ). Veterinary Record , 160, 58-59.
- LUTHER, N. J., UDEAMA, P. G., MAJIYAGBE, K. A., SHAMAKI, D., ANTIABONG, J. F., BITRUS, Y., NWOSUH, C. I. &OWOLODUN, O., 2007. Polymerase chain reaction (PCR) detection of the genome of African swine fever virus (ASFV) from natural infection in a Nigerian baby warthog (Phacochoerus aethiopicus ). Nigerian Veterinary Journal , 28 (2), 63-67.
- LYRA, T. M., P., D. &FREITAS, T. R. P., 2015. Epizootiology, laboratory and virulence analyses during the emergency phase of the African swine fever eradication program in Brazil in 1978: a historic account. Ci ências Agr árias, Londrina , 36(4), 2577-2592.
- MADZIMURE, J., ZANDER, K. K., DZAMA, K. &CHIMONYO, M., 2012. Farmer perceptions of classical swine fever outbreak in communal pig production systems of South Africa. African Journal of Agricultural Research , 7(43), 5819-5826.
- MAGADLA, N. R., VOSLOO, W., HEATH, L. &GUMMOW, B., 2016. The African swine fever control zone in South Africa and its current relevance. Onderstepoort Journal of Veterinary Research , 83(1), a1034.
- MALMQUIST, W. A., 1962. Propagation, modification, and haemadsorption of African swine fever virus in cell cultures. American Journal of Veterinary Research , 23, 241-247.
- MALMQUIST, W. A., 1963. Serologic and immunologic studies with African swine fever virus. American Journal of Veterinary Research , 24, 450-459.
- MALMQUIST, W. A. &HAY, D., 1960. Haemadsorption and cytopathic effect produced by African swine fever virus in swine bone marrow and buffy coat cultures. American Journal of Veterinary Research, 21, 104-108.
- MALOGOLOVKIN, A., BURMAKINA, G., TITOV, I., SEREDA, A., GOGIN, A., BARYSHNIKOVA, E. &KOLBASOV, D., 2015. Comparative analysis of African swine fever genotypes and serogroups. Emerging Infectious Diseases , 21(2), 312-315.
- MALOGOLOVKIN, A., BURMAKINA, G., TULMAN, E. R., DELHON, G., DIEL, D. G., SALNIKOV, N., KUTISH, G. F., KOLBASOV, D. &ROCK, D. L., 2015. African swine fever virus CD2v and C-type lectin gene loci mediate serologic specificity. Journal of General Virology , 26(4), 866-873.
- MANNELLI, A., SOTGIA, S., PATTA, C., OGGIANO, A., CARBONI, A., COSSU, P. &LADDOMADA, A., 1998. Temporal and spatial patterns of African swine fever in Sardinia. Preventive Veterinary Medicine , 35, 297-306.
- MANSO RIBEIRO, J., NUNES PETISCA, J. L., LOPES FRAZ ÃO, F. &SOBRAL, M., 1963. Vaccination contre la peste porcine africaine. Bulletin, Office international des Epizooties , 60, 921-937.
- MANSVELT, P. R., 1963. The incidence and control of African swine fever in the Republic of South Africa. Bulletin de l ’Office International des Épizooties, 60, 889-894.
- MANZANO-ROM ÁN, R., D ÍAZ-MARTIN, V., DE LA FUENTE, J. &P ÉREZ-S ÁNCHEZ, R., 2012. Soft ticks as pathogen vectors: Distribution, surveillance and control. In: SHAH, M. M., (ed.). Parasitology. In Tech, (http://www.intechopen.com/books/parasitology/soft-ticks-as-pathogen-vectors-distribution-surveillance-control- )
- MART ÍNEZ-L ÓPEZ, B., PEREZ, A. M., FELIZIANI, F., ROLESU, S., MUR, L. &S ÁNCHEZ-VIZCA ÍNO, J. M., 2015. Evaluation of the risk factors contributing to the African swine fever occurrence in Sardinia. Frontiers in Microbiology , 6, 314.
- MARTINS, C. L. V. &LEITAO, A. C., 1994. Porcine immune response to African swine fever virus (ASFV) infection. Veterinary Immunology and Immunopathology , 43, 99-106.
- MASEMBE, C., SREENU, V. B., DA SILVA FELIPE, A., WILKIE, G. S., OGWENG, P., MAYEGA, F. J., MUWANIKA, V. B., BIEK, R., PALMARINI, M. &DAVISON, A. J., 2018. Genome sequences of five African swine fever genotype IX isolates from domestic pigs in Uganda. Microbiology Resource Announcements ,7(13), e01018-18.
- MATOS, C., SITOE, C., AF ÓNSO, S., BANZE, J., BAPTISTA, J., DIAS, G., RODRIGUES, F., ATAN ÁSIO, A., NHAMUSSO, A., PENRITH, M. L. &WILLINGHAM, A. L. I., 2011. A pilot study of common health problems in smallholder pigs in Ang ónia and Boane districts, Mozambique. Journal of the South African Veterinary Association , 82(3), 166-169.
- MATSON, B. A., 1960. An outbreak of African swine fever in Nyasaland. Bulletin of Epizootic Diseases in Africa , 8, 305-308.
- MATTHEWS, R. E. F., 1982. Classification and nomenclature of viruses. Intervirology, 17, 1-99.
- MAURER, F. D., GRIESEMER, R. A. &JONES, T. C., 1958. The pathology of African swine fever —a comparison with hog cholera. American Journal of Veterinary Research, 19, 517-539.
- MAZUR-PANASIUK, N., WOZNIAKOWSKI, G. &NIEMCZUK, K., 2019. The first genomic sequences of African swine fever virus isolated in Poland. Scientific Reports , 9(1), 4556.
- MBUTHIA, J. M., REWE, T. O. &KAHI, A. K., 2015. Evaluation of pig production practices, constraints and opportunities for improvement in smallholder production systems in Kenya. Tropical Animal Health and Production , 47, 369-376.
- MCINTYRE, K. M., SETZKORN, C., HEPWORTH, P. J., MORAND, S., MORSE, A. P. &BAYLIS, M., 2017. Systematic assessment of the climate sensitivity of important human and domestic animals pathogens in Europe. Scientific Reports , 7(1), 7134.
- MCVICAR, J. W., 1982. A quantitative ELISA assay for antibodies to African swine fever virus. Twenty-fifth Annual Proceedings of the American Association of Veterinary Laboratory Diagnosticians, 421-432.
- MCVICAR, J. W., 1984. Quantitative aspects of the transmission of African swine fever. American Journal of Veterinary Research, 45, 1535-1541.
- MEBUS, C., ARIAS, M., PINEDA, J. M., TAPIADOR, J., HOUSE, C. &SANCHEZ-VIZCAINO, J. M., 1997. Survival of several porcine viruses in different Spanish dry-cured meat products. Mediterranean aspects of meat quality as related to muscle biochemistry. Food Chemistry, 59, 555-559.
- MEBUS, C. A. &DARDIRI, A. H., 1980. Western hemisphere isolates of African swine fever virus: Asymptomatic carriers and resistance to challenge inoculation. American Journal of Veterinary Research, 41, 1867-1869.
- MEBUS, C. A., HOUSE, C., RUIZ-GONZALVO, F., PINEDA, J. M., TAPIADOR, J., PIRE, J. J., BERGADA, J., YEDLOUTSCHNIG, R. J., SAHU, S., BECERRA, V. &SANCHEZ-VIZCAINO, J. M., 1993. Survival of foot-and-mouth disease, African swine fever, and hog cholera viruses in Spanish serrano cured hams and Iberian cured hams, shoulders and loins. Food Microbiology , 10, 133-143.
- MEKURIAW, Y. &ASMARE, B., 2014. Assessment of pig production and constraints in Mecha District, Amhara Region, Western Ethiopia. Advances in Agriculture , 329254. (http://dx.doi.org/10.1155/2014/329254 ) .
- MELLOR, P. S., KITCHING, R. P. &WILKINSON, P. J., 1987. Mechanical transmission of capripox virus and African swine fever virus by Stomoxys calcitrans. Research in Veterinary Science , 43, 109-112.
- MELLOR, P. S. &WILKINSON, P. J., 1985. Experimental transmission of African swine fever by Ornithodoros savignyi (Audouin). Research in Veterinary Science , 39, 353-356.
- MENDES, A. M., 1961. Considerations sur la diagnostique et la prophylaxie de la peste porcine africaine. Bulletin de l ’Office International des Épizooties, 57, 591-600.
- MENDES, A. M., 1962. The lapinization of the virus of African swine fever. Bulletin de l ’Office International des Épizooties , 58, 699-705.
- MENDES, A. M., 1971. Algumas doen ças dos animais em Angola e Mo çambique e sua import ância na higiene das carnes. Revista Portuguesa das Ciencias Veterinarias, 66, 271-286.
- MENDES, A. M., 1994. A hist ória de peste su ína africana em Angola. Revista Portuguesa das Ciencias Veterinarias , 89, 110-120.
- MENDES, A. M. &DASKALOS, A. M., 1955. Studies on the lapinization of African swine fever virus in Angola. Bulletin of Epizootic Diseases of Africa, 3, 9-14.
- MENDOZA, C., VIDEGAIN, S. P. &ALONSO, F., 1991. Inhibition of natural killer activity in porcine mononuclear cells by African swine fever virus. Research in Veterinary Science, 51, 317-321.
- MICHAUD, V., GIL, P., KWIATEK, O., PROME, S., DIXON, L., ROMERO, L., LE POTIER, M. F., ARIAS, M., COUACY-HYMANN, E., ROGER, F., LIBEAU, G. &ALBINA, E., 2007. Long-term storage at tropical temperature of dried-blood filter papers for detection and genotyping of RNA and DNA viruses by direct PCR. Journal of Virological Methods , 146, 257-265.
- MICHAUD, V., RANDRIAMPARANY, T. &ALBINA, E., 2013. Comprehensive phylogenetic reconstructions of African swine fever virus: proposal for a new classification and dating of the virus. PLoS One , 8(7), e69662.
- MISINZO, G., KASANGA, C. J., MPELUMBE-NGELEJA, C., MASAMBU, J., KITAMBI, A. &VAN DOORSSELAERE, J., 2012. African swine fever virus, Tanzania, 2010-2012. Emerging Infectious Diseases ,18(12), 2081-2083.
- MISINZO, G., KWAVI, D. E., SIKOMBE, C. D., MAKANGE, M., PETER, E., MUHAIRWA, A. P. &MADEGE, M. J., 2014. Molecular characterization of African swine fever virus from domestic pigs in northern Tanzania during an outbreak in 2013. Tropical Animal Health and Production , 45, 1199-1207.
- MISINZO, G., MAGAMBO, J., MASAMBU, J., YONGOLO, M. G., VAN DOORSSELAERE, J. &NAUWYNCK, H. J., 2010. Genetic characterization of African swine fever viruses from a 2008 outbreak in Tanzania. Transboundary and Emerging Diseases, 58, 86-92.
- MISSOHOU, A., NIANG, M., FOURCHER, H. &DIEYE, P. N., 2001. Les syst èmes d'élevage porcin en Basse Casamance (S én égal). Cahiers Agricultures , 10, 405-408.
- MONTEAGUDO, P. L., LACASTA, A., L ÓPEZ, E., BOSCH, L., COLLADO, J., PINA-PEDRERO, S., CORREA-FIZ, F., ACCENSI, F., NAVAS, M. J., VIDAL, E., BUSTOS, M. J., RODRIGUEZ, J. M., GALLEI, A., NIKOLIN, V., SALAS, M. L. &RODRIGUEZ, F., 2017. BA71∆CD2: A new recombinant live attenuated African swine fever virus with cross-protective capabilities. Journal of Virology , 91(21), e1058-17.
- MONTGOMERY, R. E., 1921. On a form of swine fever occurring in British East Africa (Kenya Colony). Journal of Comparative Pathology, 34, 159 –191 &243-262.
- MORGAN, S. B., GRAHAM, S. P., SALGUERO, F. J., S ÁNCHEZ-CORD ÓN, P. J., MOKHTAR, H., REBEL, J. M. J., WEESENDORP, E., BODMAN-SMITH, K. B., STEINBACH, F. &FROSSARD, J. P., 2013. Increased pathogenicity of European porcine reproductive and respiratory syndrome virus is associated with enhanced adaptive immune responses and viral clearance. Veterinary Microbiology , 163, 13-22.
- MOULTON, J. &COGGINS, L., 1968. Comparison of lesions in acute and chronic African swine fever. Cornell Veterinarian, 58, 364-388.
- MOULTON, J. E., PAN, I. C., HESS, W. R., DE BOER, C. J. &TESSLER, J., 1975. Pathologic features of chronic pneumonia in pigs with experimentally induced African swine fever. American Journal of Veterinary Research , 36, 27-32.
- MOURA, J. A., MCMANUS, C., BERNAL, F. E. M. &DE MELO, C. B., 2010. An analysis of the 1978 African swine fever outbreak in Brazil and its eradication. Revue scientifique et technique, Office international des Épizooties , 29(3), 549-563.
- MOURA NUNES, J. F. &NUNES-PETISCA, J. L., 1983. Replication of African swine fever virus in lymph nodes of experimentally-infected swine. In: WILKINSON, P. J., (ed.). African Swine Fever . EUR 8466 EN. Commission of the European Communities.
- MOURA NUNES, J. F., VIGARIO, J. D. &TERRINHA, A. M., 1975. Ultrastructural study of African swine fever virus replication in cultures of swine bone marrow cells. Archives of Virology, 49, 59-66.
- MULUMBA-MFUMU, L. K., ACHENBACH, J. E., MAULDIN, M. R., DIXON, L. K., TSHILENGE, C. G., THIRY, E., MORENO, N., BLANCO, E., SAEGERMAN, C., LAMIEN, C. E. &DIALLO, A., 2017. Genetic assessment of African swine fever isolates involved in outbreaks in the Democratic Republic of Congo between 2005 and 2012 reveals co-circulation of p72 genotypes I, IX and XIV, including 19 variants. Viruses , 9, 31.
- MULUMBA-MFUMU, L. K., SAEGERMAN, C., DIXON, L. K., MADIMBA, K. C., KAZADI, E., MUKALAKATA, N. T., OURA, C. A. L., CHENAIS, E., MASEMBE, C., ST ÅHL, K., THIRY, E. &PENRITH, M. L., 2019. African swine fever: Update on Eastern, Central and Southern Africa. Transboundary and Emerging Diseases . In Press. doi: 10.1111/tbed.13187.
- MUR, L., ATZENI, M., MART ÍNEZ-L ÓPEZ, B., FELIZIANI, F., ROLESU, S. &S ÁNCHEZ-VIZCA ÍNO, J. M., 2016. Thirty-five year presence of African swine fever in Sardinia: history, evolution and risk factors for disease maintenance. Transboundary and Emerging Diseases , 63(2), e165-e177.
- MUR, L., BOADELLA, M., MART ÍNEZ-L ÓPEZ, B., GALLARDO, C., GORTAZAR, C. &S ÁNCHEZ-VIZCA ÍNO, J. M., 2012. Monitoring of African swine fever in the wild boar population of the most recent endemic area of Spain. Transboundary and Emerging Diseases , 59, 526-531.
- MUR, L., GALLARDO, C., SOLER, A., ZIMMERMAN, J., PELAYO, V., NIETO, R., S ÁNCHEZ-VIZCA ÍNO, J. M. &ARIAS, M., 2013. Potential use of oral fluid samples for serological diagnosis of African swine fever. Veterinary Microbiology , 165(1-2), 135-139.
- MUR, L., IGOLKIN, A., VARENTSOVA, A., PERSHIN, A., REMYGA, S., SHEVCHENKO, I., ZHUKOV, I. &S ÁNCHEZ-VIZCA ÍNO, J. M., 2016. Detection of African swine fever antibodies in experimental and field samples from the Russian Federation: implications for control. Transboundary and Emerging Diseases , 63(5), e436-440.
- MUR, L., ISCARO, C., COCCO, M., JURADO, C., ROLESU, S., DE MIA, G. M., FELIZIANI, F., P ÉREA-S ÁNCHEZ, R., OLEAGA, A. &S ÁNCHEZ-VIZCA ÍNO, J. M., 2017. Serological surveys and direct field searching reaffirm the absence of Ornithodoros erraticus ticks role in African swine fever cycle in Sardinia. Transboundary and Emerging Diseases , 64(4), 1322-1328.
- MUR, L., MART ÍNEZ-L ÓPEZ, B., COSTARD, S., DE LA TORRE, A., JONES, B. A., MART ÍNEZ, M., S ÁNCHEZ-VIZCA ÍNO, F., MU ÑOZ, M. J., PFEIFFER, D. U. &S ÁNCHEZ-VIZCA ÍNO, J. M., 2014. Modular framework to assess the risk of African swine fever virus entry into the European Union. BMC Veterinary Research ,10, 145.
- MUR, L., MART ÍNEZ-L ÓPEZ, B. &S ÁNCHEZ-VIZCA ÍNO, J. M., 2012. Risk of African swine fever introduction into the European Union through transport-associated routes: returning trucks and waste from international ships and planes. BMC Veterinary Research , 8, 149.
- MUR, L., S ÁNCHEZ-VIZCA ÍNO, J. M., FERN ÁNDEZ-CARRI ÓN, E., JURADO, C., ROLESU, S., FELIZIANI, F., LADDOMADA, A. &MART ÍNEZ-L ÓPEZ, B., 2018. Understanding African swine fever infection dynamics in Sardinia using a spatially explicit transmission model in domestic pig farms. Transboundary and Emerging Diseases , 65(1), 123-124.
- MUTUA, F. K., DEWEY, C. E., ARIMI, S. M., OGARA, W. O., GITHIGIA, S. M., LEVY, M. &SCHELLING, E., 2011. Indigenous pig management practices in rural villages of Western Kenya. Livestock Research for Rural Development, 23(7). (http://www.lrrd.org/lrrd23/7mutu23144.htm ) .
- MUWANIKA, V. B., NYAKAANA, S., SIEGISMUND, H. R. &ARCTANDER, P., 2003. Phylogeography and population structure of the common warthog (Phacochoerus africanus ) inferred from variation in mitochondrial DNA sequences and microsatellite loci. Heredity, 91361-91372.
- NANA-NUKECHAP, M. F. &GIBBS, E. P. J., 1985. Socio-economic effects of African swine fever in Cameroon. Tropical Animal Health and Production , 17, 183-184.
- NANTIMA, N., OCAIDO, M., DAVIES, J., DIONE, M., OKOTH, E., MUGISHA, A. &BISHOP, R., 2015. Characterization of smallholder pig production systems in four districts along the Uganda-Kenya border. Livestock Research for Rural Development , 27, 166.
- NANTIMA, N., OCAIDO, M., OUMA, E., DAVIES, J., DIONE, M., OKOTH, E., MUGISHA, A. &BISHOP, R., 2015. Risk factors associated with occurrence of African swine fever outbreaks in smallholder pig farms in four districts along the Uganda-Kenya border. Tropical Animal Health and Production , 47(3), 589-595.
- NATH, B. G., PATHAK, P. K., NGACHAN, S. V., TRIPATHI, A. K. &MOHANTY, A. K., 2013. Characterization of smallholder pig production system: productive and reproductive performances of local and crossbred pigs in Sikkim Himalayan region. Tropical Animal Health and Production , 45, 1513-1518.
- NEGRIN, R. E. S., 1983. Development in Cuba of a programme for the eradication of African swine fever in 1980. In: Wilkinson, P. J., (ed.). African Swine Fever , 36-41.EUR 8466 EN. Commission of the European Communities.
- NEILAN, J. G., ZSAK, L., LU, Z., BURRAGE, T. G., KUTISH, G. F. &ROCK, D. L., 2004. Neutralizing antibodies to African swine fever virus proteins p30, p54 and p72 are not sufficient for antibody-mediated protection. Virology , 319, 337-342.
- NEITZ, W. O., 1963. African swine fever. In: Emerging Diseases of Animals . FAO Agricultural Studies No 61. Rome: Food &Agriculture Organization of the United Nations.
- NIETO-PELEGR ÍN, E., ARROYO-RIVERA, B. &S ÁNCHEZ-VIZCA ÍNO, J. M., 2015. First detection of antibodies against African swine fever virus in faeces samples. Transboundary and Emerging Diseases , 62(6), 594-602.
- NIGSCH, A., COSTARD, S., JONES, B. A., PFEIFFER, D. U. &WIELAND, B., 2013. Stochastic spatio-temporal modelling of African swine fever spread in the European Union during the high risk period. Preventive Veterinary Medicine , 108, 262-275. Corrigendum 2013: Preventive Veterinary Medicine 110, 573.
- NIX, R. J., GALLARDO, C., HUTCHINGS, G., BLANCO, E. &DIXON, L. K., 2006. Molecular epidemiology of African swine fever virus studied by analysis of four variable genome regions. Archives of Virology , 151, 2475-2494.
- NURMOJA, I., PETROV, A., BREIDENSTEIN, C., ZANI, L., FORTH, J. H., BEER, M., KRISTIAN, M., VILTROP, A. &BLOME, S., 2017. Biological characterization of African swine fever virus genotype II strains from north-eastern Estonia in European wild boar. Transboundary and Emerging Diseases , 64(6), 2034-2041.
- NURMOJA, I., SCHULZ, K., STAUBACH, C., SAUTER-LOUIS, C., DEPNER, K., CONRATHS, F. J. &VILTROP, A., 2017. Development of African swine fever epidemic among wild boar in Estonia - two different areas in the epidemiological focus. Scientific Reports , 7(1), 12562
- OGANESYAN, A. S., PETROVA, O. N., KORENNOY, F. I., BARDINA, N. S., GOGIN, A. E. &DUDNIKOV, S. A., 2013. African swine fever in the Russian Federation: Spatio-temporal analysis and epidemiological overview. Virus Research , 173(1), 204-211.
- OKOTH, E., GALLARDO, C., MACHARIA, J. M., OMORE, A., PELAYO, V., BULIMO, D. W., ARIAS, M., KITALA, P., BABOON, K., LEKOLOL, I., MIJELE, D. &BISHOP, R. P., 2013. Comparison of African swine fever virus prevalence and risk in two contrasting pig-farming systems in South-west and Central Kenya. Preventive Veterinary Medicine , 110, 198-205.
- OLEAGA, A., ESCUDERO-POBLACI ÓN, A., CAMAFEITA, E. &P ÉREZ-S ÁNCHEZ, R., 2007. A proteonomic approach to the identification of salivary proteins from the argasid ticks Ornithodoros moubata and Ornithodoros erraticus. Insect Biochemistry and Molecular Biology , 110, 198-205.
- OLEAGA-P ÉREZ, A., P ÉREZ-S ÁNCHEZ, R., ASTIGARRAGA, A. &ENCINAS-GRANDES, A., 1994. Detection of pig farms with Ornithodoros erraticus by pig serology. Elimination of non-specific reactions by carbohydrate epitopes of salivary antigens. Veterinary Parasitology , 52, 97-111.
- OLEAGA-P ÉREZ, A., P ÉREZ-S ÁNCHEZ, R. &ENCINAS-GRANDES, A., 1990. Distribution and biology of Ornithodoros erraticus in parts of Spain affected by African swine fever. Veterinary Record , 126(2), 32-37.
- OLESEN, A. S., HANSEN, M. F., RASMUSSEN, T. B., BELSHAM, G. J., B ØDKER, R. &B ØTNER, A., 2018. Survival and localization of African swine fever virus in stable flies (Stomoxys calcitrans ) after feeding on viremic blood using a membrane feeder. Veterinary Microbiology , 222, 25-29.
- OLESEN, A. S., LOHSE, L., BOKLUND, A., HALASA, T., BELSHAM, G. J., RASMUSSEN, T. B. &B ØTNER, A., 2018. Short time window for transmissibility of African swine fever virus from a contaminated environment. Transboundary and Emerging Diseases ,65(4), 1024-1032.
- OLESEN, A. S., LOHSE, L., HANSEN, M. F., BOKLUND, A., HALASA, T., BELSHAM, G. J., RASMUSSEN, T. B., B ØTNER, A. &B ØDKER, R., 2018. Infection of pigs with African swine fever virus via ingestion of stable flies (Stomoxys calcitrans ). Transboundary and Emerging Diseases, 65, 1152-1157.
- OLIVER, W. &BRISBIN, I., 1993. Introduced and feral pigs: Problems, policies and priorities.The Eurasian Wild Pig.In: OLIVER, W. L. B., (ed.). Pigs, Peccaries and Hippos Status Survey and Action Plan , 269-286. IUCN/SSC, Gland, Switzerland.
- OLSEVSKIS, E., GUBERTI, V., SERZANTS, M., WESTERGAARD, J., GALLARDO, C., RODZA, I. &DEPNER, K., 2016. African swine fever virus introduction into the EU in 2014: experience of Latvia. Research in Veterinary Science , 105, 28-30.
- OLUGASA, B. O., SOETAN, K. O., OMOTADE, O. O. &AGBEDE, S. A., 2009. African swine fever biocontainment adoption in Ibadan, Nigeria: problems, needs and opportunities. Sustainable animal husbandry: prevention is better than cure. Proceedings of the 14th International Congress of the International Society for Animal Hygiene (ISAH), Vechta, Germany, 19 –23 July 2009, 2, 947- 950.
- OLUWOLE, O. O., OMITOGUN, G. O., OLADELE-BUKOLA, M. O. &BOLADURO, B. A., 2016. Comparison of African swine fever virus prevalence in Nigerian indigenous pig, its hybrid and backcross in an environment prone to African swine fever. American Journal of Molecular Biology , 6, 53-62.
- ONZERE, C. K., BASTOS, A. D., OKOTH, E. A., LICHOTI, J. K., BOCHERE, E. N., OWIDO, M. G., NDAMBUKI, G., BRONSVOORT, M. &BISHOP, R. P., 2018. Multi-locus sequence typing of African swine fever viruses from endemic regions of Kenya and eastern Uganda (2011-2013) reveals rapid B602L central variable region evolution. Virus Genes , 54(1), 111-123.
- ORDAS, A., SANCHEZ-BOTIJA, C. &DIAZ, S., 1983. African swine fever. The current situation in Spain. In: WILKINSON, P. J., (ed.). African Swine Fever. EUR 8466 EN. Commission of the European Communities.
- OURA, C., 2013. African swine fever: on the move and dangerous. Veterinary Record , 173(10), 243-245.
- OURA, C. A., DENYER, M. S., TAKAMATSU, H. &PARKHOUSE, R. M., 2005. In vivo depletion of CD8+ T lymphocytes abrogates protective immunity to African swine fever virus. Journal of General Virology , 86(9), 2445-2450.
- OURA, C. A. L., EDWARDS, L. &BATTEN, C. A., 2013. Virological diagnosis of African swine fever –comparative study of available tests. Virus Research , 173(1), 150-158.
- OURA, C. A. L., POWELL, P. P., ANDERSON, E. &PARKHOUSE, R. M. E., 1998. The pathogenesis of African swine fever in the resistant bushpig. Journal of General Virology , 79, 1439-1443.
- OURA, C. A. L., POWELL, P. P. &PARKHOUSE, R. M. E., 1998. African swine fever: a disease characterised by apoptosis. Journal of General Virology, 79, 1427-1438.
- OURA, C. A. L., POWELL, P. P. &PARKHOUSE, R. M. E., 1998. Detection of African swine fever virus in infected pig tissues by immunocytochemistry and in situ hybridisation. Journal of Virological Methods , 72, 205-217.
- OVIEDO, J. M., RODRIGUEZ, F., GOMES-PUERTAS, P., BRUN, A., GOMEZ, N., ALONSO, C. &ESCRIBANO, J. M., 1997. High level expression of the major antigenic African swine fever virus proteins p54 and p30 in baculovirus and their potential use as diagnostic reagents. Journal of Virological Methods, 64, 27-35.
- OWOLODUN, O. A., YAKUBU, B., ANTIABONG, J. F., OGEDENGBE, O. E., LUKA, P. D., JOHN AUDU, B., EKONG, P. S. &SHAMAKI, D., 2010. Spatio-temporal dynamics of African swine fever outbreaks in Nigeria, 2002 –2007. Transboundary and Emerging Diseases , 57, 330-339.
- PAEZ, E., GARCIA, F. &GIL-FERNANDEZ, G., 1990. Interferon cures cells lytically and persistently infected with African swine fever in vitro. Archives of Virology , 112, 115-127.
- PAIX ÃO, G., ESTEVES, A. &PAYAN-CARREIRA, R., 2018. Characterization of a non-industrial pig production system: the case of B ísaro breed. Revista Brasileira de Zootecnia , 47, e20170331.
- PALLIOLA, E., IOPPOLO, A. &PESTALOZZA, S., 1968. African swine fever in wild boars. Note II: Possibility of experimental infection through ingestion and contact. Veterinaria Italiana , 19, 371-387.
- PAN, I. C., DE BOER, C. J. &HESS, W. R., 1972. African swine fever: Application of immunoelectro-osmophoresis for the detection of antibody. Canadian Journal of Comparative Medicine and Veterinary Science , 36, 309-316.
- PAN, I. C., DE BOER, C. J. &HEUSCHELE, W. P., 1970. Hypergammaglobulinaemia in swine infected with African swine fever virus. Proceedings of the Society for Experimental Biology and Medicine, 134, 367-371.
- PAN, I. C., HUANG, T. S. &HESS, W. R., 1982. A new method of antibody detection by indirect immunoperoxidase plaque staining for serodiagnosis of African swine fever. Journal of Clinical Microbiology , 16, 650-655.
- PAN, I. C., TRAUTMAN, R., DE BOER, C. J. &HESS, W. R., 1974. African swine fever. Hypergammaglobulinaemia and the iodine agglutination test. American Journal of Veterinary Research, 35, 629-631.
- PASTOR, M. J., ARIAS, M., ALCARAZ, C., DE DIEGO, M. &ESCRIBANO, J. M., 1992. A sensitive dot immunobinding assay for serodiagnosis of African swine fever virus with application in field conditions. Journal of Veterinary Diagnostic Investigation, 4, 254-257.
- PASTOR, M. J., ARIAS, M. &ESCRIBANO, J. M., 1990. Comparison of two antigens for use in an enzyme-linked immunosorbent assay to detect African swine fever antibody. American Journal of Veterinary Research, 51, 1540-1542.
- PASTOR, M. J. &ESCRIBANO, J. M., 1990. Evaluation of sensitivity of different antigen and DNA-hybridization methods in African swine fever virus detection. Journal of Virological Methods, 28, 67-77.
- PEIRCE, M. A., 1974. Distribution and ecology of Ornithodoros moubata porcinus Walton (Acarina) in animal burrows in East Africa. Bulletin of Entomological Research , 64, 605-619.
- PEJSAK, Z., TRUSZCZYŃSKI, M., NIEMCZUK, K., KOZAK, E. &MARKOWSKA-DANIEL, I., 2014. Epidemiology of African swine fever in Poland since the detection of the first case. Polish Journal of Veterinary Science , 17(4), 665-672.
- PENRITH, M. L., 2013. History of ‘swine fever ’in southern Africa. Journal of the South African Veterinary Association , 84(1), 1106.
- PENRITH, M. L., BASTOS, A. D., ETTER, E. M. C. &BELTRAN-ALCRUDO, D., 2019. Epidemiology of African swine fever in Africa today: sylvatic cycle versus economic imperatives. Transboundary and Emerging Diseases , 66(1), 672-686.
- PENRITH, M. L., LOPES PEREIRA, C., LOPES DA SILVA, M. M. R., QUEMBO, C., NHAMUSSO, A. &BANZE, J., 2007. Overview of African swine fever in Mozambique: risk factors and potential for control. Onderstepoort Journal of Veterinary Research , 74, 149-160.
- PENRITH, M. L. &THOMSON, G. R., 2004. Special conditions affecting the control of livestock diseases in sub-Saharan Africa. In: COETZER, J. A. W. &TUSTIN, R. C., (eds). Infectious Diseases of Livestock , 2nd edn. 1, 171-177. Oxford University Press, Cape Town.
- PENRITH, M. L., THOMSON, G. R. &BASTOS, A. D. S., 2004. African swine fever. In: Coetzer, J. A. W. &Tustin, R. C., (eds), Infectious diseases of livestock . 2nd edn. 2, 1087-1119. Oxford University Press, Cape Town.
- PENRITH, M. L., THOMSON, G. R., BASTOS, A. D. S., PHIRI, O. C., LUBISI, B. A., BOTHA, B., ESTERHUYSEN, J., DU PLESSIS, E. C., MACOME, F. &PINTO, F., 2004. An investigation into natural resistance to African swine fever in domestic pigs from an endemic area in southern Africa. Revue scientifique et technique, Office International des Épizooties ,23, 665-677.
- PENRITH, M. L. &VOSLOO, W., 2009. Review of African swine fever: transmission, spread and control. Journal of the South African Veterinary Association , 80, 58 –62.
- PENRITH, M. L., VOSLOO, W., JORI, F. &BASTOS, A. D. S., 2013. African swine fever virus eradication in Africa. Virus Research , 173, 228-246.
- P ÉREZ, J., BAUTISTA, M. J., RODRIGUEZ, F., WILKINSON, P. J., SIERRA, M. A. &MARTIN DE LAS MULAS, J., 1997. Double-labelling immunohistochemical study of megakaryocytes in African swine fever. Veterinary Record , 141, 386-390.
- P ÉREZ, J., FERNANDEZ, A. I., SIERRA, M. A., HERRAEZ, P., FERNANDEZ, J. &MARTIN DE LAS MULAS, J., 1998. Serological and immunohistochemical study of African swine fever virus in wild boar in Spain. Veterinary Record , 143, 136-139.
- P ÉREZ, J., RODRIGUEZ, F., FERNANDEZ, A., MARTIN DE LAS MULAS, J., GOMEZ-VILLAMANDOS, J. C. &SIERRA, M. A., 1994. Detection of African swine fever virus protein VP73 in tissues of experimentally and naturally infected pigs. Journal of Veterinary Diagnostic Investigation, 6, 360 –365
- P ÉREZ-FILGUEIRA, D. M., GONZ ÁLEZ-CAMACHO, F., GALLARDO, C., RESINO-TALAV ÁN, P., BLANCO, E., G ÓMEZ-CASADO, E., ALONSO, C. &ESCRIBANO, J. M., 2006. Optimization and validation of recombinant serological tests for African swine fever diagnosis based on detection of the p30 protein produced in Trichoplusia ni larvae. Journal of Clinical Microbiology , 44(9), 3114-3121.
- P ÉREZ-SANCHEZ, R., ASTIGARRAGA, A., OLEAGA-P ÉREZ, A. &ENCINAS-GRANDES, A., 1994. Relationships between the persistence of African swine fever and the distribution of Ornithodoros erraticus in the province of Salamanca, Spain. Veterinary Record , 135, 207-209.
- PERRY, B. D. &GRACE, D., 2009. The impacts of livestock diseases and their control on growth and development processes that are pro-poor. Philosophical Transactions of the Royal Society B , 364 (1530), 2643-2655.
- PERRY, B. D., MCDERMOTT, J. J. &RANDOLPH, T. F., 2004. The control of infectious diseases of livestock: Making appropriate decisions in different epidemiological and socioeconomic conditions. In : COETZER, J. A. W. &TUSTIN, R. C., (eds.). Infectious Diseases of Livestock, 2nd edn. 1, 178-224. Oxford University Press, Cape Town.
- PETIT, F., BOUCRAUT-BARALON, C., BENAZET, F., PICAVET, D. P. &CHANTAL, J., 1991. Detection of African swine fever virus by a biotinylated DNA probe: assay on cell cultures and field samples. Annales de Recherches V ét érinaires , 22, 201-209.
- PETRINI, S., FELIZIANO, F., CASCIARI, C., GIAMMARIOLI, M., TORRESI, C. &DE MIA, G. M., 2019. Survival of African swine fever virus in various traditional Italian dry-cured meat products. Preventive Veterinary Medicine , 162, 126-130.
- PETROV, A., FORTH, J. H., ZANI, L., BEER, M. &BLOME, S., 2018. No evidence for long-term carrier status of pigs after African swine fever virus infection. Transboundary and Emerging Diseases , 65, 1318-1328.
- PHOLOGANE, S. B., BASTOS, A. D. S. &PENRITH, M. L., 2005. Intra- and inter-genotypic size variation in the central variable region of the 9RL open reading frame of diverse African swine fever viruses. Virus Genes , 31, 357-360.
- PIETSCHMANN, J., GUINAT, C., BEER, M., PRONIN, V., TAUSCHER, K., PETROV, A., G., K. &BLOME, S., 2015. Course and transmission characteristics of oral low-dose infection of domestic pigs and European wild boar with a Caucasian African swine fever virus isolate. Archives of Virology , 160, 1657-1667.
- PIETSCHMANN, J., MUR, L., BLOME, S., BEER, M., P ÉREZ-S ÁNCHEZ, R., OLEAGA, A. &S ÁNCHEZ-VIZCA ÍNO, J. M., 2016. African swine fever virus transmission cycles in Central Europe: Evaluation of wild boar-soft tick contacts through detection of antibodies against Ornithodoros erraticus saliva antigen. BMC Veterinary Research , 12, 1.
- PINI, A., 1977. African swine fever: Some observations and considerations. South African Journal of Science , 73, 133-134.
- PINI, A. &HURTER, L. R., 1975. African swine fever: An epizootiological review with special reference to the South African situation. Journal of the South African Veterinary Medical Association , 46, 227-232.
- PLOWRIGHT, W., 1977. Vector transmission of African swine fever. In: LIESS, B., (chairman). Seminar on hog cholera/classical swine fever and African swine fever. EUR 5904 EN. Commission of the European Communities.
- PLOWRIGHT, W., 1986. African swine fever. A retrospective view. Revue Scientifique et Technique de l ’Office International des Épizooties, 5, 455-468.
- PLOWRIGHT, W. &PARKER, J., 1967. The stability of African swine fever virus with particular reference to heat and pH inactivation. Archiv fu ¨r Gesamte Virusforschung , 21, 383-402.
- PLOWRIGHT, W., PARKER, J. &PIERCE, M. A., 1969. African swine fever in ticks (Ornithodoros moubata ) collected from animal burrows in Tanzania. Nature , 221, 1071-1073.
- PLOWRIGHT, W., PARKER, J. &PIERCE, M. A., 1969. The epizootiology of African swine fever in Africa.Veterinary Record , 85, 668-674.
- PLOWRIGHT, W., PARKER, J. &STAPLE, R. F., 1968. The growth of a virulent strain of African swine fever virus in domestic pigs. Journal of Hygiene, Cambridge, 66, 117-134.
- PLOWRIGHT, W., PERRY, C. T. &GREIG, A., 1974. Sexual transmission of African swine fever virus in the tick, Ornithodoros moubata porcinus Walton. Research in Veterinary Science, 17, 106-113.
- PLOWRIGHT, W., PERRY, C. T. &PIERCE, M. A., 1970. Transovarial infection with African swine fever virus in the argasid tick, Ornithodoros moubata porcinus Walton. Research in Veterinary Science, 11, 582-584.
- PLOWRIGHT, W., PERRY, C. T., PIERCE, M. A. &PARKER, J., 1970. Experimental infection of the argasid tick, Ornithodoros moubata porcinus, with African swine fever virus. Archiv f ür die gesamte Virusforschung, 31, 33-50.
- PLOWRIGHT, W., THOMSON, G. R. &NESER, J. A., 1994. African swine fever. In: COETZER, J. A. W., THOMSON, G. R. &TUSTIN, R. C., (eds.). Infectious Diseases of Livestock, with Special Reference to Southern Africa. 1st edn, 1. Cape Town: Oxford University Press.
- PODG ÓRSKI, T. &SMIETANKA, K., 2018. Do wild boar movements drive the spread of African swine fever? Transboundary and Emerging Diseases , 65(6),1588-1596.
- PORTERFIELD, J. S., 1975. The basis of arbovirus classification. Medical Biology , 53, 400-405.
- PORTUGAL, R., COELHO, J., H ÖPER, D., LITTLE, N. S., SMITHSON, C., UPTON, C., MARTINS, C., LEIT ÃO, A. &KEIL, G. M., 2015. Related strains of African swine fever virus with different virulence: genome comparison and analysis. Journal of General Virology , 96, 408-419.
- PORTUGAL, R., LEIT ÃO, A. &MARTINS, C., 2009. Apoptosis in porcine macrophages infected in vitro with African swine fever virus (ASFV) strains with different virulence. Archives of Virology , 154(9), 1441-1450.
- POST, J., WEESENDORP, E., MONTOYA, M. &LOEFFEN, W., 2017. Influence of age and dose of African swine fever virus infections on clinical outcome and blood parameters in pigs. Viral Immunology , 30(1), 56-69.
- PROBST, C., GLOBIG, A., KNOLL, B., CONRATHS, F. J. &DEPNER, K., 2017. Behaviour of free ranging wild boar towards their dead fellows: Potential implications for the transmission of African swine fever. Royal Society Open Science , 4(5), 170054.
- PUJOLS ROMEU, J., BADIOLA SAIZ, J. I., P ÉREZ DE ROZAS, J. M., ROSELL BELLSOL Á, R. &CARRERAS MAURI, J., 1991a. Papel que tienen los cerdos portadores en el mantenimiento y transmission del virus de la PPA. I. Estudo epizootiol ógio. Medicina Veterin ária , 8(9), 481-489.
- PUJOLS ROMEU, J., BADIOLA SAIZ, J. I., P ÉREZ DE ROZAS, J. M., SEGURA CARDONA, L. I. &SACO GALVANY, M., 1991b. Papel que tienen los cerdos portadores en el mantenimiento y transmission del virus de la PPA. II. Aislamento del virus de animales seropositivos. Medicina Veterin ária , 8(9), 560-566.
- QUEMBO, C. J., JORI, F., HEATH, L., P ÉREZ-S ÁNCHEZ, R. &VOSLOO, W., 2016. Investigation into the epidemiology of African swine fever virus at the wildlife-domestic interface of the Gorongosa National Park, central Mozambique. Transboundary and Emerging Diseases , 63(4), 443-451.
- QUEMBO, C. J., JORI, F., VOSLOO, W. &HEATH, L., 2018. Genetic characterisation of African swine fever isolates from soft ticks at the wildlife/domestic interface in Mozambique and identification of a novel genotype. Transboundary and Emerging Diseases , 65, 420-431.
- QUINTAS, A., P ÉREZ-NU ÑEZ, D., S ÁNCHEZ, E. G., NOGAL, M. L., HENTZE, M. W., CASTELL Ó, A. &REVILLA, Y., 2017. Characterization of the African swine fever virus decapping enzyme during infection. Journal of Virology , 91(24), e00990-17.
- RAHIMI, P., SOHRABI, A., ASHRAFIHELAN, J., EDALAT, R., ALAMDARI, M., MASOUDI, M., MOSTOFI, S. &AZADMANESH, K., 2010. Emergence of African swine fever virus, Northwestern Iran. Emerging Infectious Diseases , 16(12), 1946-1948.
- RAMIRO-IBA ÑEZ, F., ORTEGA, A., BRUN, A., ESCRIBANO, J. M. &ALONSO, C., 1996. Apoptosis: A mechanism of cell killing and lymphoid organ impairment during acute African swine fever virus infection. Journal of General Virology, 77, 2209-2219.
- RAMIRO-IBA ÑEZ, F., ORTEGA, A., RUIZ-GONZALVO, F., ESCRIBANO, J. M. &ALONSO, C., 1997. Modulation of immune cell populations and activation markers in the pathogenesis of African swine fever virus infection. Virus Research , 47(1), 31-40.
- RAVAIOLI, F., PALLIOLA, E. &IOPPOLA, A., 1967. ASF in wild boars: Possibility of experimental infection through inoculation. Veterinaria Italiana , 18, 508-513.
- RAVAOMANANA, J., JORI, F., VIAL, L., P ÉREZ-S ÁNCHEZ, R., BLANCO, E., MICHAUD, V. &ROGER, F., 2011. Assessment of interactions between African swine fever virus, bushpigs (Potamochoerus larvatus ), Ornithodoros ticks and domestic pigs in north-western Madagascar. Transboundary and Emerging Diseases , 58, 247-254.
- RAVAOMANANA, J., MICHAUD, V., JORI, F., ANDRIATSIMAHAVANDY, A., ROGER, F., ALBINA, E. &VIAL, L., 2010. First detection of African swine fever virus in Ornithodoros porcinus ticks in Madagascar and new insights into tick distribution and taxonomy. Parasites and Vectors , 3, 115.
- RELUN, A., GROSBOIS, V., ALEXANDROV, T., S ÁNCHEZ-VIZCA ÍNO, J. M., WARET-SZKUTA, A., MOLIA, S., ETTER, E. M. C. &MART ÍNEZ-L ÓPEZ, B., 2017. Prediction of pig trade movements in different European production systems using exponential random graph models. Frontiers in Veterinary Science , 4, 27.
- RELUN, A., GROSBOIS, V., S ÁNCHEZ-VIZCA ÍNO, J. M., ALEXANDROV, T., FELIZIANI, F., WARET-SZKUTA, A., MOLIA, S., ETTER, E. M. C. &MART ÍNEZ-L ÓPEZ, B., 2016. Spatial and functional organization of pig trade in different European production systems: implications for disease prevention and control. Frontiers in Veterinary Science , 3, 4.
- REVILLA, Y., CEBRIAN, A., BAIXERAS, E., MARTINEZ, A., VI ÑUELA, E. &SALAS, M. L., 1997. Inhibition of apoptosis by the African swine fever virus Bcl-2 homologue: role of the BH 1 domain. Virology, 228, 400-404.
- REVILLA, Y., PE ÑA, L. &VI ÑUELA, E., 1992. Interferon-gamma production by African swine fever virus-specific lymphocytes. Scandinavian Journal of Immunology, 35, 225-230.
- RIVERA, E. M., 1983. African swine fever in the Dominican Republic. In: WILKINSON, P. J., (ed.). African Swine Fever. EUR 8466 EN. Commission of the European Communities.
- ROBERTS, P. C., LU, Z. &ROCK, D. L., 2001. Nucleotide sequence and analysis of 16.25 kilobase pairs of the African swine fever virus genome that span the central variable region. Genbank sequence submission L00966 .
- ROCK, D. L., 2017. Challenges for African swine fever vaccine development –“…perhaps the end of the beginning ”. Veterinary Microbiology , 206, 52-58.
- RODRIGUES, L. C. D. M., ANDRADE, C., DA SILVA, A. G. &BAPTISTA, M. D. F. D., 1983. Ultramicroscopic observations of African swine fever virus in pig erythrocytes. In: WILKINSON, P.J., (ed.). African Swine Fever. EUR 8466 EN. Commission of the European Communities.
- RODRIGUEZ, F., ALCARAZ, C., EIRAS, A., YA ÑEZ, R. J., RODRIGUEZ, J. M., ALONSO, C., RODRIGUEZ, J. F., VI ÑUELA, E. &ESCRIBANO, J. M., 1994. Characterisation and molecular basis of heterogeneity of the African swine fever virus envelope protein p54. Journal of Virology , 68, 7244-7252.
- RODRIGUEZ, F., FERNANDEZ, A., P ÉREZ, J., MARTIN DE LAS MULAS, J., SIERRA, M. A. &JOVER, A., 1996. African swine fever: Morphopathology of a viral haemorrhagic disease. Veterinary Record , 139, 249-254.
- RODRIGUEZ, J. M., YANEZ, R. J., ALMAZAN, F., VI ÑUELA, E. &RODRIGUEZ, J. F., 1993. African swine fever virus encodes a CD2 homolog responsible for the adhesion of erythrocytes to infected cells. Journal of Virology , 67, 5312 –5320.
- ROEDER, P., 2011. Making a global impact: Challenges for the future. Veterinary Record , 169(26), 671-674.
- ROELANDT, S., VAN DER STEDE, Y., D ’HONDT, B. &KOENEN, F., 2017. The assessment of African swine fever virus risk to Belgium early 2014, using the quick and semiquantitative Pandora screening protocol. Transboundary and Emerging Diseases , 64, 237-249.
- ROGER, F., RATOVONJATO, J., VOLA, P. &UILENBERG, G., 2001. Ornithodoros porcinus ticks, bushpigs and African swine fever in Madagascar. Experimental and Applied Acarology, 25, 263-269.
- ROJO, G., CHAMORRO, M., SALAS, M. L., VI ÑUELA, E., CUEZVA, J. M. &SALAS, J., 1998. Migration of mitochondria to viral assembly sites in African swine fever virus-infected cells. Journal of Virology , 72, 7583-7588.
- ROJO, G., GARCIA-BEATO, R., VI ÑUELA, E., SALAS, M. L. &SALAS, J., 1999. Replication of African swine fever virus DNA in infected cells. Virology, 257, 524-536.
- ROUILLER, I., BROOKES, S. M., HYATT, A. D., WINDSOR, M. &WILEMAN, T., 1998. African swine fever is wrapped by the endoplasmic reticulum. Journal of Virology, 72, 2373-2387.
- ROUSSET, D., RANDRIAMPARANY, T., MAHARAVO RAHANTAMALALA, C. Y., RANDRIAMAHEFA, N., ZELLER, H., RAKOTO-ANDRIANARIVELO, M. &ROGER, F., 2001. Introduction de la peste porcine africaine àMadagascar, histoire et le çons d ’une émergence. Archives de l ’Instiut Pasteur de Madagascar , 67(1-2), 31-33.
- ROWLANDS, R. J., MICHAUD, V., HEATH, L., HUTCHINGS, G., OURA, C., VOSLOO, W., DWARKA, R., ONASHVILI, T., ALBINA, E. &DIXON, L. K., 2008. African swine fever isolate, Georgia, 2007. Emerging Infectious Diseases , 14, 1870-1874.
- SAKA, J. O., ADEHESINWA, A. O. K. &AJALA, M. K., 2010. Incidence of African swine fever (ASF) disease and its associated implications on pig production in Lagos state, Nigeria. Bulgarian Journal of Agricultural Science , 18(1), 80-90.
- SALGUERO, F. J., RUIZ-VILLAMOR, E., BAUTISTA, M. J., S ÁNCHEZ-CORD ÓN, P. J., CARRASCO, L. &G ÓMEZ-VILLAMANDOS, J. C., 2002. Changes in macrophages in spleen and lymph nodes during acute African swine fever: expression of cytokines. Veterinary Immunology and Immunopathology , 90(1-2), 11-22.
- SALGUERO, F. J., S ÁNCHEZ-CORD ÓN, P. J., NU ÑEZ, A., FERN ÁNDEZ DE MARCO, M. &G ÓMEZ-VILLAMANDOS, J. C., 2005. Proinflammatory cytokines induce lymphocyte apoptosis in acute African swine fever infection. Journal of Comparative Pathology , 132(4), 289-302.
- SALGUERO, F. J., S ÁNCHEZ-CORD ÓN, P. J., SIERRA, M. A., JOVER, A., NU ÑEZ, A. &G ÓMEZ-VILLAMANDOS, J. C., 2004. Apoptosis of thymocytes in experimental African swine fever virus infection. Histology and Histopathology , 19(1), 77-84.
- SALIKI, J. T., THIRY, E. &PASTORET, P. P., 1985. La peste porcine africaine (African swine fever). Études et Synth èses de l ’Institut d ’Élevage et de M édecine V ét érinaire des Pays Tropicaux , 11, Paris.
- S ÁNCHEZ, E. G., QUINTAS, A., NOGAL, M. L., CASTELL Ó, A. &REVILLA, Y., 2013. African swine fever virus controls the host transcription and cellular machinery of protein synthesis. Virus Research , 173(1), 58-75.
- SANCHEZ-BOTIJA, A. C., 1963. Reservorios del virus de la peste porcina africana. Investigaci ón del virus de la P.P.A. en los artr ópodos mediante la prueba de la hemoadsorci ón. Bulletin de la Office International des Épizooties , 60, 895-899.
- SANCHEZ-BOTIJA, C., 1982. African swine fever. New developments. Revue Scientifique et Technique de l ’Office International des Epizooties , 1, 1065-1094.
- SANCHEZ-BOTIJA, C. &BADIOLA, A. C., 1966. Presencia del virus de la peste porcine Africana en el Haematopinus suis. Bulletin de l ’Office International des Épizooties , 66, 699-705.
- SANCHEZ-BOTIJA, C., ORDAS, A. &GONZALES, J. G., 1970. La immunofluorescencia indirecta applicada a la investigacion de anticuerpos de la peste porcina Africana. Su valor para el diagnostico.Bulletin de l ’Office International des Épizooties , 74, 397-417.
- S ÁNCHEZ-CORD ÓN, P. J., CER ÓN, J. J., NU ÑEZ, A., MART ÍNEZ-SUBIELA, S., PEDRERA, M., ROMERO-TREVEJO, J. L., GARRIDO, M. R. &G ÓMEZ-VILLAMANDOS, J. C., 2007. Serum concentrations of C-reactive protein, serum amyloid A, and haptoglobin in pigs inoculated with African swine fever or classical swine fever viruses. American Journal of Veterinary Research , 68(7), 772-777.
- S ÁNCHEZ-CORD ÓN, P. J., ROMERO-TREVEJO, J. L., PEDRERA, M., S ÁNCHEZ-VIZCA ÍNO, J. M., BAUTISTA, M. J. &G ÓMEZ-VILLAMANDOS, J. C., 2008. Role of hepatic macrophages during the haemorrhagic fever induced by African swine fever virus. Histology and Histopathology , 23(6), 683-691.
- SANCHEZ-VIZCAINO, J. M., CROWTHER, J. R. &WARDLEY, R. C., 1983. A collaborative study on the use of the ELISA in the diagnosis of African swine fever. In: WILKINSON, P. J., (ed.). African Swine Fever . EUR 8466 EN. Commission of the European Communities.
- S ÁNCHEZ-VIZCA ÍNO, J. M., MUR, L. &MART ÍNEZ-L ÓPEZ, B., 2012. African swine fever: an epidemiological update. Transboundary and Emerging Diseases , 59(1), 27-35.
- S ÁNCHEZ-VIZCA ÍNO, J. M., MUR, L. &MART ÍNEZ-L ÓPEZ, B., 2013. African swine fever (ASF): Five years around Europe. Veterinary Microbiology , 165, 45-50.
- S ÁNCHEZ-VIZCA ÍNO, J. M., MUR, L., GOMEZ-VILLAMANDOS, J. C. &CARRASCO, L., 2015. An update on the epidemiology and pathology of African swine fever. Journal of Comparative Pathology , 152(1), 9-21.
- SANCHEZ-VIZCAINO, J. M., SLAUSON, D. O., RUIZ-GONZALVO, F. &VALERO, M. S., 1981. Lymphocyte function and cell-mediated immunity in pigs with experimentally induced African swine fever. American Journal of Veterinary Research , 42, 1335-1341.
- SARGSYAN, M. A., VOSKANYAN, H. E., KARALOVA, E. M., HAKOBYAN, L. H. &KARALYAN, Z. A., 2018. Third wave of African swine fever in Armenia: Virus demonstrates the reduction of pathogenicity. Veterinary World , 11(1), 5-9.
- SARR, J., 1990. Etude de la peste porcine Africaine au S én égal. Rapport final. Programme de recherche financ épar le Commision des Communaut és Europ éennes, Direction G én érale de la Science, de la Recherche et de la D éveloppement. Unpublished report, Laboratoire de l ’Elevage et de Recherches V éterinaires, Dakar-Hann, S én égal. .
- SASTRE, P., GALLARDO, C., MONEDERO, A., RUIZ, T., ARIAS, M., SANZ, A. &RUEDA, P., 2016. Development of a novel lateral flow assay for detection of African swine fever in blood. BMC Veterinary Research , 12, 206.
- SASTRE, P., P ÉREZ, T., COSTA, S., YANG, X., R ÄBER, A., BLOME, S., GOLLER, K. V., GALLARDO, C., TAPIA, I., GARC ÍA, J., SANZ, A. &RUEDA, P., 2016. Development of a duplex lateral flow assay for simultaneous detection of antibodies against African and classical swine fever viruses. Journal of Veterinary Diagnostic Investigation , 28(5), 543-549.
- SCHLAFER, D. H. &MEBUS, C. A., 1984. Abortion in sows experimentally infected with African swine fever virus. Clinical features. American Journal of Veterinary Research , 45, 1353-1360.
- SCHLOER, G. M., 1985. Polypeptides and structure of African swine fever virus. Virus Research, 3, 295-310.
- SCHOLL, T., LUNNEY, J. K., MEBUS, C. A., DUFFY, E. &MARTINS, C. L. V., 1989. Virus-specific cellular blastogenesis and interleukin-2 production in swine after recovery from African swine fever. American Journal of Veterinary Research , 50, 1781-1786.
- SCOTT, G. R., 1965. Prevention, control and eradication of African swine fever. Bulletin de l ’Office International des Epizooties , 63, 751-764
- SIAMUPA, C., SAASA, N. &PHIRI, A. M., 2018. Contribution of market value chain to the control of African swine fever in Zambia. Tropical Animal Health and Production , 50(1), 177-185.
- SIM ÓN-MATEU, C. G., ANDR ÉS, G., ALMAZ ÁN, F. &VI ÑUELA, E., 1997. Proteolytic processing in African swine fever virus: Evidence for a new structural polyprotein, pp62. Journal of Virology , 71, 5799-5804.
- SIM ÓN-MATEU, C. G., ANDR ÉS, G. &VI ÑUELA, E., 1993. Polyprotein processing in African swine fever virus: A novel strategy of gene expression for a DNA virus. EMBO Journal , 12, 2977-2987.
- SIMON-MATEU, C. G., FREIJE, J. M. P., ANDR ÉS, G., LOPEZ-OTIN, C. &VI ÑUELA, E., 1995. Mapping and sequence of the gene encoding protein p17, a major African swine fever virus structural protein. Virology, 206, 1140-1144.
- SIMULUNDU, E., CHAMBARO, H. M., SINKALA, Y., KAJIHARA, M., OGAWA, H., MORI, A., NDEBE, J., DAUTU, G., MATAA, L., LUBABA, C. H., SIMUNTALA, C., FANDAMU, P., SIMUUNZA, M., PANDEY, G. S., SAMUI, K. L., MISINZO, G., TAKADA, A. &MWEENE, A. S., 2018. Co-circulation of multiple genotypes of African swine fever viruses among domestic pigs in Zambia (2013-2015). Transboundary and Emerging Diseases , 65(1), 114-122.
- SIMULUNDU, E., LUBABA, C. H., VAN HEERDEN, J., KAJIHARA, M., MATAA, L., CHAMBARO, H. M., SINKALA, Y., MUNJITA, S. M., MUNANG'ANDU, H. M., NALUBAMBA, K. S., SAMUI, K., PANDEY, G. S., TAKADA, A. &MWEENE, A. S., 2017. The epidemiology of African swine fever in "non-endemic" regions of Zambia (1989-2015): Implications for disease prevention and control. Viruses ,9, 236.
- SIMULUNDU, E., SINKALA, Y., CHAMBARO, H. M., CHINYEMBA, A., BANDA, F., MOOYA, L. E., NDEBE, J., CHITANGA, S., MAKUNGU, C., MUNTHALI, G., FANDAMU, P., TAKADA, A. &MWEENE, A. S., 2018. Genetic characterisation of African swine fever virus from 2017 outbreaks in Zambia: identification of p72 genotype II variants in domestic pigs. Onderstepoort Journal of Veterinary Research , 85, a1562.
- SMIETANKA, K., W ÓZNIAKOWSKI, G., KOZAK, E., NIEMCZUK, K., FRACZYK, M., BOCIAN, L., KOWALCZYK, A. &PEJSAK, Z., 2016. African swine fever epidemic, Poland, 2014-2015. Emerging Infectious Diseases , 22(7), 1201-1207.
- SOGO, J. M., ALMENDRAL, J. M., TALAVERA, A. &VI ÑUELA, E., 1984. Terminal and internal inverted repetitions in African swine fever virus DNA. Virology , 133, 271-275.
- SOUTO, R., MUTOWEMBWA, P., VAN HEERDEN, J., FOSGATE, G. T., HEATH, L. &VOSLOO, W., 2016. Vaccine potential of two previously uncharacterized African swine fever isolates from southern Africa and heterologous protection from an avirulent European isolate. Transboundary and Emerging Diseases , 63(2), 224-231.
- ST ÅHL, K., OGWENG, P., OKOTH, E., ALIRO, T., MUHANGI, D., LEBLANC, N., ATIMNEDI, P., BERG, M., BISHOP, R. P., RASMUSSEN, H. B. &MASEMBE, C., 2014. Understanding the dynamics and spread of African swine fever virus at the wildlife-livestock interface: Insights into the potential role of the bushpig, Potamochoerus larvatus . Suiform Soundings , 13(1), 24-28.
- STEIGER, Y., ACKERMANN, M., METTRAUX, C. &KIM, U., 1992. Rapid and biologically safe diagnosis of African swine fever virus infection by using polymerase chain reaction. Journal of Clinical Microbiology, 30, 1-8.
- STEYN, D. G., 1928. Preliminary report on a South African virus disease amongst pigs. 13th and 14th Reports of the Director of Veterinary Education and Research, Union of South Africa , 415-428.
- STEYN, D. G., 1932. East African virus disease in pigs. 18th Report of the Director of Veterinary Services and Animal Industry, Union of South Africa , 1, 99-109.
- STONE, S. S. &HESS, W. R., 1967. Antibody response to inactivated preparations of African swine fever virus in pigs. American Journal of Veterinary Research, 28, 475-481.
- STONE, S. S. &HESS, W. R., 1973. Effects of some disinfectants on African swine fever virus. Applied Microbiology , 25, 115-122.
- SU ÁREZ, C., ANDR ÉS, G., KOLOVOU, A., HOPPE, S., SALAS, M. L., WALTHER, P. &LOCKER, J. K., 2015. African swine fever virus assembles a single membrane derived from rupture of the endoplasmic reticulum. Cellular Microbiology , 17(11), 1683-1698.
- SUMPTION, K. J., HUTCHINGS, G. H., WILKINSON, P. J. &DIXON, L. K., 1990. Variable regions on the genome of Malawi isolates of African swine fever virus. Journal of General Virology , 71, 2331-2340.
- SWAI, E. S. &LYIMO, C. J., 2014. Impact of African swine fever epidemics in smallholder pig production units in Rombo district of Kilimanjaro, Tanzania. Livestock Research for Rural Development , 26 (2), 32.
- TABAR ÉS, E., 1987. Characterisation of ASFV proteins. In: BECKER, Y., (ed.). African Swine Fever . Boston: Martinus Nijhoff.
- TABAR ÉS, E., FERNANDEZ, M., SALVADOR TEMPRANO, E., CARNERO, M. E. &SANCHEZ-BOTIJA, A., 1981. A reliable enzyme-linked immunosorbent assay for African swine fever using the major structural protein as antigenic reagent. Archives of Virology , 70, 207-300.
- TEKLE, T., TESFAY, A. &KIFLEYOHANNES, T., 2013. Smallholder pig production and its constraints in Mekelle and southern zone of Tigray Region, north Ethiopia. Livestock Research for Rural Development , 25, 10
- THOMAS, L. F., BISHOP, R. P., ONZERE, C., MCINTOSH, M. T., LEMIRE, K. A., DE GLANVILLE, W. A., COOK, E. A. J. &F ÈVRE, E. M., 2016. Evidence for the presence of African swine fever virus in an endemic region of Western Kenya in the absence of any reported outbreak. BMC Veterinary Research , 12, 192.
- THOMSON, G. R., 1985. The epidemiology of African swine fever: The role of free-living hosts in Africa. Onderstepoort Journal of Veterinary Research , 52, 201-209.
- THOMSON, G. R., GAINARU, M., LEWIS, A., BIGGS, H., NEVILL, E., VAN DER PYPEKAMP, H., GERBER, L., ESTERHUYSEN, J., BENGIS, R., BEZUIDENHOUT, D. &CONDY, J., 1983. The relationship between African swine fever virus, the warthog and Ornithodoros species in southern Africa. In: WILKINSON, P. J., (ed.). African Swine Fever. EUR 8466 EN. Commission of the European Communities.
- THOMSON, G. R., GAINARU, M. D. &VAN DELLEN, A. F., 1979. African swine fever. Pathogenicity and immunogenicity of two non-haemadsorbing viruses. Onderstepoort Journal of Veterinary Research, 46, 149-154.
- THOMSON, G. R., GAINARU, M. D. &VAN DELLEN, A. F., 1980. Experimental infection of warthog (Phacochoerus aethiopicus ) with African swine fever virus. Onderstepoort Journal of Veterinary Research , 47, 19-22.
- THOROMO, J., SIMULUNDU, E., CHAMBARO, H. M., MATAA, L., LUBABA, C. H., PANDEY, G. S., TAKADA, A., MISINZO, G. &MWEENE, A. S., 2016. Diagnosis and genotyping of African swine fever viruses isolated from 2015 outbreaks in Zambia. Onderstepoort Journal of Veterinary Research , 83, a1095.
- TRAPE, J. F., DIATTA, G., ARNATHAU, C., BITAM, I., SARIH, M., BELGHYTI, D., BOUATTOUR, A., ELGUERO, E., VIAL, L., MAN É, Y., BALD É, C., PUGNOLLE, F., CHAUVANCY, G., MAH É, G., GRANJON, L., DUPLANTIER, J. M., DURAND, P. &RENAUD, F., 2013. The epidemiology and geographic distribution of relapsing fever borreliosis in West and North Africa, with a review of the Ornithodoros erraticus complex (Acari: Ixodida). PLoS One , 8(11), e78473.
- TURNBULL, D. O., 1932. Nyasaland. Annual Report of the Veterinary Department, 1931. Swine fever .
- TURNBULL, D. O., 1933. Nyasaland. Annual Report of the Veterinary Department, 1932. Swine fever .
- TURNBULL, D. O., 1934. Nyasaland. Annual Report of the Veterinary Department, 1933. Swine fever .
- UILENBERG, G., ESTRADA-PE ÑA, A. &THAL, J., 2013. Ticks of the Central African Republic. Experimental and Applied Acarology , 50, 1-40.
- USDA., 2015. The Foreign Animal Disease Preparedness and Response Plan (FAD PReP). (https://www.aphis.usda.gov/animal_health/emergency_management/downloads/documents_manuals/fadprep_manual_2.pdf ).
- UTTENTHAL, Ǻ., BRAAE, U. C., NGOWI, H., RASMUSSEN, T. B., NIELSEN, J. &JOHANSEN, M. V., 2013. ASFV in Tanzania: Asymptomatic pigs harbor virus of molecular similarity to Georgia 2007. Veterinary Microbiology , 165 (1-2), 173-176.
- UTTENTHALER, E., KOSSLINGER, C. &DROST, S., 1998. Quartz crystal biosensor for detection of the African swine fever disease. Analytica Chimica Acta , 352, 91-100.
- VALDEIRA, M. L. &GERALDES, A., 1985. Morphological study on the entry of African swine fever virus into cells. Biology of the Cell , 55, 35-40.
- VALL ÉE, I., TAIT, S. W. G. &POWELL, P. P., 2001. African swine fever virus infection of porcine aortic endothelial cells leads to inhibition of inflammatory responses, activation of the thrombotic state, and apoptosis. Journal of Virology , 75(21), 10372-10382.
- VAN HEERDEN, J., MALAN, K., GADAGA, B. M. &SPARGO, R. E., 2017. Reemergence of African swine fever in Zimbabwe, 2015. Emerging Infectious Diseases , 23(5), 860-861.
- VASCO, S. G., 1991. Resist ência especifica ao virus da Peste Suina African (PSA). Analise de algumas experiencias que apontam nesse sentido. Revista Portuguesa de Ciencias Veterinarias , 86, 76-82, 85-88.
- VELHO, E. L., 1956. Observations sur la peste porcine en Angola. Bulletin de l ’Office International des Épizooties , 46, 335-340.
- VEPKHVADZE, N. G., MENTESHASHVILI, I., KOKHREIDZE, M., GOGINASHVILI, K., TIGILAURI, T., MAMISASHVILI, E., GELASHVILI, L., ABRAMISHVILI, T., DONDUASHVILI, M., GHVINJILIA, G., AVALIANI, L., PARKADZE, O., NINIDZE, L., KARTSKHIA, N., NAPETVARIDZE, T., RUKHADZE, Z., ASANISHVILI, Z., WELLER, R. &RISATTI, G. R., 2017. Active surveillance of African swine fever in domestic swine herds in Georgia, 2017. Revue scientifique et technique, Office international des Épizooties , 36(3), 879-887.
- VERGNE, T., CHEN-FU, C., LI, S., CAPELLE, J., EDWARDS, J., MARTIN, V., PFEIFFER, D. U., FUSHENG, D. &ROGER, F. L., 2017a. Pig empire under infectious threat: risk of African swine fever introduction into the People's Republic of China. Veterinary Record, 181(5), 117. doi: 10.1136/vr.103950
- VERGNE, T., GOGIN, A. &PFEIFFER, D. U., 2017. Statistical exploration of local transmission routes for African swine fever in pigs in the Russian Federation, 2007-2014. Transboundary and Emerging Diseases , 64(2), 504-512.
- VERGNE, T., GUINAT, C., PETKOVA, P., GOGIN, A., KOLBASOV, D., BLOME, S., MOLIA, S., PINTO FERREIRA, J., WIELAND, B., NATHUES, H. &PFEIFFER, D. U., 2016. Attitudes and beliefs of pig farmers and wild boar hunters towards reporting of African swine fever in Bulgaria, Germany and the western part of the Russian Federation. Transboundary and Emerging Diseases , 63(2), e194-e204.
- VERHULST, A., 1993. Lessons from field experiences in the development of monogastric animal production. In: MACK, S., (ed.), Strategies for sustainable animal agriculture in developing countries. Proceedings of the FAO Expert Consultation held in Rome, Italy, 10 –14 December 1990. FAO Animal Health and Production Paper , 107, 261 –271. (http://www.fao.org/DOCREP/004/T0582E/T0582E27.htm ) .
- VIAL, L., WIELAND, B., JORI, F., ETTER, E., DIXON, L. &ROGER, F., 2007. African swine fever virus in soft ticks, Senegal. Emerging Infectious Diseases , 13(12), 1928-1931.
- VIG ÁRIO, J. D., CASTRO PORTUGAL, F. L., FESTAS, M. B. &VASCO, S. G., 1983. The present state of African swine fever in Portugal. In: WILKINSON, P. J., (ed.). African Swine Fever , 11-16.EUR 8466 EN. Commission of the European Communities.
- VILLEDA, C. J., WILLIAMS, S. M., WILKINSON, P. J. &VI ÑUELA, E., 1993. Consumption coagulopathy associated with shock in acute African swine fever. Archives of Virology, 133, 467-475.
- VILLEDA, C. J., WILLIAMS, S. M., WILKINSON, P. J. &VI ÑUELA, E., 1993. Haemostatic abnormalities in African swine fever. A comparison of two virus strains of different virulence (Dominican Republic ‘78 and Malta ‘78). Archives of Virology , 130, 71-83.
- VI ÑUELA, E., 1985. African swine fever virus. Current Topics in Microbiology and Immunology, 116, 151-170.
- WAHIS., O., 2005-2019. Immediate notifications and follow-ups. (http://www.oie.int/wahis_2/public/wahid.php/Diseaseinformation/Immsummary ) .
- WALKER, J., 1933. East African swine fever. London: Bailli ère, Tindall and Cox.
- WALTON, G. A., 1964. The Ornithodoros ‘moubata ’ group of ticks in Africa. Control problems and indications. Journal of Medical Entomology , 1, 53 –64.
- WANG, T., SUN, Y. &QIU, H. J., 2018. African swine fever: an unprecedented disaster and challenge to China. Infectious Diseases of Poverty , 7, 111.
- WARDLEY, R. C., 1982. Effect of African swine fever on lymphocyte mitogenesis. Immunology , 46, 215-220.
- WARDLEY, R. C., ABU ELZEIN, E. M. E., CROWTHER, J. R. &WILKINSON, P. J., 1979. A solid-phase enzyme-linked immunosorbent assay for the detection of African swine fever virus antigen and antibody. Journal of Hygiene, Cambridge , 83, 363-369.
- WARDLEY, R. C. &WILKINSON, P. J., 1977. The association of African swine fever virus with blood components of infected pigs. Archives of Virology, 55, 327-334.
- WELFARE)., E. A. P. E. P. O. A. H. A., 2015. Scientific opinion on African swine fever. EFSA Journal 13(7), 4163.
- WEN, X., HE, X., ZHANG, X., ZHANG, X., LIU, L., GUAN, Y., ZHANG, Y. &BU, Z., 2019. Genome sequences derived from pig and dried blood pig feed samples provide important insights into the transmission of African swine fever virus in China in 2018. Emerging Microbes and Infection , 8(1), 303-306.
- WENSVOORT, G., TERPSTRA, C. &BLOEMRAAD, M., 1988. Detection of antibodies against African swine fever virus using infected monolayers and monoclonal antibodies. Veterinary Record , 122, 536-539.
- WESLEY, R. D., QUINTERO, J. C. &MEBUS, C. A., 1984. Extraction of viral DNA from erythrocytes of swine with acute African swine fever. American Journal of Veterinary Research, 45, 1127-1131.
- WESLEY, R. D. &TUTHILL, A. E., 1984. Genome relatedness among African swine fever virus field isolates by restriction endonuclease analysis. Preventive Veterinary Medicine , 2, 53-62
- WHITTALL, J. T. D. &PARKHOUSE, R. M. E., 1997. Changes in swine macrophage phenotype after infection with African swine fever virus: Cytokine production and responsiveness to interferon-gamma and lipopolysaccharide. Immunology , 91, 444-449.
- WILKINSON, P. J., 1984. The persistence of African swine fever in Africa and the Mediterranean. Preventive Veterinary Medicine, 2, 71-82.
- WILKINSON , P. J., 1986. Epidemiology of African swine fever. Revue Scientifiique et Technique de l ’Office International des Épizooties , 5, 487-493
- WILKINSON, P. J., 1989. African swine fever virus. In: PENSAERT, M. C., (ed.). Virus Infections of Porcines. Amsterdam: Elsevier.
- WILKINSON, P. J. &DONALDSON, A. I., 1977. Transmission studies with African swine fever virus. The early distribution of virus in pigs infected by airborne virus. Journal of Comparative Pathology, 87, 497-501.
- WILKINSON, P. J., DONALDSON, A. I., GREIG, A. &BRUCE, W., 1977. Transmission studies with African swine fever virus. Infection of pigs by airborne virus. Journal of Comparative Pathology, 87, 487-495.
- WILKINSON, P. J., PEGRAM, R. G., BERRY, B. D., LEMCHE, J. &SCHELS, H. F., 1988. The distribution of African swine fever virus isolated from Ornithodoros moubata in Zambia. Epidemiology and Infection , 101, 547-564.
- WILKINSON, P. J. &WARDLEY, R. C., 1978. The replication of ASFV in endothelial cells. British Veterinary Journal, 134, 280-282.
- WILKINSON, P. J., WARDLEY, R. C. &WILLIAMS, S. M., 1981. African swine fever virus (Malta/78) in pigs. Journal of Comparative Pathology , 91, 277-284.
- WILKINSON, P. J., WARDLEY, R. C. &WILLIAMS, S. M., 1983. Studies in pigs infected with African swine fever virus (Malta/78). In: WILKINSON, P. J., (ed.). African swine fever. EUR. 8466 EN. Commission of the European Communities.
- WILSON, R. T. &SWAI, E. S., 2014. Pig production in Tanzania: A critical review. Tropicultura , 32(1), 46-53
- WORMINGTON, J. D., GOLNAR, A., POH, K. C., KADING, R. C., MARTIN, E., HAMER, S. A. &HAMER, G. L., 2019. Risk of African swine fever virus sylvatic establishment and spillover to domestic swine in the United States. Vector-Borne and Zoonotic Diseases . In Press. e-pub ahead of print, doi: 10.1089/vbz.2018.2386.
- W ÓZNIAKOWSKI, G., KOZAK, E., KOWALCZYK, A., LYJAK, M., POMORSKA-M ÓL, M., NIEMCZUK, K. &PEJSAK, Z., 2016. Current status of African swine fever virus in a population of wild boar in eastern Poland (2014-2015). Archives of Virology . 161, 189-195.
- YA ÑEZ, R. J., RODRIGUEZ, J. M., NOGAL, M. L., YUSTE, L., ENRIQUEZ, C., RODRIGUEZ, H. F. &VI ÑUELA, E., 1995. Analysis of the complete nucleotide sequence of African swine fever virus. Virology, 208, 249-278.
- ZAKARYAN, H., KARALOVA, E., VOSKANYAN, H., TER-POGOSSYAN, Z., NERSISYAN, N., HAKOBYAN, A., SAROYAN, D. &KARALYAN, Z., 2014. Evaluation of hemostaseological status of pigs experimentally infected with African swine fever virus. Veterinary Microbiology , 174(1-2), 223-228.
- ZHOU, X., LI, N., LUO, Y., MIAO, F., CHEN, T., ZHANG, S., CAO, P., LI, X., TIAN, K., QIU, H. J. &HU, R., 2018. Emergence of African swine fever in China, 2018. Transboundary and Emerging Diseases , 65(6), 1482-1484.
- ZSAK, L., BORCA, M. V., RISATTI, G. R., ZSAK, A., FRENCH, R. A., LU, Z., KUTISH, G. F., NEILAN, J. G., CALLAHAN, J. D., NELSON, W. M. &ROCK, D. L., 2005. Preclinical diagnosis of African swine fever in contact-exposed swine by a real-time PCR assay. Journal of Clinical Microbiology , 43(1), 112-119.
- ZSAK, L. &NEILAN, J. G., 2002. Regulation of apoptosis in African swine fever virus-infected macrophages. Scientific World Journal , 2, 1186-1195.
- ZSAK, L., ONISK, D. V., AFONSO, C. L. &ROCK, D. L., 1993. Virulent African swine fever virus isolates are neutralized by swine immune serum and by monoclonal antibodies recognizing a 72-kDA viral protein. Virology, 196, 596-602.